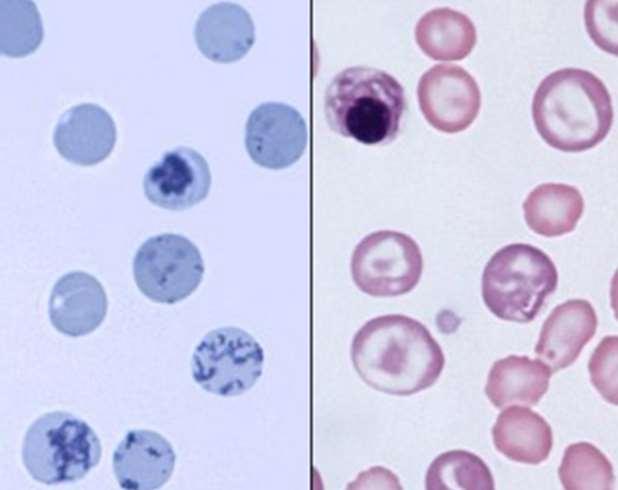
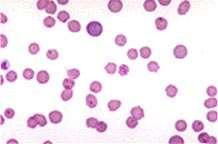
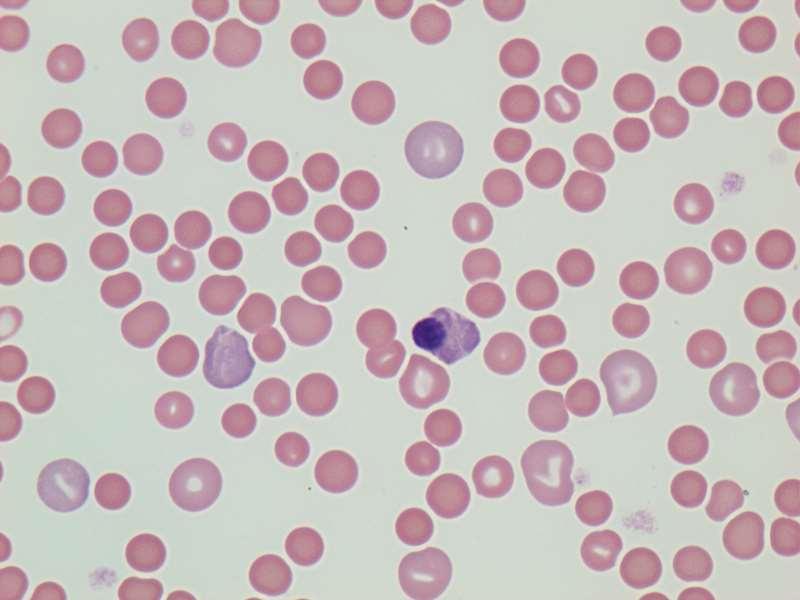
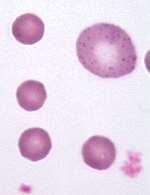
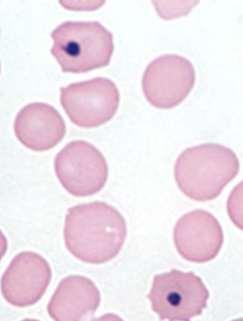
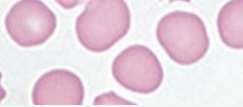
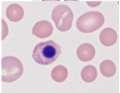
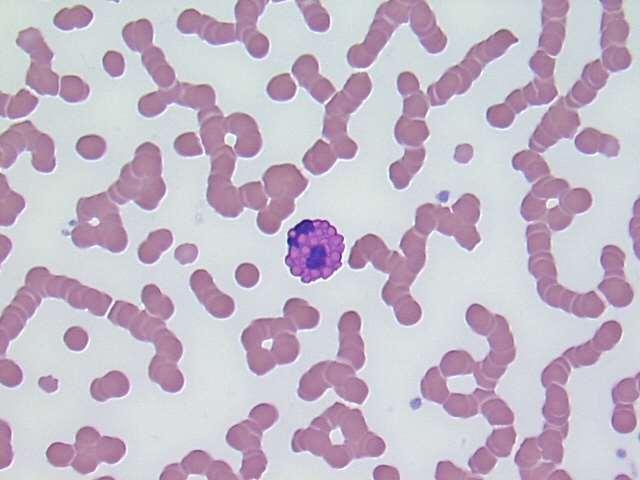
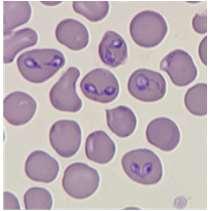
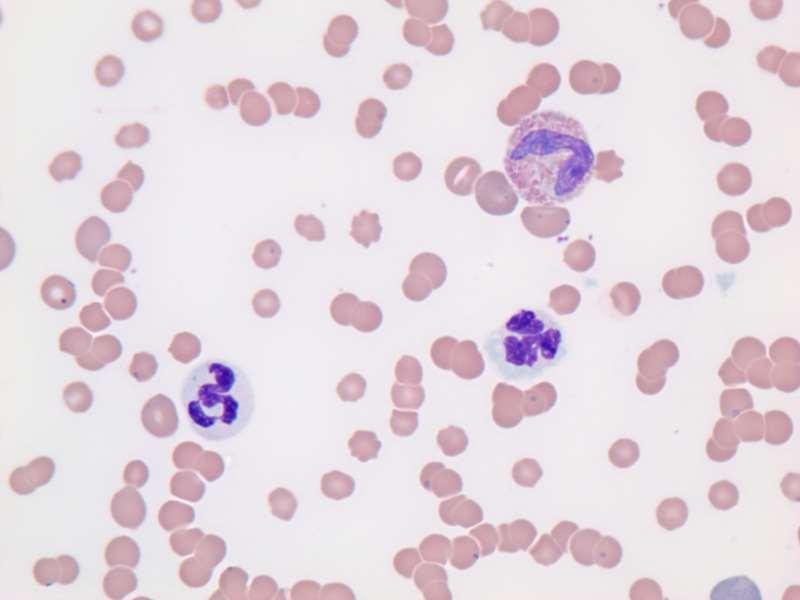
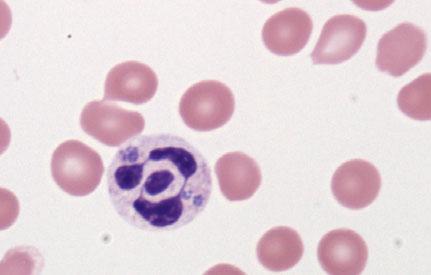

Vet Voyage
Sailing the Seas of Veterinary Excellence

Missouri Veterinary Medical Association Annual Convention
January 30 - February 2, 2025
Holiday Inn Executive Center
2200 I-70 Drive Southwest Columbia, Mo. 65203
Proceedings Book

![]()
Sailing the Seas of Veterinary Excellence

Missouri Veterinary Medical Association Annual Convention
January 30 - February 2, 2025
Holiday Inn Executive Center
2200 I-70 Drive Southwest Columbia, Mo. 65203
Proceedings Book

Note: Abstracts received as of 2/11/25.
Philip Bosse, DVM
GI Parasitology – Utilizing Keyscreen® GI Parasite PCR for Enhanced Diagnostic Screening and Improved Standards of Care: Giardia and “One Health”………………………………….…7
Preventive Medicine: Promoting the Health of Our Veterinary Patients Proactively……………13
Karen Campbell-Motsinger, DVM
The Many Faces of Dermatology………………………….…………………………………….19
Leah Cohn, DVM
Teaching an Old Dog about New Drugs……………………….………………………..………55 Things Change: “Rights” turn to “Wrongs”
Clifford Shipley, DVM
Robert Van Saun, DVM
Kerry Karaffa, PhD
Client Characteristics and the Effectiveness of Embedded Mental Health Counseling Services. ……………………………………………………………………………………….195
Philip Johnson, BVSc, MS
SGLT2 Inhibitors for Treating Equine Metabolic Syndrome 201
Marie Kerl, DVM, MPH, MBA, DACVIM (SAIM), DACVECC
Medical Errors and Patient Safety Concerns…………………………………………………..207
Hannah R. Leventhal, DVM, MS, DACVIM
Respiratory Refresher: Diagnostics for common respiratory conditions focusing on the BAL and TTW………………………………………………………………………………………..217
The Equine Airway in an emergency setting: Focusing on tracheotomy……………………....221
Hannah R. Leventhal, DVM, MS, DACVIM
Live Equine Blind Bronchoalveolar Lavage Procedure 225
Philip
Bosse, DVM
GIParasitology–UtilizingKeyscreen®GIParasitePCRfor EnhancedDiagnosticScreeningandImprovedStandardsof Care:Giardiaand“OneHealth”
CE Title: "GI Parasitology – Utilizing Keyscreen® GI Parasite PCR for Enhanced Diagnostic Screening and Improved Standards of Care: Giardia and “One Health””
Description: This CE presentation is a broad review of parasites and parasitology in companion animals. We will discuss challenges of current practices in parasitology and an update in available methodologies of detection. Additional focus is paid to Giardia duodenalis and considerations for "One Health" in treatment plan development.
Notes:
Current practices in GI parasite control:
- Screening juvenile pets, adults, at-risk, symptomatic
o The Companion Animal Parasite Council (CAPC) recommendation of frequency for wellness is 4 times yearly for puppies and kittens <1yr of age and 2 times yearly for all dogs and cats >1yr of age.
- Routine Deworming
- Preventive medicine programs (i.e. monthly parasite controls)
Limitations of these practices:
- Compliance in adhering to preventive medications schedules.
-Limitations of some newer meds (injectable milbemycin).
- Unrecognized drug resistance.
- Underserved communities and access to care
How are we doing:
- One study performed by Jason Drak shows an increasing prevalence of roundworms and hookworms, with a mild decrease in whipworms, over a 7 year period with 39 million samples included.
- The DoGPaRCS study shows presence of a nematodes and giardia present in 20% of samples and >85% of parks having parasite contamination. Over 3000 samples collected from 288 dog parks across the United States.
- Geohelminths in urban green spaces, city parks and beaches (not dog parks) in Connecticut were noted at 14.4%
Methods for testing:
-Ova and Parasite floatation,
o pioneered in early 1900s (sample size, stability requirements: 2.5g feces, 72hours)
o Modification from passive to adding centrifugation has improved fecal egg recovery but remains relatively insensitive and human subjectivity can provide additional challenges to accuracy.
- Addition of antigen testing to augment OP for improved sensitivity
o Limited number of antigens commercially available, must be used in conjunction with adequate screening methodology.
- PCR represents a breakthrough that improves sensitivity, removes subjectivity, and provides valuable information beyond the ability of other methodologies.
Keyscreen GI Parasite PCR Panel
- 20 parasites of the dog and cat.
- 6 classes (hookworm, roundworm, whipworm, tapeworm, giardia, coccidia, and additional protozoa not commonly identified by other methodologies) with multiple types in each
-Smaller sample size requirement (0.15g) and longer sample stability (10 days with refrigeration) as compared to OP floatation.
- Recognized by CAPC as a stand-alone screening tool for parasites, not needing to be paired with OP floatation.
- Uniquely identifies a genetic marker of benzimidazole-resistance in hookworms, providing invaluable information at the time of diagnosis.
-Uniquely identifies assemblages of Giardia duodenalis, namely A and B, that have the potential to affect humans.
- Method Comparison study (941 samples, OP w/ centrifugation vs Keyscreen; Keyscreen identified significantly more parasites than did the OP methodology Most notably, 243 giardia cases we found by Keyscreen and only 71 by floatation.
A Focus on Giardia and One Health
-“One Health is the idea that the health of people is connected to the health of animals and our shared environment.”
- Giardia was once thought to be host specific, however with the advent of PCR testing it is now recognized that while there is a “host preference” many animals can carry multiple assemblages of giardia.
-Additionally, Giardia labmlia, and Giardia intestinalis have been reclassified to Giardia duodenalis assemblages A and B. These assemblages, while not considered the primary infector, can be carried by dogs and cats. One study shows, in the United States, < 4% of dogs giardiasis cases and approximately 19% of cat giardiasis cases are of the A or B assemblage, and therefore considered to have zoonotic potential.
-Many parasitologists including those on the COMPANION ANIMAL PARASITE COUNCIL board, are advocating a paradigm shift in the veterinary approach to giardiasis in the small animal. It is no longer recommended to treat based only on the presence of giardia in a stool sample In many animals, giardia does not appear to cause harm or even symptoms. Therefore, veterinarians are now encouraged to consider if the animal is showing symptoms, and/or if that giardia is known to have zoonotic potential as they decide upon appropriate next steps in a case.
- Addittionally, treatment goals are encouraged to shift from complete clearance of the organism, to resolution of symptoms and reduction of environmental contamination.
- At this time, zinc sulfate solution floatation with centrifugation performed 24-48 hours after treatment is the recommended -re-testing option. This is in-line with the CAPC guidelines for giardiasis, as well informs the clinician of successful treatment, with regard to reduced environmental contamination.
- In cases where symptoms are present post treatment for giardia, but there is no evidence of active shed of the parasite, alternative causes for the symptoms and chronic enteropathy need to be considered and explored.
- Antech has developed a clinical algorithm, with the direct involvement of CAPC, to assist veterinarians in the decision making necessary with giardiasis of the dog and cat.
References:
AAHA 2021 Working, assistance, and therapy dog guidelines. Accessed December 2022: https://www.aaha.org/aaha-guidelines/2021-aaha-working-assistance-and-therapy- dogguidelines/home/
AKC Fact sheets: Hookworms and Giardia: https://akcchf.org/canine-health/top -healthconcerns/current-topics-in-infectious- disease
Bilbrough G. Promoting preventive care protocols, AAHA, 2018.
Bouzid M, et al, 2015. Prevalence of Giardia infection in dogs and cats, a systematic review and meta-analysis of prevalence studies from stool samples Vet Parasit. 207:181–202.
Canadian Parasitology Expert Panel (CPEP) Guidelines for the Management of Parasites in dogs and cats, 2019. As accessed January 2025: https://research-groups.usask.ca/cpep/index.php#Protocol
Canine (2019) and Feline (2021) Life stage Guidelines, AAHA, AAHA/AAFP.
Companion Animal Parasite Council (CAPC) Intestinal Parasite Guidelines. As accessed January 2025: https://capcvet.org/guidelines/
Drake, J., Carey, T. Seasonality and changing prevalence of common canine gastrointestinal nematodes in the USA. Parasites Vectors 12, 430 (2019). doi: 10.1186/s13071-019-3701-7
Eppler ME, et al, 2022. Survey of U.S. based veterinarians’ knowledge, perceptions and practices about canine giardiasis. Vet Parasit. 34:1-7.
Frey E, et al. 2022 AAFP/AAHA Antimicrobial Stewardship Guidelines, Accessed September 2022: https://www.aaha.org/aaha-guidelines/2022-aafpaaha-antimicrobial-stewardshipguidelines/home/
Leutenegger CM, 2022. How molecular testing is reshaping the way parasites can be detected. Vet Pract News. March.
Leutenegger, C.M., Lozoya, C.E., Tereski, J. et al. Comparative study of a broad qPCR panel and centrifugal flotation for detection of gastrointestinal parasites in fecal samples from dogs and cats in the United States. Parasites Vectors 16, 288 (2023). https://doi.org/10.1186/s13071-023-05904-z
Marsh AE, et al, 2015. Legal implications of zoonotic disease transmission for veterinary practices. Vet Clin North Am Small Anim Pract. 2015 Mar;45(2):393-408.
Stafford K, Kollasch TM, Duncan KT, Horr S, Goddu T, Heinz-Loomer C, Rumschlag AJ, Ryan WG, Sweet S, Little SE. Detection of gastrointestinal parasitism at recreational canine sites in the USA: the DOGPARCS study. Parasit Vectors. 2020 Jun 1;13(1):275. doi: 10.1186/s13071-020-04147-6.
Stull, et al. Infectious disease in dogs in group setting. 2016. As accessed September 2022: https://vet.osu.edu/sites/vet.osu.edu/files/documents/preventivemedicine/Infectious%20Disease%20in%20Dogs%20Final.pdf
Sweet S, et al, 2021.A 3-year retrospective analysis of canine intestinal parasites: fecal testing positivity by age, U.S. geographical region and reason for veterinary visit. Parasites Vectors 14, 173.
Traversa, D., Frangipane di Regalbono, A., Di Cesare, A. et al. Environmental contamination by canine geohelminths. Parasites Vectors 7, 67 (2014). https://doi.org/10.1186/1756-3305-7-67
Uehlinger F, et al, 2013. Zoonotic potential of Giardia duodenalis and Cryptosporidium spp. and prevalence of intestinal parasites in young dogs from different populations on Prince Edward Island, Canada. Vet Parasit. 196:509-514.
Weese JS, Evason ME. 2020. A Colour Handbook, Infectious Diseases of the Dog and Cat. CRC Press.
World Health Organization (WHO), Accessed September 2022: https://www.who.int/en/newsroom/fact-sheets/detail/antimicrobial-resistance
Philip Bosse, DVM
PreventiveMedicine:PromotingtheHealthofour VeterinaryPatientsProactively
Description: This CE hour will consist of a review of recommended preventative medical practices and look into the ‘why’ behind the recommendation. We will discuss the benefits for our patients as well as population health and impact on business. Finally, we will dive into some of the updates Antech can provide to aid the veterinary practitioner in being proactive for their well patients.
Proceedings:
Pets mean more to humans than ever before. They have grown in our hearts and moved into our homes. 95% of pet owners consider their pets to be like family. The reasons for this are plenty, but to name a few: pets bring joy and happiness, for some they bring a sense of purpose. Additionally, pets help inspire people to be more physically active and help to fight feelings of loneliness and isolation. Noting all the pets provide their humans it should be no surprise that in 2019 one study showed pet owners spent a whopping $31.4 billion on pets’ medical care. The importance of pets is translating into an expectation for better medical care by their owners.
Reactive medicine is the approach of responding to a perceived problem indicated by symptoms or behavioral changes in the patient (i.e. the coughing animal) Taking the reactive care approach alone leaves much left undiscovered in the, presumed, “well patient”. Transitioning more towards a proactive care model, in wellness, allows a clinician to uncover illness while it Is smaller, and likely provide greater success in management and treatment. The proactive approach is monitoring disease to ensure appropriate management (i.e. blood glucose curves rather than waiting for crisis and DKA). It is also seeking confirmation of health through diagnostics when history and physical exam are unremarkable.
All too often, wellness is assumed through history given by well-intentioned, but untrained, pet owners and a cursory physical exam. However, according to one study done by AAHA, 15% of adult (dogs 3-6 yrs, cats 2-8 yrs, 21% of senior (dogs 7-10 yrs, cats 9-13 yrs), and 42% of geriatric (dogs 11+ years, cats 14+ years) patients had some abnormality noted during a annual wellness exam that included diagnostics that requires a change in recommendation from their veterinarian. The list of abnormalities for dogs includes hepatic, renal, dental disease, cardiac, orthopedic, and dermatologic changes. For cats, the most common abnormalities noted we cardiac, renal, and dental disease. These are changes that require a trained veterinarian to uncover, and it starts with recommending diagnostics at wellness exams.
That recommendation is powerful. For many pet owners, however an explanation of value is helpful. The value in going beyond the physical exam and passive observation to look into organ function; defining what is “normal” for this individual pet rather than relying on broad ranging reference intervals; and proving wellness, bringing a peace of mind to all involved. A poignant example is having a pet with HCT of 55% in wellness, present with lethargy and a HCT of 39%. Both values are within accepted reference intervals, but since we know what is normal for this pet, we have an invaluable head start on making a diagnosis. The culture of utilizing diagnostics in wellness is further supported when multiple voices in the clinic share the same message. Engaging support staff to repeat the recommendation and it’s value can make immense impacts on customer
compliance. Additionally, it has been shown that timely follow-up from the veterinarian can improve compliance by as much as 40%. I suggest that improvement in compliance can apply to following instructions for treatment, to attending recheck visits, to saying yes for diagnostics in wellness.
So the question is begged, “what to include in wellness testing?” with answer being based on lifestage, life-style, travel, and geographical considerations. All results should be interpreted with relation to history, physical examination and any clinical signs present. For most dogs and cats, the “minimum database” consisting of a complete blood count (CBC), serum biochemistry (chem), and urinalysis (UA) is recommended as an appropriate starting point. Additional consideration is paid to the thoroughness of the chem panel indicated by the case, as well as not omitting a urinalysis for all the value it can provide, including insight to impact of chronic medications, metabolic diseases, and even neoplasia. Beyond the minimum database, additional considerations include thyroid testing in senior patients, vector-borne disease screening (including exposure to diseases spread by tick, not simply heartworm testing), fecal parasite screening (advocating for the value of Antech’s Keyscreen Parasite PCR in wellness), nucleosome testing (NuQ, a novel marker of increased cellular turn- over can indicate emerging disease prior to symptoms being noted, especially in the case of certain cancers), feline retroviral testing, and imaging (with available teleradiology support). Again,
In closing, wellness testing is recommended for the benefit of both pet and veterinarian as we see improved outcomes, indicating improved care through medical discovery as well as the veterinary practice as a business. Through leveraging science, data, and technology, better care and partnership is built with Antech.
References:
www.petlifetoday.com/state- of-pet-healthcare/
www.todaysveterinarybusiness.com/veterinary-market-2020-appa/ www.ksat.com/news/local/2020/02/28/appa-americans-spent-957-billion-on-their-pets-in-2019/
Willems A, Paepe D, Marynissen S, Smets P, Van de Maele I, Picavet P, Duchateau L, Daminet S. Results of Screening of Apparently Healthy Senior and Geriatric Dogs. J Vet Intern Med. 2017 Jan;31(1):81-92. doi: 10.1111/jvim.14587. Epub 2016 Oct 17. PMID: 27747924; PMCID: PMC5259637.
Burns, Katie, (2018). Pet ownership stable, veterinary care variable Retrieved from https://www.avma.org/javma-news/2019-01-15/pet- ownership -stable-veterinary-care-variable Lue, T. W., Pantenburg, D. P., & Crawford, P. M. (2008). Impact of the owner-pet and clientveterinarian bond on the care that pets receive. Journal of the American Veterinary Medical Association, 232(4), 531-540. Retrieved Jan 14, 2025, from https://doi.org/10.2460/javma.232.4.531 www.capcvet.org www.heartwormsociety.org
www.aaha.org/globalassets/05-pet-health- resources/promoting_preventive_care_protocols.pdf
Littman MP, Gerber B, Goldstein RE, Labato MA, Lappin MR, Moore GE. ACVIM consensus update on Lyme borreliosis in dogs and cats. J Vet Intern Med 2018; 32: 887–903.
A brief guide to emerging infectious diseases and zoonoses. Referenced at https://www.who.int/publications/i/item/9789290224587 catvets.com/guidelines/client-brochures
Emilio DeBess, DVM, MPH Oregon State Public Health Veterinarian, Past President of CAPC
Stafford K, Kollasch TM, Duncan KT, Horr S, Goddu T, Heinz-Loomer C, Rumschlag AJ, Ryan WG, Sweet S, Little SE. Detection of gastrointestinal parasitism at recreational canine sites in the USA: the DOGPARCS study. Parasit Vectors. 2020 Jun 1;13(1):275. doi: 10.1186/s13071-020-04147-6.
DVM
KarenL.Campbell,DVM,MS,DACVIM,DACVD ProfessorEmerita,UniversityofIllinois
AdjunctClinicalProfessorofVeterinaryDermatology,UniversityofMissouri VeterinaryDermatologist,MissouriVeterinaryDermatologyCenter Wentzville,Missouri



Whatareourdiagnosticclues?

•History:signalment,presenceor absenceofpruritus
•Lesiondistribution
•Areprimarylesionspresent?(lookfor papules,pustules,vesicles)
Whatarecrustsandwhatcausesthem?
•Crusts=accumulationsofserum, leukocytes,keratinocytesand sometimesbloodontheskin surface
•Crustsaresecondarytodisruption ofepidermaland/ordermal integrity
•Trauma
•Rupturedpustulesorvesicles
•Infiltrativediseases
•Necrosis

•Historyandphysicalexamination

•R/Oectoparasites–PE,skinscrapings,trichograms,IgEtesting,treatment trials
•R/Ofoodallergy–restrictivediettrial
•Cytology–lookingforinfections,acantholytickeratinocytes,neoplastic cells
•Wood’slight,dermatophyteculture,PCRtestingforfungi
•PCRtestingforvirusesandotherpathogens
•Skinbiopsies
•Otherlaboratorytests(bloodwork,radiographs,ultrasound)


SARCOPTES
History:contactwithotherdogs,areaswherefoxesorcoyotesmaybepresent
Symptoms:pruritus,hairloss,crusts
Lesiondistribution:earpinnae,face,legs,ventrum
Clues:positivepinnal-pedalreflex
Diagnostictests:skinscrapings,fecalflotation,IgEtesting,treatmenttrial
DEMODEX
History:maybejuvenileoradult-onset,anyfactorsimpairingimmunesystem?
Symptoms:folliculitis,hairloss,crusting,secondarypyoderma/cellulitis
Lesions:maybelocalizedorgeneralized,faceoftenfirstareaaffected Diagnostictests:skinscrapingsand/ortrichograms




MOSQUITOBITEHYPERSENSITIVITY
History:seasonalwithaccesstoareaswithmosquitoes
Lesions:crustedpapulesonnose,ears,sometimesfeet
Diagnosis:eosinophilsoncytology;improvewhennomosquitoes,IDT
FELINEDEMODICOSIS
History:usuallysecondarytoimmunosuppression
Lesions:folliculitis(D.cati)
Diagnosis:skinscrapingortrichogramfindingmites
Ectoparasitescausingfacialcrusting


OTODECTES
History:contactwithothercats
Lesions:mostcommondarkceruminoiusdebrisinearcanal,mayhavecrusted papulesonpinnaandhead
Diagnosis:seemiteswithotoscopeorviamicroscopy
NOTOEDRES
History:contactwithothercats,pruritic
Lesions:scalesandcrustsonears,face,head Diagnosis:superficialskinscrapings



Solardermatosis
•History:lightcoloredhaircoat
•Lesions:erythema,alopecia, ulcers,crusts
•Actinicdermatitiscanprogress intosquamouscellcarcinomas

EosinophilicGranulomaComplex–Feline FacialCrusts

Eosinophilicplaquesmayformlargecrustedlesionsontheface
•Theseareamanifestationofallergies–food,environmentalor parasitic
•Cytology:eosinophils,mastcells,mayhavesecondarybacterialand/or yeastinfections
SkinscrapingstoR/Omites,foodtrialtoR/Ofoodallergies,maywant tobiopsytoR/Oneoplasiaandconfirmdiagnosis
Eosinophilicfolliculitisandfurunculosisfacialcrusting



•History:acuteonsetofpainfullesions,may beassociatedwithinsectbites/stings
•Lesions:papules,pustules,crustsonbridge ofnose
•Diagnosis:ruleoutdemodex, dermatophytes,immune-mediateddiseases
•Cytology:usuallylarge#sofeosinophils


•Facialpruritusresultinginexcoriations,crustingand secondaryskininfectionsisoneofthemostcommon clinicalsignsofallergiesindogsandcats Allergiescanbetoallergensinfoodsandenvironmental substances(pollens,molds,microscopicmitesandother insects) Cannotdifferentialfoodandenvironmentalallergiesbased oncutaneoussigns–symptomsoverlap!
•Ruleoutfoodallergiesviarestrictivediettrials–8weeks duration
•Atopicdermatitisisdiagnosedbasedonhistory,clinical signsandrulingoutothercausesofpruritus(foodallergies, ectoparasites,othercausesofcutaneousinflammation)
•Treatedbyeliminating/minimizingexposureto“offending allergens”(foods),improvingskinhealth,suppressing inflammation,controllingsecondaryinfections,alleviating itchingand/ordesensitization



DERMATOPHYTES
Signalment:terrierdogspredisposedifabletohuntrodents(moles,mice,rabbits,etc.); maybehistoryofrecentexposuretootheranimals
History:hairlossandcrustingusuallystartondistalnose/muzzleandprogressupface
Lesions:mayseebrokenhairs,folliculitis,scalingandcrusting
Diagnosis:Wood’slight~½ofMicrosporumcanisfluoresce;trichogram–hairshave irregularcontour,mayappearfrayed,mayseehyphaeandarthospores;PCRtest-pluck hairsatmarginoflesions;Dermatophyteculture–pluckhairsatmarginoflesions




Infectionscausingfacialcrusting


SPOROTHRIX
History:exposuretoplantsorplantmaterial
Lesions:crustsanddrainingtracts
Diagnosis:organismscanusuallybefoundon cytology
Caution:highlyzoonotic–weargloves
HISTOPLASMA
History:exposuretobirdorbatfeces
Lesions:crustsanddrainingtracts Diagnosis:organismscanusuallybe foundoncytology






CRYPTOCOCCUS
History:organismsfoundinpigeondroppingsandon sometypesofplants(conifertrees)
Lesions:drainingtracts,crustsand/ornodules
Diagnosis:organismscanusuallybefoundoncytology
LEISHMANIA
History:importedfromEuropeortravelinanendemic area(Texas,Florida,California);inUnitedStates Foxhoundsmaybepredisposed Lesions:scalesandcrustsonhead,maybegeneralized andmayhavesystemicsigns(malaise,fever,arthritis, renaldisease,GIdisease)
Diagnosis:mayfindorganismsoncytology,serological tests,PCRtests


Infectionscausingfacialcrusting


HERPESVIRUS
History:oftenhaveupperrespiratorysigns,maybepruritic
Lesions:oftenocularlesions,crusting,erythema,ulcerations
Diagnosis:PCRtesting,findingviralinclusionsonbiopsies
CALICIVIRUS
History:oftenhaveupperrespiratorysigns,maybepruritic
Lesions:crusting,erythema,ulcerations(checkmouth)
Diagnosis:PCRtesting,virusisolation,antibodytesting
Infectionscausingfacialcrusting


Superficialspreadingpyoderma
•History:hairloss,erythema, hyperpigmentationifchronic
•Diagnosis:cytology–maybemixed populationofbacteriaandwbc’s;resolves withantimicrobialtreatment;evaluatefor underlyingdemodex,concurrentfungal infections,allergies,endocrineorimmunemediateddiseases


Mucocutaneouspyoderma
•History:oftenhavehalitosis
•Lesions:erythema,crusting, ulcerationaroundlips
•Diagnosis:cytology–maybe mixedpopulationofbacteria andwbc’s;resolveswith antimicrobialtreatment
Immune-mediateddiseasescausingfacialcrusting




Pemphigusfoliaceous History:canaffectanyagedogandcat Lesions:papules,pustules,crusts–headisusuallyfirstsitetobeaffected,often alsoinvolvesfootpads(dogs)andclawbed(cats),lesionsmaybecomegeneralized Diagnosis:findingacantholytickeratinocytesoncytologyishighlysuggestive, Skinbiopsiesfordefinitivediagnosis(pustulesandcrusts)–subcornealpustules withacantholytickeratinocytes


Immune-mediateddiseasescausingfacialcrusting

Pemphiguserythematosus



History:mostcommonindolichocephalicbreedsofdogs
Lesions:pustules,crusts,hairlossonnose+/-periocular,lossofnasalpigmentation,ulceration
Haveantibodiesagainstdesmosomalproteinsandnuclearantigens
Diagnosis:acantholytickeratinocytes,subcornealpustulesanddermoepidermalvacuolardegeneration,ANA+
Immune-mediateddiseasescausingfacialcrusting




DiscoidLupusErythematosus
History:morecommonindogsthatspendtimeoutside(solardamage)
Lesions:erythema,scaling,ulceration,crusting,depigmentation,lossofcobblestonetextureofnasalplanum
Diagnosis:biopsiesshowingapoptosisofbasalkeratinocytes,dermal-epidermalclefts(noacantholysis)
Immune-mediateddiseasescausingfacialcrusting

Vasculitis


History:hasanimalbeenvaccinatedwithinthepast2-3months?Anyhistoryofticks?
Lesions:hairloss,scalingcrustingofearmargins,mayloosechunksofeartips/margins Diagnosis:ruleouttick-borneinfections(Ehrlichia,RMSF,anaplasmosis),ANA,biopsy

Immune-mediateddiseasescausingfacialcrusting


Pemphigusvulgaris
History:maybefebrile,anorexic

Lesions:pustules,crusts,ulcerations–usuallyinvolveoralcavity
Haveantibodiesagainstdesmosomalproteins
Diagnosis:acantholytickeratinocytes,suprabasilarpustules


Immune-mediateddiseasescausingfacialcrusting

UveodermatologicSyndrome




History:Akitaandother“articbreeds”predisposed,affectsMANYotherbreeds,historyof photophobiaoftenprecedeslossofpigmentationandscaling/crustingstartingaroundeyes andmouth
Diagnosis:ruleoutothercausesofuveitis,skinbiopsies-granulomatouslichenoid dermatitis




Inflammatorydiseasescausingfacialcrusting



JUVENILECELLULITIS
History:acutefacialswelling andinflammation
Lesions:papules,pustules, crusts,submandibular lymphadenopathy
Diagnosis:clinicalhistoryand PE;skinscrapingstoruleout demodex;cytology,culture;FNA oflymphnodes
Hereditarydiseasescausingfacialcrusting

Dermatomyositis




History:mostcommoninColliesandShetlandSheepdogs,lesionsmaystartearlyinlife,maywaxandwane;may havedysphagia(“dirtywaterbowls”),mayhave“high-stepping”gait,mayhavemuscleatrophyofheadandlimbs, mayhavemegaesophagusanddevelopaspirationpneumonia
Lesions:hairloss,scalingandcrustingonbridgeofnose,ears,tipoftail
Diagnosis:ruleoutotherdiseases,biopsiesofaffectedskinandmuscles(skin–vacuolarchangeinbasalcells, follicularatrophy,vasculopathy)
Hereditarydiseasescausingfacialcrusting



ExfoliativecutaneouslupuserythematosusinGermanShort-hairedPointers AutosomalrecessivewithsinglenucleotidepolymorphismonChromosome18
History:lesionsstartbetween6moand3yrs,painfulandpruritic
Lesions:scalingstartsonfaceandears–becomesgeneralized Mayimprovewhentreatedwithmycophenolatemofetil
Hereditarydiseasescausingfacialcrusting

Epidermolysisbullosa

•DefectsintheproteinsoftheBMZ
•DystrophicEBhasdefectiveCollagenTypeVII
•JunctionalEBhasdefectiveLaminin5
•Vesiclesandbullaeforminskinatsitesoffriction
Crustsformwhenvesiclesandbullaerupture
Lesionsmaybeseenpresentsoonafterbirth
DiagnosebybiopsyandIHC


Hereditarydiseasescausingfacialcrusting



SEBACEOUSADENITIS
•Predisposedbreeds:Standardpoodles, Goldendoodles,Akita,Vizsla,Samoyed,also seeninotherbreeds Multifocalpatchesofhairloss,scaling, crusting,follicularcasts
•Diagnosis:ruleoutdemodex, dermatophytes,pemphigus–diagnoseon skinbiopsies

Hereditarydiseasescausingfacialcrusting

•FacialdermatosisofPersianand Himalayancats
•Scalingandcrustingaround eyes,muzzle,chin,skinfolds, adherentblackexudate
•Developsecondarybacterialand yeastinfections
•Ruleoutimmune-mediated diseases(cytology,biopsies)
Hereditarydiseasescausingfacialcrusting

LethalAcrodermatitisofBullTerriers
Autosomalrecessivedefectinzincabsorptionand utilization
•Puppiesaresmall,havetroublenursingandeating(high archedhardpalates)
•Scalingandcrustingofears,nose,mouth,feet,legs
•Increasedsusceptibilitytoinfections–mostdieby6 monthsofage
Hereditarydiseasescausingfacialcrusting


ZincDeficiencyType1
•History:affects“articbreeds”–Husky,Malamute, Samoyed
Impairedabsorption/utilizationofzinc
Erythemaandcrustingaroundeyes,muzzle,feet Susceptibletosecondarybacterialskininfections
Diagnose:skinbiopsiesshowmarkedparakeratosisand ruleoutimmune-mediateddiseases
•Improvewhendietissupplementedwithzincand essentialfattyacids,corticosteroidsreduce inflammationandimproveabsorptionofzinc

Metabolicdiseasescausingfacialcrusting



Superficialnecrolyticdermatitis
•History:affecteddogsandcats presentwitherythema,erosionsand crusts–perioral,periocular,feet,legs, perianal,externalgenitalia
•Lesionshaveerythematousbase underandaroundthecrusts
•Underlyingdiseasesincludevacuolar hepatopathy,diabetesmellitus, glucagon-secretingpancreatictumor, hyperadrenocorticism
Neoplastic/ParaneoplasticDiseasescausingfacialcrusting




FelineParaneoplasticAlopecia
•History:oldercats,suddenonsetof malaiseandhairlosswithscaling
•Lesions:hairlossaroundeyes,face, ventralneck,abdomen,legs,shiny skinandfootpads
•Associatedwithpancreatic adenocarcinomaorhepatic carcinoma
•Skinbiopsies:miniaturizationof hairfollicles,oftensecondaryyeast infections
Hereditarydiseasescausingfacialcrusting

Ichthyosis
History:lesionsstartearlyinlife
Lesions:Scaling/crusting,keratinousplugs,erythroderma
Twoforms:epidermolytic(defectsinkeratinformation)and non-epidermolytic(defectsinintercellularlipids,cornified envelopand/ordesmosomes)
Diagnosis:skinbiopsies



Metabolicdiseasescausingfacialcrusting
Superficialnecrolyticdermatitis
•Pathogenesis–hypoaminoacidemia(liverdisease,highlevelsof glucagoncatabolizingproteins);decreasedlevelsofzincand EFAs
•Lowlevelsofaminoacidsresultsinskinnecrosis(vacuolar degenerationofepidermalcells)
•Diagnosis
•Lowlevelsofserumaminoacids Elevatedserumglucagon
•Abdominalultrasound(“swisscheeseliver”)
•Skinbiopsies–parakeratosis,vacuolardegeneration,basalcell hyperplasia


Neoplastic/ParaneoplasticDiseasescausingfacialcrusting



FelineThymomaandThymomalikeDermatosis
History:rapidonsetofscalyskindisease
Lesions:Generalizedscaling,hairloss
Diagnosis:thoracicradiographs;skinbiopsies –apoptotickeratinocyteswithlymphocyte satelitosis;ruleoutinfections,ectoparasites (Cheyletiella)
Neoplastic/ParaneoplasticDiseasescausingfacialcrusting




CutaneousT-cellLymphoma
History:usuallyolderdogsandcats
Lesions:severallesiontypes–“mycosis fungoides”presentswithdepigmentation, erosionsandscaling/crustingof mucocutaneousjunctionsinvolvingnose, mouth,periocular,perianalandaround externalgenitalia;otherspresentwithsevere scalingandcrusting(generalized)andothers presentwithcutaneousplaques,mayhave oneormoreforms
Diagnosis:skinbiopsies(Tcellinfiltrationof epidermis,oftenformingmicroscopicpustules filledwithlymphocytes)
Summary
•Thedifferentialsforfacialcrustingareextensive!
•History,signalmentandthoroughphysicalanddermatological examinationscanprovideclues
•Lookforprimarylesions–papules,pustules,vesicles
•Ruleoutectoparasites,evaluatecytology,treatanyinfectionsandreevaluate,skinbiopsiesareoftenneededfordefinitivediagnosis





Case1:9monthFICollie(60#)
•Chiefcomplaint:hairloss
•Hx:hairlossfirstnoticedabout2 weeksagoontheface,nowhair isstartingtofalloutonthedog’s rump;minimalpruritus



Case1:9monthFICollie(60#)
•Whatareyourdifferentialdiagnoses?
•Whatisyourdiagnosticplan?
Diagnosticresults
•Cytology:neutrophils,2+cocci
•SkinScraping:
Whatrecommendationswill youmaketotheowner?
•Treatmentplan
•Follow-up

Case2:8yrMCGoldenMix


Owner’scomplaintisprogressive Crustingonfacethatseemstobe Spreadingtootherareasofbody
8yrMCGoldenMix
•Lesionsstartedaroundeyesand haveprogressed
•Footpadsandperianalskinalso hyperkeratotic
•Dogspendsmostofdayina fencedbackyardinaruralarea, helikestodigaroundawood pile

•Doyouhaveadditional questionsfortheowner
•WhatareyourDDx?
•WhatisyourPDx?

•Fungalcultureresults
•Trichophytonmentagrophytes
•Whatrecommendationswould youmaketotheowner?






Case3:SevenyearMCDobermanmix
•AdditionalPEfindings
•Temperature103.5F
•HR160/min,RR48/min
•Mildenlargementofsubmandibularandpopliteallymphnodes
•WhatareyourDDX?
•Outlineyourdiagnosticplan
Case3:SevenyearMCDobermanmix
•Whatdoyousee?
•Whatwouldyoudonext?

Case3:Fourweekrecheck



Case4:sixyearFSDSH

WhatareyourDDx? Whatisyourdiagnosticplan?
Case4:six-yearoldFSDSH
•Cytologyresults–whatdo yousee?
•Whatwouldyou recommendnext?

Case5:twoyearoldFSDSH


•Adoptedtwomonthsagofromashelter Erythemaandcrustingaroundeyesextendingalong bridgeofnose Mildpruritus Occasionalsneezing
•WhatareyourDDX?
Whatisyourdiagnosticplan?


FelineRespiratoryPCRpanel +Felineherpesvirus +Mycoplasmafelis
•Whatrecommendationswouldyoumaketotheowner?
reception@missourivetderm.com campbellmotsingerk@missouri.edu 1092WentzvilleParkway Wentzville,MO63385
636-332-5041


KarenL.Campbell,DVM,MS,DACVIM,DACVD ProfessorEmerita,UniversityofIllinois
AdjunctClinicalProfessorofVeterinaryDermatology,UniversityofMissouri VeterinaryDermatologist,MissouriVeterinaryDermatologyCenter Wentzville,Missouri



•OneFootORMultipleFeet
•FootInvolvementOnlyOROtherCutaneousSitesInvolved
•PresenceORAbsenceofMucocutaneous/OralLesions



•ForeignBody
•Trauma
•Neoplasia
•FungalInfection
•BacterialInfection




•Demodicosis(somecases)
•SymmetricOnychomadesis(LupoidOnychodystrophy)
•Plasmacellpododermatitis
•ForeignBody
•Hereditary–AcralMutilationSyndrome
•Viruses(some)
•PemphigusFoliaceous(somecases)



•AutoimmuneDiseases
•EpidermolysisBullosa
•Neoplasia



•Bacteria/Fungalinfectionssecondarytoallergiesorotherdiseases
•Demodicosis
•AutoimmuneDiseases
•Superficialnecrolyticdermatitis
•Neoplasia/Paraneoplasticdisorders


Primary(HereditaryDiseases)causing pododermatitis
•AcralMutilationSyndrome
•Germanshort-hairpointers Englishpointers Otherbreedscanbeaffected
•Sensoryneuropathy GeneticmutationofGDNFgene
•Genetictestingisavailable
•Chewofftoes
•Autosomalrecessive
•Noeffectivetreatment


Breed-associatedfootdisease
•Digitalcornsofgreyhoundsandwhippets
•Mostcommonondigits3&4offrontfeet
•Maycauseseverelameness/pain
•Thoughttobecausedbyrepetitive mechanicaltrauma+damagetodeepdigital flexortendon
•Cornsmaybesurgicallyremovedorfiled downandprotectiveboot,oftenrecur
•Superficialflexordigitaltenotomy(remove sectionofsuperficialdigitalflexortendon)
•Toeamputation


Primary(HereditaryDiseases)causing pododermatitis
•LethalAcrodermatitis
•Defectinabsorption/utilizationofzinc
•Feet–onychodystrophy,splayingoftoes, footpadhyperkeratosis
•AutosomalrecessiveinBullTerriers
•MutationofMLKN1gene available


Primary(HereditaryDiseases)causing pododermatitis
•Epidermolysisbullosa Blisteringandsloughingofskinsubjectedto trauma(footpads,extremities)
•Lesionsoftennoticedwithinfewmonthsof life
•DefectsinproteinsintheBMZ DystrophicEBhasdefectiveTypeVIIcollagen JunctionalEBhasdefectiveLaminin5
•DiagnosticPlan
•Biopsies
•Histopathology
•Immunohistochemistry Electronmicroscopy
•Genetictestingavailable



•Demodexcanis
•Feetcanbeonlysiteinvolvedin somepatients
•Diagnoseusuallymadeviaskin scrapingsortrichogram,biopsymay berequiredinsomechroniccases





Parasiticcausesofpododermatitis
•Peloderastrongyloides
•Nematodelivesindecayingorganic matter
•Invadeshairfolliclesincontactwith organicmatter Diagnoseonskinscrapingsorbiopsy



Allergiesascausesofpododermatitis
•Atopicdermatitis
•Feetareincontactwith environment
•Dogsliketolickfeet
•Contactdermatitis
•Cleaners
•Productsusedinyardsor walkways/driveways



Symmetriclupoidonychodystrophy
•Antigenunknown–lymphocyticinfiltratesin clawfoldseparationof clawfromunderlying tissue
•Geneticfactors
•↑Germanshepherddogs& Rottweilers;manyother breedsaffected
•Usualageatonset:3-8yrs


•Otherparasites
Chiggers Papules–redmites embeddedintoskinoffeet, legs,ventralabdomen
•Animalswalkinginareaswith decayingvegetation
Hookworms
Erythemaandcrustingof feet
•Dogswalkinginareaswhere dogfecesarepresent
•Fecalflotation


Immune-MediatedDisease:FootLesions
•Pemphigusfoliaceous
Dogs
•Hyperkeratosisofpawpads “Rough”surface,mayslough
Cats
•Paronychiaiscommon Hyperkeratosisofclawfold
•Mayfindacantholytic keratinocytesoncytology
•Footpadbiopsiesiflesionsonly onfeet



Symmetriclupoidonychodystrophy
•Clinicalsigns
•Onychomadesis
•Misshapen,brittleclaws
•Painonpalpation
•Diagnosis
•HistoryandPE
•Ruleoutinfections
•BiopsyoramputationofP3




Symmetricalonychomadesis(lupoidonychodystrophy)
•Biopsytor/oSCCandotherDDx(MEN,BPorother immune-mediated)
•AmputateP3orcorebiopsy(RSMueller,VetDermatol 1999;10:55-59)



Symmetriclupoidonychodystrophy
•Management
•Avulseloosenails
•Keepnailstrimmedshort(Dremel)
•Painmanagement
•Omega3fattyacids
•Novelproteindiettrial
•VitaminE
•Doxycline+Niacinamide
•Pentoxiphylline(20mg/kgq8hr)
•mCSA(cyclosporine)5-7mg/kg
•Glucocorticoids



SymmetricLupoidOnychodystrophy


Treatedwithtetracyclineandniacinamide
FelinePlasmaCellPododermatitis




PlasmaCellPododermatitis
•Inflammatorydisease
•Associatedwithelevatedserum globulins
•Underlyingimmune-mediated diseaselikely
•Maybeulceratedandpainful withlickingoffeet

PlasmaCellPododermatitis
•PhysicalExam
•Swellingoffootpads,mayulcerate
•ClinPathFindings
•hypergammaglobulinemia
•lymphocytosis
•neutrophilia
•Diagnosis
•HX,PE,BX
•AlsotestforFeLV,FIV




•Treatment
•Doxycycline
•5mg/kgq12hr;MUSTdrinkoreatafterwards topreventesophagealirritationandstrictures
•Cyclosporine
•7mg/kgdaily
•Tacrolimus0.125%topically
•Glucocorticoids(poorresponseinmost cases)



•Developsecondarytoinflammation
•Ectoparasites Demodex Pelodera
•Others(hookworms,chiggers) Allergies
•Food
•Atopy
•Contact
•Trauma Friction(embeddedhairs)
•Self-induced(allergies,ectoparasites, behavioral) Environmental(grassawns)
•Rupturedhairfollicles
•Comedonesintissuebetweenpawpads
•Frictioncausing“ingrown”hairsbetweentoes

•Diagnosticplan
•Cytology
•Ifrodspresentrecommendculturing Ifrecurrentornon-responsivetoantibiotics cuture
•Skinscrapingsortrichogramfor mites/larvae
•Restrictivediettrialforfoodallergies
•Doeshistoryandothersignsfitatopy?
•Anyexposuretocausticsubstances?
•Arecomedonesorcystspresentin tissuebetweentoesorpawpads?

•Treatmentplan Footsoaks–5minutesdaily
•¼strengthDakin’ssolutionandEpsomsalts(1.5 tablespoonsBleach,1tspbakingsoda,2 tablespoonsEpsomsaltsperquartofwater) Chlorhexidinesolution(2tablespoons/gallon) 4%Chlorhexidinemousseatbedtime
•Oralantibioticscontinuefor1weekafter clinicalresolution(culturehighly recommended)
•PHOVIAmaybehelpful(fluorescentlightand photoactivegeltospeedhealing)
•CO2lasertoablatecomedones/keratinplugs inhairfollicles
•Manageunderlying/predisposingfactors

•Malassezia
•Mostcommonindogswithallergies (food,atopy,contact)
•Dogswithkeratinizationdefectsand immunosuppressivediseasesor treatmentsalsopredisposed
•Diagnoseviacytology
•Treatments
•Topicalantifungals
•Oralantifungals
•Identifyandtreatunderlyingfactors


•Dermatophytes
•Microsporumgypseum
•Trichophytonmentagrophytes
•Microsporumcanis
•Diagnoseviatrichogram,DTM cultureand/orPCRtesting
•Treatwithitraconazoleandtopical antifungals(ketoconazolecream; miconazole+chlorhexidine spray/mouse/soak;limesulfur)




Viralinfectionsofthefeet
•Digitalwarts
•Papillomavirusinfection
•Biopsy+IHCtodetectvirus
•Caninedistemper
•“hardpaddisease”
•Biopsy+IHCtodetectvirus



•Zinc-ResponsiveDermatosis
•TypeI:Interferencewithzincabsorption
•Highcalciumdiet/supplement
•Diethighinphytates(soy,chickpeas,oats, peanuts)
Deficiencysymptomsseeninrapidlygrowing puppies
•TypeII:Breed-AssociatedDefectinZinc AbsorptionorUtilization
“ArticBreeds”:Huskies,Samoyeds, Malamutes,Akitas
•Diagnose–History&finding
•Parakeratosis(cytology,skinbiopsies)
•Lowserumlevelsofzinc


•Underlyingdiseasesinclude
•Vacuolarhepatopathy
•Diabetesmellitus
•Glucogonoma
•Hyperadrenocorticism
•Affecteddogs/catshaveverylow levelsofserumaminoacids
•SNDdiagnosedviaskinbiopsies
•Supportivecare=nutritional supplementation




•Felineparaneoplasticalopecia
•Footpadsareshiny
•Squamouscellcarcinoma
•Clawbedaffected
•Melanoma
•Lung-DigitSyndrome











•Footpadhyperkeratosis
•Plaques/nodules
•Swelling/sloughingofpawpads
•Otherlesionsmayinclude depigmentationandulcerations atmucocutaneousjunctions, severescaling,hairloss, cutaneousplaques









•9yroldMCShihTzu

PresentingComplaint
•Pruritus,alopeciaandcrustingofall4feet


Whatdoyouknow?
•Multiplefeetinvolved
•Pedalinvolvementonly
WhatareyourDDx?
Whatdoyouknow?
WhatareyourDDx?
Differentials
Demodicosis
AllergiesBacterial/Fungal
EndocrineDisease Bacterial/Fungal
AutoimmuneDisease
Whatdoyouwanttoknow?
Whatdoyouwanttoknow?
Durationoflesions/ageofonset
Diseaseprogression
Seasonality?
Treatmentsattemptedand response
Additionalsystemicsigns?
Anypreviousproblems?
•Hasbeenchewinghisfeetsince~5monthsold
•Previoustreatmentshaveincludedantibioticsandcorticosteroids
•Currentmedicationsincludeprednisone5mgq48hrsandmonthly Interceptor
InitialTests
•SkinCytology
•DeepSkinScrapings
SkinScrapings

SkinCytology

•Neutrophilswithintracellularcocci
Interpretation?
Interpretation?
•#1:Pododemodicosis
•WhatType?
Interpretation?
•#1:Pododemodicosis
•WhatType?
•AdultOnset Why? Iatrogenic RelapsedJuvenile Cushing’s Hypothyroidism Diabetes UnderlyingNeoplasia
Interpretation?
•#1:Pododemodicosis
•WhatType?
•AdultOnset Why?
Interpretation
•#2:BacterialInfection
•Whattype?
Interpretation
•#2:BacterialInfection
•Whattype?
•Cocci,likelyS.pseudintermedius Why?
Interpretation
•#2:BacterialInfection
•Whattype?
•Cocci,likelyS.pseudintermedius Why? Likelysecondarytodemodicosis
•Adultonsetpododemodicosiswithsecondarybacterialpyoderma
WhatNow?
•Re-evaluatehistory
•Appropriatetestingformostlikelyprimarycauseof adultonsetdemodicosis
•Serumbiochemistry
•ACTHstimulation
•T4/TSH
•FNAlymphnodes
•Imaging
Treatment
•Whatareyourgoals?
•Howwillyouachievethese?
•IatrogenicAdultOnsetpododemodicosiswithsecondarybacterial pyoderma
Treatment
•3prongedapproachformites:
•#1:Killthebacteria
•#2:Killthemites
•#3:Topicalfollicleflusher
•Alternativetherapyforpruritus
Isthisasuperficialordeepinfection?Howdothetreatmentsofthesediffer?
Killthebacteria
•Superficialpyoderma
•4weeksofCephalexin22mg/kgBID
•Deeppyoderma
•Culture,Abxbasedonculturefor6-8weeks
Killthemites
•Whatareyouroptions?
Killthemites
•Simparicamonthly
•Credelio
•Nexgard
•Bravecto
•Ivermectindaily(workupto0.3mg/kgdaily)
•Whichshampooshave“follicleflushing”activity?
•BenzoylPeroxideoncetotwiceweekly
•EthylLactateoncetotwiceweekly

•Howwillyoumonitor?
Durationoftreatment?
•1month?
•2months?
•4months?
•Until1stnegativeskinscrape?
•Until2ndnegativeskinscrape?
•Indefinitely?


•Scrapesamesiteateachvisit
•Documentfindingsateachsite
LeftRearLiveDead
Adults
Juveniles
Eggs
Fragments
•Howwillyourelieveitching?

•Weanoffcorticosteroids
•ACTHstimulationtoseeifsafetoabruptlystop,ifnotthen decreasepredto0.5mg/kgq48hrsfor1wk,then0.2 mg/kgq48for1wk,then0.1mg/kgq48hrfor1wk,then 0.05mg/kgq48hrfor1wk,then0.02mg/kgq48hrfor1 wk,thendiscontinue
•Startantihistamines(e.g.Benadryl2mg/kgq12hrs)and omega3fattyacids
•Avoidantihistamineswitheffectsonneurotransmitters (e.g.doNOTuseAmitriptyline)
•Cytopointinjectionsmonthly
•Whatwillyoutellownerregardingprognosis?
•Varieswithabilitytoidentifyunderlyingcause


•Ivermectin0.3mg/kgSIDuntil2negativeskin scrapingstaken4weeksapartORisoxazoline monthly“forever”
•Cephalexin22mg/kgBIDfor6weeks
•BenzoylPeroxideshampooonceweekly
•Cytopointmonthly
Case#2:Sue
•7yrFSGermanShepherd

•Painful,malformed,brittlenailswithoccasionalnailsloughingand bleeding
Review:Dermatology/ClawTerminology
•Malformednails=Onychodystrophy
•Brittlenailswithlongitudinalsplitting= Onychorrhexis
•Separationofthenailfromtheunderlying corium(stillattachedproximally)= Onycholysis
•Completesloughingofnails= Onychomadesis


•OnycholysisOnychomadesis
•Remainderofthephysicalexamisnormal
•Noadditionalcutaneoussigns
Whatdoweknow?
•Allfourfeetaffected
•Onlypedalinvolvement
•Onlynailinvolvement
WhatareyourDDx?
•SymmetricOnychomadesis(LupoidOnychodystrophy)
•Pemphigusfoliaceous
•Bullouspemphigoid
•SLE
•Dermatomyositis
•Vasculitis
•Drugeruption
•Fungalinfections
•Neoplasia(primaryormetastatic)
SymmetricOnychomadesis (LupoidOnychodystrophy)
•Mostcommonrecognizedcauseofonychomadesis
•GSDs,MiniatureSchnauzers,Rottweilers,Greyhounds+/Goldens/Labradors
SymmetricOnychomadesis(Lupoid Onychodystrophy)
•Keyclinicalfinding:
•multiplenailonychodystrophywithverylittleassociatedparonychiaandno otherclinicalsigns
•SLObasedonphysicalexamonly
•DefinitivediagnosisrequiresremovalofP3 forhistopathology

SLO—whatareoptionsforTx?
SLO-Treatment
•Thisislikelyanimmunemediateddisease;treatment aimedatdampeninginflammation
•TreatmentOptions
•Tetracycline/Niacinamide:
•<10kg=250mgeaTID,>10kg=500mgeaTID
•FattyAcids(omega3)
•VitaminE:200-400IUPOBID
•Pentoxifylline:20mg/kgBID
•Glucocorticoids1-2mg/kg/day
•Cyclosporine5mg/kg/day
•Whatistheprognosis?
•10yrMCSheltie

•Good,mostcanbeadequatelymanaged withwelltolerateddrugs
•Needtotreatanysecondaryinfections
•Mayrequirelongtermtreatment
•Surgicalremovalisanoptionformedically refractorycases
•Crustingandscalingwhichhasfailedtorespondtoantibiotics
•Recentonsetofvomiting,anorexia,lethargyandlameness
GeneralPhysicalExamination
•Depression
•Dehydration(prolongedskintent)
DermatologicExamination
•Generalized,diffusedryflakingskin

Whatdoweknow
•Multiplefeetaffected
•Additionalcutaneoussitesinvolved
•Mucocutaneoussitesinvolved
•Systemicabnormalitiespresent
DermatologicExamination
•Hyperkeratosis,crustingandfissuringofthefootpadsonall4feet

DermatologicExamination
•Ulcers/Erosionswithcrusting overmucocutanaeousjunctions andpressurepoints

Differentials
•WhatareyourDDx?


Differentials
•Hepatocutaneoussyndrome
•a.k.a.Superficialnecrolyticdermatosis(SND),metabolic epidermalnecrolysis(MEN)
•Pemphigusfoliaceous
•Zincresponsivedermatosis
•Systemiclupuserythematosus
•Cutaneousepitheliotrophiclympoma
•DrugEruption
InitialTests?
•Superficialcytology
•TNTCneutrophilswithintracellularcocci
•CBC/biochemistry/urinalysis
•Mildnon-regenerativeanemia
•ElevatedALT,ALKPhos
•Decreasedalbumin
InitialTests?
•WhatisyourPDx?
Interpretation?
•Cocciarealmostalwaysasecondaryproblem
•BiochemistrysuggestshepaticdysfunctionHepatocutaneous syndromemoveshighestonthelist
Interpretation?
HepatocutaneousSyndrome
•Raremetabolicdiseaseaffectingprimarilyolder dogs
•Mostcommoncauseindogsisanunderlying hepatopathy,lesscommonlyaglucagonoma
•Hepatopathyisfrequentlyidiopathic, occasionallyassociatedwithphenobarbital administration
SecondaryDiagnostics
•Biopsy
•Classic“Red,WhiteandBlue”patternof hepatocutaneoussyndrome
•Serumaminoacids
•Levelsmarked
Treatment
•Whataregoalsoftreatment?

•AbdominalUltrasound
•“SwissCheese”liver(mayormay notbepresent)

•Mayalternativelydetect glucagonomasorother pancreaticorhepatictumors
Treatment
•Managementofsecondaryinfections
•Correctionofunderlyingdiseaseifpossible
•Providesupplementationwithaminoacids+fattyacidsandzinc
•Painmanagement
Treatment
•Twicelabeldosefattyacids
•Highqualityproteindiet
•Oralsupplementationwitheggyolks(3-6/day)
•Oralsupplementationwithzinc(egzincmethionine 2mg/kgdaily)
•IVAminoAcidInfusions(25ml/kgover10hrsfor3 daysorq48hrsfor3treatmentsthenwklyoras needed)
•Poor,almostuniversallyfatalunlessanunderlyingcausecanbefound andeliminated
•Animalscanbepalliatedwithproteinsupplementationandqualityof lifemaybeacceptableshortterm
Riley
•9yrMCMixedBreedDog

PhysicalExamination
•Nootheradditionalabnormalities
•Whatshouldwepaycloseattentiontoonphysicalexam?
Whatdoweknow?
•Onlyonetoeaffectedononefoot
•Noadditionalcutaneousorsystemic signs
WhatareyourDDx?
PresentingComplaint
•Massontoe


PhysicalExamination
•Nootheradditionalabnormalities
•Whatshouldwepaycloseattentiontoonphysicalexam?
•locallymphnodes
Differentials?
•Neoplasia
•BacterialGranuloma
•FungalGranuloma


PseudomonasSquamousCellCarcinoma
NeoplasticorMicrobial?
InitialDiagnostics
•Fineneedleaspiration
•Mass:monomorphicpopulationofpigmentedroundcells
•LocalLymphnode:normallymphoidtissue
•Whatmightyouwanttodobeforestickinganeedleinthe mass?
PretreatmentwithBenadryl
DigitRads:
noboneyinvasion
SecondaryDiagnostics
•Digitalamputationandhistopathology:
•Malignantmelanomanoevidenceoftumoratbiopsymargins
•MetCheck:
•Thoracicrads:clear
•AbdominalU/S:clear
TentativeDiagnosis
•Melanocyticneoplasia
Prognosis
•Approx.1/3digitalmelanomashavemetastasizedbytimeof diagnosis
•Mediansurvivaltimeof4monthswithlargetumorsto12months withsmallertumors
reception@missourivetderm.com campbellmotsingerk@missouri.edu
1092WentzvilleParkway
Wentzville,MO63385
636-332-5041


Leah Cohn, DVM
Teaching
TeachinganOldDogaboutNewDrugs

LeahA.Cohn,DVM,PhD,DACVIM(SAIM)
LotsofDifferentSortsof“New”Drugs
•Genericversionsofdrugsalreadyinuse
Newgenericmaropitantforvomiting
•Newformulationsofexistingveterinarydrugs
Liquidsuspensionofmethimazoleforfelinehyperthyroidism
•Newdrugssimilartoexistingveterinarydrugs
NewJanusKinaseinhibitor,ilunocitinib,foritchrelief
•Humandrugsapprovedforveterinaryuse
Liquidsuspensionoftelmisartanforhypertensionincats
•Newdrugssimilartoexistinghumandrugs
LiquidsuspensionoftorsemideasdiureticforCHFindogs
•Brandnewthingsneverbeforeseen
Monoclonalantibodyforcanineparvovirus

HowDo DrugsCome toBe?
HowVeterinaryDrugsareFDAApproved
Acme Drug Co. Itstartswithadrugcompanydeveloping(orbuying)adrug

Next,thecompanyreachesouttothe CenterForVeterinaryMedicine(CVM) OfficeofNewAnimalDrugEvaluation(ONADE)




ForVeterinaryMedicine, TwoAgenciesfor“Drug”Approvals


Drugs
•Obvious •Immunesystem achievesdruglikeeffect

Drug Co. NewAnimalDrugApplication NADA ANADA
AbbreviatedNADA(generics) Awholelotofresearchinto efficacyandsafety




TheCVMcansay“NO”
CanapplytoCVMfor ConditionalApproval(CA)
TheCVMcangrantapproval
MinorUse,MinorSpecies(MUMS)
CAwashistoricallyforMUMS








CAandXCA
•Fullsafetydata
•Fullmanufacturingdata
•Reasonableexpectationofeffectiveness
Allowsupto5years(renewableyearly)tomarketthedrugand collectproofofefficacydata

“CA-1”meansitsthefirstapplicationforthatdrug
•ELDU:extra-labeldruguse
•AMDUCA:AnimalMedicinalDrugUseClarificationActof1994
•AMDUCAallowsELDU
•Veterinarian/client/patientrelationship
•Drugisapprovedforanimalsorhumans
•IncludesOTCandcompoundeddrugs
•Noapproveddrugfortheintendeduse
•Animal’shealthisthreatened

•Cannotresultinresiduesinfoodproducinganimals


“TheIndex” LegallyMarketedUnapprovedNewDrugIndex
•PredominantlyusedforMinorSpecies
•Alwaysinanon-foodspeciesorstageoflife(oysterspat)
•FasterandlessexpensivethantheFDAapprovalprocess


•Meetsthedefinitionofa“newanimaldrug”
•New(notgrandfathered1938)
•Drug(treat,mitigate,cure,prevent,ordiagnosedisease)
•NotGRASE
•Isintendedforuseinanimals
•Doesnothave…
•Approval
•Conditionalapproval

•Indexeddrug GRASE:GenerallyRecognizedAsSafeandEffective

FDApermitssomeunapprovedprescriptiondrugstobe marketedif:
•Thedrugissubjecttoanopendrugefficacystudy implementation(DESI)program
•Healthcareprofessionalsrelyonthedrugtotreat seriousmedicalconditionswhenthereisnoFDAapproveddrugtotreatthecondition,
•ThereisinsufficientsupplyofanFDA-approveddrug


Justbecauseit isn’tlegaldoesn’t meanitdoesn’t happen
•FIPoptions
•ELDU
•Newoptionindevelopment
•Compoundeddrugoptions
•SGLT2idrugs
•CKDanemia
•Pancreatitis
•Monoclonalantibodies
•Parvovius
•Arthritispain
Veklury
Remdesivir–FDAapprovedforCOVID19
•HastobegivenIVorSQ
•Difficulttogetattimes
•Verycostlyoption
•Usuallyusedtobuytimetogetsomething else
Itiscompletelylegalforyoutoprescribe andadministerviaAMDUCAELDU


GC376 1314 1516 1718
FelineInfectiousPeritonitis
•Multipleantiviraloptionswithefficacy
•COVID19derailedoriginalplans




GC376Anivive
•Investigationaltreatment
•WorkingtowardFDAapproval
•BIDSQinjection



BovaGS-441524Tablets
Compounded,NOTFDAapproved

•Tabletsavailableforofficeuseinmoststates
•Quadscoredtabletsfortinykittens
•Eitherformavailablebyprescription


Molnupiravir

Compounded,AlsoNOTFDAapproved
•Authorizedforemergencyusebythe



So,WhatDoYOUDo AboutFIP?
•Youcanprescribeandadminister Remdesivir
•InMissouri,youcanstockasmall supplyofcompoundedGStablets tolastaclientafewdays
•Youcanprescribetocompounding pharmaciesforeitherGS-441524 orMolnupiravirwith2-dayshipping toclient
SpeakingofCats,…CKD!
•15to30%ofcats>12yearshaveCKD
•Managedietandhydrationandtreatthetreatablecomplications
•30to65%ofcatswithCKDIRISstages2,3&4areanemic
•AnemiaworsensQOL
•Renalerythropoietin↓PLUS ANewOption:UpregulateCat’sOwnEpo



•HypoxiaInducibleFactor(HIF)alphaandbeta→epotranscription
•Innormoxia,HIFisdegradedbyprolylhydroxylase
•Healthykidneysmetabolicallyactive,relativelyO2poor
•FailingkidneyshaveplentyofO2soturnoffHIF

Varenzin-CA1
MolidustatOralSuspension
•UsedtotreatNRanemiaofCKDincats
•HIF-PHinhibitorkeepsHIFgoing
•StimulatesproductionofEPO
•Oralsuspension(fishflavor)
•28dayson,7daysoff,repeatprn (avoiderythrocytosis)
Ifitdoesn’twork,lookfor otherissues(eg,Fedef)
HIF-PHinhibitorforanemiaofCKD(daprodustatsimilar)


SGLT2iDrugs
“Flozins”forhumandiabeticssince2013
•Canagliflozin
•Dapagliflozin



•Oncedailyoral 2526 2728 2930
•Empagliflozin
•Ertugliflozin
•Bexagliflozin
•Sotagliflozin

Block~90% resorptionof glucosefrom S1segmentof proximal tubule
The10%that’sleftcan protectfromhypoglycemia

LowersBloodGlucosebyDumpinginUrine
•VeryeffectivefortypeIIDM
•HumanbenefitsextendbeyondDM
•Cardiovasculardisease
•Renaldisease


Elanco Bexagliflozintablets BoehringerIngelheim Velagliflozinliquid

BothAreVeryEffective; BothareFullyFDAApproved
•Approvedfornewlydiagnosed diabeticcats
•Notforcatsthataremarkedlyill
•NotforcatswithDKA

Ketoacidosis
Remember,absoluteinsulindeficiencyleadstoeventualDKA.Weare givingSGLT2itocatsinleuofinsulin.
•That’sfine,iftheystillmakeinsulin
•Iftheydon’tmakeinsulin,that’snotfine

EuglycemicKetoacidosis
Fuzapladibsodium

•Usedtotreatcanineacutepancreatitis
•Leukocytefunction–associatedantigen1(LFA-1)inhibitor
•PreventsextravasationofPMNintoareaofinflammation
•Lyophilizedpowder,multiusevial
•IVinjectionq24hfor3days


•UrinedipstickNOTGOODENOUGH!

•Nitroprussidecolorimetricreactiondoesnotdetectthemost abundantketone(3-beta-hydroxybutyrate)
•Validateddevicesforblood/plasmameasures
•85%ofketosisoccurred<2weeksoftreatment
•Incidenceofketosiswas~7%
•Ifketosisoccurs,switchcattoinsulin
3D,7D,14D,30D,90D,orifthey getsick




MonoclonalAntibodies
•Oneclonalsourcemeansthereisonly ONEspecifictarget


•>100alreadyapproved;>250moreinclinicaltrials
•Immunemediateddisease,infections,cancers,andmoretargets

TheFirstVeterinaryMonoclonal:Cytopoint Lokivetmab
•CananizedAnti-IL31
•IL31involvedinpruritus
•Efficacybeginsin1-3days,lasts4-8weeks
•Approvedfortreatmentofpruritusassociated withcanineallergicdermatitisandatopic dermatitis
Canbeadministeredoverandover becauseitiscananized




MonoclonalAntibodiesAvailableIn VeterinaryMedicine
5FDAapprovedsofar(2conditionalapproval)
•Lokivetmab(Cytopoint)
•Bedinvetmab(Librela)
•Frunevetmab(Solensia)
•Gilvetmab
•Canineparvovirusmonoclonal
Allergicdermatitis Arthritis Arthritis
MCTandmelanoma Parvovirus
CanineParvovirusMonoclonalAntibody (Apparently,itdoesn’thaveanyothercatchyname!)

•USDA(notFDA)conditionallyapproved
21treatedpups 7controlpups



Parvovirus
•Despitevaccination,remainsamajorcauseofmorbidityand mortalityinpuppies
•Tonow,carehasbeenentirelysupportive
•Addresshydrationandvolume
•Addressvomitingandnausea
•Addresssecondarybacterialinfection
•Addressothercomplications

•Chimericrodent-derivedmAb
•Notcaninized
•BindsCPVwithhighaffinity
•Blocksvirusfromenterocyte
•Singledoseadministration
•Impactonmorbidityaswellas mortality
•Reduceburdenofcare




Solensia&Librela Frunevetmab&Bednvetmab
•Bothare(fully)FDAapproved
•AttachtoNerveGrowthFactor



•Maropitant–acutevomiting
•Carprofen–painandinflammation
•Felanom(methimazole)-hyperthyroidism
•Pimomedin(pimobendane)–MMVD,CHF
•UpCard-CA1(Torsemideoralsolution)–CHF
•Phenylpropanolamine–urinaryincontinence

•DuOtic(terbinafineandbetamethasone)–otitisexterna
•Trimeprazinewithprednisolone-antipruritic,antitussive
•EnroProSilverOtic(enrofloxacin/silversufadizine)–otitisexterna
•Contrased(atipamezole)-reversaldexmedetomidineandmedetomidine
•Zenrelia(Ilunocitinib)–JAKinhibitorusedtotreatallergicitch
Zenrelia Ilunocitinib
•Januskinase(JAK)inhibitor
•Controlallergicitch(similartoApoquel)
•Considerimmunosuppression,+/-cancerrisks
•Donotvaccinatedogswhilereceivingdrug
•Withhold1-3monthsprior,1monthaftervaccination

Clevor Ropiniroleophthalmicsolution
•Fulldopaminereceptoragonist
•FirstandonlyFDA-approvedemeticagentfordogs
•EyedropsbasedonBW
•Singleusedroppers

EntyceandElura Capromorelinoralsolution
•Mimicsthe“hunger”hormoneghrelin
•StimulatesGHreleasefrompituitary,which stimulatesIGF-1releasefromtheliver


•Guaninenucleotideanalog
•Treatmentforlymphomaindogs
•30minutesIVinfusionq3weeksfor5doses
•AvoidinWesties(pulmonaryfibrosis)
•MedianPFS151days,responserate73%,betterBthanT OriginallyCA-1,nowfullyapproved

Laveridia-CA1 Verdinexor
•SINE;selectiveinhibitorofnuclearexport
•Inhibitsexportoftumorsuppressorproteins
•Oraltabletfortreatmentoflymphomaindogs
•Fullefficacystudiesneededtoremovethe“CA”

Ayradia Metronidazoleoralsuspension
•FDAapprovedasa5dosetreatmentforGiardia

Zorbium Buprenorphinetransdermalsolution
•Opioidanalgesicappliedtotheskin
•Inclinicapplicationfor4daysofpaincontrol
•Canavoidneedforclientstogiveanalgesicathome

UpCard-CA1 TorsemideOralSolution
•Potentloopdiuretic
•ManagepulmonaryedemaindogswithCHFdueto myxomatousmitralvalvedisease
•Approvedtobeusedwithpimobendane,spironolactone, andACEinhibitordrugs

Leah Cohn, DVM
LeahA.Cohn,DVM,PhD,DACVIM(SAIM) Professor,UniversityofMissouriCollegeofVeterinaryMedicine
































AntimicrobialStewardship
•Hippocrates:first,donoharm
•Need
•Type
•De-escalation




•Duration AMRpredictedtokill morepeoplethan cancerby2050



Leptospirosis
•Bigdogvs.littledog
•Corevs.non-core
•Quadrivalent
•Vaccinereactions
•Darkfieldisout
•POCtestsarein
•HighesttiteronMAT doesn’tmeanwhatwe thoughtitmeant


Acute-OnsetPancreatitis
•Steroidscausepancreatitis
•It’sstillhardtodiagnose
•NPOnomore
Plasma,Abx,andPPIareout




CidalandStaticAntibiotics


•They’reoutthereallyearlong
•Catssuffertoo,evenwithoutadult worms
•Pre-treatingforAgtests
•Wolbachiaisarickettsia(doxycycline!)
•Don’tstagetreatmentdifferently dependingonclassification
•Exception:cavalsyndrome

Filaribits(diethylcarbamazine) Caparsolate(thiacetarsamide)


•PPIsuperiortoH2RAforGUE
•PPIBID,taperedafter3-4weeks
•H2RA→tachyphylaxis3to13days
•PPI,H2RA→dysbiosis
•Ifthereisgastriculcer/erosion,yes…
•Notautomaticwith“CKD”(formerlyCRF)



•Notforpreventionofulcersinanimalsonsteroids
•NotforpreventionofulcersinanimalsonNSAIDs
•Notforcriticalillness
•Notforpancreatitis
•Notforvomiting

Catsaremoresusceptibletohypervolemia/overhydration duringshocktreatmentthandogs 1314 1516 1718
•It’snotJUSTesophagitis
•Cough
•Chroniclowerairwaydisease
•Nasaldischarge
•It’snotJUSTacid
•Digestiveenzymes,too
•Lifestylemodifications:
oBodycondition
oLowfatmeal
oMealsize,frequency,timing
•Itdoesincludeacid;PPI



•Resuscitation
•Optimization

•Stabilization
•Evacuation



•Resuscitationbolus
•Bufferedisotoniccrystalloid


•Forrapidintravascular volumereplacementina hydratedanimal, hypertonicsaline 5-10ml/kg 15-20ml/kg
Reassessperfusion parametersaftereach bolus
AcuteDiarrheaandMetronidazole
•~50to70%ofdogsgetMTZforacutediarrhea
•Nobetterthan“other”6/7studiesindogs
(worsein4)
•Afterrulingout“substantial”disease,consider dietarymanipulation,solublefiber,probiotics, prebiotics,clays




Thromboprophylaxis
•Clopidogrelisinexpensive
•ClopidogrelispreferredtoaspirinforFATE(andeverythingelse?)
•Geneticmutations*MIGHT*alterefficacyformany whenalbuminnormalizes

AsymptomaticBacteruria/SubclinicalBacteriuria
•Humansdescribesymptoms,animalsshowsigns
•Forhumans,ABisconsideredirrelevantotherthan pregnancy,invasiveurologicprocedures
•ISCAIDhasoptedtotreatSBthesameway
Don’tscreen,don’ttreat Doesn’tmatteriftheyhaveDM,Cushing’s,…

•Theycan’ttellusifit“burns”
•Dogsgetstruviteuroliths
•Bladderhygieneinparalyzedpetsis notlikeforpeople
•Peopledon’turinateontheirincision sites
•Bacteriuriaimpactonnon-urinary disease–evidenceoflack,orlackof evidence?



•Amoxicillin
•Amoxicillin-clavulanate
•Trimethoprimsulfa
OR

•NSAIDSpendingculture/susceptibility3to5daysonly Ifsignsresolve,no repeatUAorC/S
•POCp27stillfirstline,butproviralDNArtPCR helpful
•Vaccinationiscoreforkittens,boosteredat1 year,butthereafterbecomesconditional



1-2-3yearsandyou’reout?

•ACTHstimhasNOTbeenvalidatedasthe bestwaytomonitortherapy
•Whatisthegoal?
•Controlclinicalsigns
0.5-1mg/kgBID

•Avoidhypoadrenocorticism cpACTH2-7ug/dL?
ACTHstim2-4h Prepillcortisol Post-pillcortisol2,4,6h Adrenalsize Haptaglobin UCCR,cortisol/ACTHratio,…
Surveyandlytes StimifIwanttoupdose


60ml/kg/d
132*BW(kg)0.75
30*BW(kg)+70

40ml/kg/d
80*BW(kg)0.75
30*BW(kg)+70
Babies2.5-3Xmore

ParenteralAntibiotics:“Better”thanOral?
•Sometimes,theyareclearlybetter!
•Vomiting,regurgitation,malabsorption,… Non-inferiorityoforalinMANYhumanstudies

•AsmuchasIcouldgetawaywith…
•“Extra”IVcrystalloidsina euvolemic,euhydratedanimalwill NOTimproveGFR!
•Kidneyfailureoften→dehydration, sotheymayneedmorethan “maintenance”


Base(X)iskg,exponent(y)is0.75
25pounddog=11.3kgdog 60ml kg 11.3kg 24h =28.25 60ml/kg/day
132*BW(kg)0.75





PrazosinforFelineUrethralObstruction
•Common(10%ER);recurrencecommon(75%)&soon(<16d)
•Alpha1–adrenergicantagonist→smoothmusclerelaxation
•~1/3ofthefelineurethraissmoothmuscle;proximalportiononly
•PrazosinoftenusedforUO,bututilityquestioned
•Didn’thelp,sometimeshurt,butunderpoweredforahardNO



ImmunosuppressivePredniso(lo)ne
•WhatISanimmunosuppressivedose?
•Generallysaidtobe2-4mg/kg
•Likechemotherapeuticagents,bodysizematters

•Immunosuppressivedosegenerallyagreedtobe~40-50mg/m2
BSAm2=K(speciesspecific)xBWingrams2/3X10-4 1m2~69pounddog
80pounddogisa36.3kgdogisa1.01m2dog 73mgvs50mg(or40mg)÷
•Clean
•Clean-contaminated
•Contaminated


•Dirty 30minutespriortocut,q90–120minutestillclose “Likeotherprophylactics,useonlyatthetimeoftheevent”
SteroidsforVaccineHypersensitivityor Anaphylaxis
•Amazinglylittleevidencethatsteroidsaddbenefit overothertreatmentsoftypeIhypersensitivity
•Fluidresuscitation
•Epinephrine
•Antihistamines



AntibioticsforDentalinDogswithMurmurs
•ADA:rarelyindicatedevenforpeoplewithprostheticimplants
•Chemicalpneumonitis
•Nebulization,hydration,nutrition, oxygenationmaybeadequate
•DecisionregardingAbx:entire picture,includingCBC


HyperkalemiaResuscitationFluids
•HyperkalemicfluidresuscitationdoesNOTneedtobeK+freefluids!
•TinyamountofK+inLRSorNormosolR
BSAVA:patientsthatareimmunosuppressed,thathavesignificant comorbidities,whentheprocedureislong,orthereisbonyinvolvement
AAHA:maybeindicatedinpatientswithsystemicriskfactors,suchas subaorticstenosis,systemicimmunosuppressionandorthopedic implantsplacedinthelast12–18months
AVDC:animalsthatareimmunocompromised,haveunderlyingsystemic disease(suchascertainclinically-evidentcardiacdisease(subaortic stenosis)orseverehepaticorrenaldisease)and/orwhensevereoral infectionispresent


•Antibiotics(presumptiveE.coli)
•Amoxicillin/clavulanicacid
•Cefazolin
•Medicalmanagement:young,healthy bitchesimportantforbreedingprogram
•Surgicalmanagement
Justonedaypost-opantibiotics, unlessongoingsepsis

•Balancedisotonicfluidscorrectacid-baseimbalanceFASTERthan 0.9%saline(acidifyingfluid)
•Addison’s:balancedfluidsmeanlessdangerofoverlyrapidNa+ correction
0.5-1ml/kg slowIV






Leah Cohn, DVM
LeahA.Cohn,DVM,PhD,DACVIM(SAIM)
History
•Lethargy
•Weakness
•Collapseepisode
•Bleeding
•Trauma
Physical
•Pallor
•Murmur
•Tachycardia
•Findingsrelatedtocause
•Evidenceofbleeding
•Evidenceofmass
•Evidenceofhemolysis
HematocritandTotalSolids
TheClinicalPathologist’sApproach…
Regenerativevs.Non-Regenerative
https://pressbooks.umn.edu/cvdl/chapter/module-7-4-reticulocyte-procedure/ Punctate
Aggregate



AssessingRegeneration
•Newmethylenebluestainedreticulocytes
•Absolute
•Corrected

>92Kor>1%
>61Kor>0.4% =patientretic%X(patientPCV÷speciesnormalPCV)
•Polychromasia
•Anisocytosis
•NucleatedRBC
https://eclinpath.com/hematology/anemia/assessment-regeneration/canine-reticulocytes-2/
TheInternistsApproach… alwaysincludeshistoryandsignalment

Bloodloss

Hemolysis

Decreased production
TheInternistsApproach…

Bloodloss


•Signalment,historyclues
•Seetheblood!
•Rectal,urine,ecchy,POCUS
•Reasonforbleeding?
•Coagulopathy
•Parasites
•LowTP,albumin
•HighBUNd/tGIbleed
•Oftenregenerative(3-5days)




•Notsuperregenerative 78 910 1112
TheInternistsApproach…

Hemolysis


•Signalment,historyclues?
•Microscopicshapechanges
•RBCinclusions
•Autoagglutination
•Bilirubinemia/uria
•Hemoglobinemia/uria
•Coomb’stest
•Oftenregenerative(3-5days)

TheInternistsApproach…

Decreasedproduction


•Signalment,historyclues?
•Examclues?
•Neverregenerative
•Othercellslinesoftenimpacted
•OftentoleratereallylowPCV
•Proteinscanbeanywhere



•Threemonthsprior(October),attackedbyanotherpitty-typedog. Severeinjuriesrequiredamputationoftherightforelimb,removal oftheupperrightlip,andatoenailontheleftfrontfoot.
•Recoveredwelluntiltheweatherbecamecolder,whenhe becamelethargicandlostsignificantweight.
•Tobehonest,hisvetfigureditout,butfor fun,wewillgoonasifnot…Januarynow
•Examinationfound“theobvious”,palepink mm,T103.2o,mildtachycardia,BCS3/9
•PCV24%,TS6.9,clearserum


Macho
Bloodloss
Hemolysis
Decreasedproduction
Loss
•Don’tseewhere
•Proteinsaren’tlow
Hemolysis
•Serumisclear
•Biliisnormal
•BUNisn’thigh






RBC4.08
HCT24.4
MCV69.9
MCHC30.3
Retic%3
PMN2.84
Lymph2.01
TBili0.1 BUN18 =3X(24÷45)=1.59
Eos0.18
Baso0.01
PLT108,000
TP6.5



•IMHA,non-associative(1o)
•IMHA,associative(2o)
•Infection,drugs,cancer
•RBCparasites
•Toxins
•Zn,acetaminophen,skunkmusk,onions
•Hypophosphatemia
•Envenomation
•Hemolytic-uremicsyndrome
•Transfusionreaction
•Neonatalisoerythrolysis
•babesiosis,hemotropicMycoplasma,cytauxzoonosis
•Microangiopathicdisease
•DIC,caudalcavalsyndrome,splenictorsion,HSA
•Enzymaticheritabledisorders
•PKdeficiency,PFKdeficiency
•Non-enzymaticheritabledisorders
•Osmoticfragility
MachoTreatedwithAtovaquone andAzithromycinfor10Days
•Respondedwelltotreatment
•Curemayormaynotoccur

Atovaquone
•Single-drugatovaquoneliquidsuspension
•Combinationtabletatovaquoneandproguanilhydrochloride

Scout
Bloodloss
Hemolysis
Decreasedproduction
Noneedformathwhen absolutesreticsgiven!
ALB2.8
TBili0.60.1-0.4
ALT29
ALP20012-98
RBC1.235.94-8.2
HCT9.640.4-56.9
MCV77.9
MCHC31.3
Retic(abs)30.0
WBC16.044.8-13.4
PMN13.152.49-9.28
Lymph1.6
Eos0.00.07-1.64
Baso0.0
PLT299,000
TP6.2
Fewreactivelymphs,mildPMN toxicity,moderateanisocytosis, occasionalspherocytes
Scout,~7yearoldFS15kgMixedBreedDog
•Reducedappetite1week
•Onlypriorhxatopy;apoquel
•Severeanemiapromptedreferral
•Exam:pale,tachycardic,2/6basilarl-sided murmur,boundingpulse,normalrectal,no icterus
•SpunPCV9%,TS6.1,plasmaclear
Loss
•Nosignalment,history,orexam
•Albumin,TSlownormal
•BUNwasnothigh
Hemolysis
•Middleagedbitch
•Bilirubinupasmidge
•Noautoagglutination 1314 1516 1718
•Occasionalspherocytes
•Noinclusions
•Clearserum


Notonarrival–hewasBAR
Decreasedproduction
•Nosignalment,history,exam
•NOTregenerative….
•Atleastoneweekdurationof illness
•Nomicrocytosissuggestiveof irondeficiency
•Othercelllinesseemfine
•PCV9%inaBARdog…suspicious!
Scout
•Coomb’s
•AbdominalradsandUS
•Thoracicrads
•SNAP4Dx
•ComprehensiveVBD
•Fecalfloatation
•Transfusion


•Gastriculcertx,doxycycline Patient’sRBC Patient’sAb Commercialantisera


•Myelopthisis
•Myelofibrosis
•Aplasticanemia
•Addison’sdisease
•Cobalamindeficiency
•Chronickidneydisease
•Bonemarrowtoxicity
•Myelonecrosis
•Myelodysplasticsyndrome
•Pureredcellaplasia
•Precursor-targetedIMHA(PIMA)
•Radiationexposure
•Estrogen,azathioprine,phenobarbital
•Infectiousdisease
•FeLV,ehrlichiosis,histoplasmosis
•Inflammatorydisease
•Poorlycellularsamplewithblood contamination
•Ineffectiveerythropoiesis
Wecanruleoutmanycausesof decreasedproduction,andone becomesmorelikely…
Scout
•Multipletransfusions
•Immunesuppression
•Prednisone
•Cyclosporin
•Folicacid
•Irondextran

Precursor-targetedImmuneMediatedAnemia
•Onlynamedin2017
•Poorlydescribeddiagnostic criteriaotherthan
•Non-regenerativeanemia
•Ineffectiveerythropoiesis
•Myelofibrosiscommon
•Noothercauserecognized
•Delayedefficacy immunosuppression(~50-80%)

“approximately85-95%ofmarrowspacesare filledwithalargeamountofpinkfibrillar material(collagenfibers)withuniform,plump mesenchymalcellsintermixed.Thereare increasedironstores.Thereareafewsmall areasofhematopoietictissue(approximately 5-10%)thatappearfocallyhypercellular.These areasarepredominatelycomprisedof erythroidprecursors.Theerythroidline appearsleft-shiftedinmaturationbutrare reticulocytesareseenandnomorphologic abnormalitiesarenoted.Themyeloidline presentappearsslightlyleft-shiftedbut maturestocompletionwithnomorphologic abnormalities.“ Didn’twork

•Estimated75%efficacyinrefractorycases


ScoutSplenectomizedAugust2024
HCTRetic
Surgeryvisit:1042K
2weekslater:21.585K
4weekslater:2590K
8weekslater:35125K


BloodLoss
•Trauma
•Coagulopathy
•Abdominalhemorrhage

•Thoracichemorrhage(mediastinal,pericardial,pleural)
•Tissuehemorrhage
•Urinaryhemorrhage(renal,bladder)
•Bloodsuckingparasites(endoorecto)
•Gastrointestinalhemorrhage
•Respiratoryhemorrhage(nasal>lowerairway,pulmonary)
•Adopted4daysprior
•Vaccinatedanddewormedbybreederjustpriortoadoption
•“Calm”puppy
•Anorectic,pale
Exam
•Thin,pale,tachycardic
•2/6basilarsystolicmurmur
Severeanemia,lowTS,clearserum
2526 2728 2930

•HedidNOTimprove
•Okay,nowIhadtododiagnostics



•Lethargicandinappetentsincepickedupfrompet-sitting familymember2daysprior;darkurine
•LocalDVMperformedCBCandbiochemistryprofile, referredforpossibleIMHA(severeanemia,icterus)
•Arrivalexamination
•Extremelypale
•Obtunded
•~7%dehydrated
•Basilarsystolic2/6murmur
•Stoolorange,mucus


Tinker Bloodloss
Hemolysis
Decreasedproduction
Icterus
MODERATEANISOCYTOSIS, MODERATEPOLYCHROMASIA, FEWHOWELLJOLLYBODIES, FEWHEINZBODIES,FEW BASOPHILICSTIPPLING
•PCV9%,butthisdogisobtunded(unlikeScout)
•Noobvioussightofloss,normalproteins
•Icterus,darkurinesupporthemolysis
•Didn’tprovidereticulocytecount,butlotsofnRBCseen
•Can’tjudgeregenerationbynormoblastosis
•Heatstroke,splenicdisorders,bonemarrowinjury→nRBC
•Toxins(eg,lead)→nRBC
•Heinzbodies,HowellJollybodies,andbasophilicstipplingeach seenwithregenerativeanemiaand“other”insults(eg,lead)
•Othercelllinesincreased,notdecreased

PlasmaProtein7.26-8
WBC18.606-17
RBC1.145.5-8.5
Hgb3.112-18
Hct9.037-55
MCV77.060-77
MCHC35.232-36
PlateletCount441200-500
SegmentedPMN14.323-11.5
BandNeutrophil0.560-.3
Lymphocyte1.301-4.8
Monocyte2.420.15-1.35
Eosinophil0.000.1-1.25
Basophil0.00
NRBC/100WBC12.0
NRBC2232
IntraorExtraVascularHemolysis

nRBCcountedasWBConautoanalyzersnRBC

Coomb’sStatus


•IMHA,non-associative(1o)
•IMHA,associative(2o)
•Infection,drugs,cancer
•RBCparasites
•Toxins
•Zn,acetaminophen,skunkmusk,onions
•Hypophosphatemia
•Envenomation
•Hemolytic-uremicsyndrome
•Transfusionreaction
•Neonatalisoerythrolysis
•babesiosis,hemotropicMycoplasma,cytaux
•Microangiopathicdisease
•DIC,caudalcavalsyndrome,splenictorsion,HSA
•Enzymaticheritabledisorders
•PKdeficiency,PFKdeficiency
•Non-enzymaticheritabledisorders
•Osmoticfragility

•Spherocytes
•Schistocytes
•Heinzbodies
•Howelljollybodies
•Basophilicstippling
•Siderocytes

•Babesiosis
•Largeform
•Smallform
•Cytauxzoonosis
•Hemotropic mycoplasmosis






Leah Cohn, DVM

Leah A. Cohn, DVM, PhD, DACVIM (Small Animal Internal Medicine) Department of Veterinary Medicine and Surgery College of Veterinary Medicine University of Missouri, Columbia

measurement of antigen-antibody interactions for diagnostic purposes
• Antigen
• Part of the pathogen “Eye witness”
• Ex: Heartworm, FeLV
• Antibody
• Response to the pathogen
• “Fingerprint”
• Ex: Ehrlichia, FIV



• Disease diagnosis

• Supports (or not) your suspicion of a specific differential diagnosis for disease
• Epidemiologic survey
• Looks for a pathogen exposure in a population (geographic, activity, etc)
• Pathogen screening for individual
• Looks for a pathogen that may be present when a disease is not
• Send out
• Numerical “titer”
• Various methods
• Point-of-care

• Predetermined cut-off for “positive” result
• Usually an ELISA test

• Positive tests
• Transient Ag
• Non-specific Ag
• Cross reaction
• Error Negative tests
• Low Ag concentration
• Ag complexed
• Sample type
• Error
• Positive tests
• Exposure not infection
• Not pathognomonic
• Passive transfer
• Cross reaction
• Error Negative tests
• Acute infection
• Immunosuppressed
• Immune tolerance
• Ab unavailable complexed, catabolized
• Error
• Previous infection
• Incidental infection

• For example, Rickettsia rickettsii
• Causative agent RMSF
R. parkeri R. felis R. conorii
africae
australis
japonica
bellii
marmionii
sibrica








• It is often a poor screening test
• Analytic vs. diagnostic sensitivity
• It can prove a pathogen present
• But not disease causation
• It can NEVER PROVE a pathogen absent!


You can’t use PCR to prove a + serology is notdue to infection
• Screening tests always have Pro’s and Con’s
• Consider prevalence
• Consider consequences

• False +’s in low prevalence areas
• May lead to unneeded treatment
• Infection may never become clinical
• Past infection may be resolved
• Adverse effects; costs; resistance
• Treatment may not “cure”
• Treatment may not prevent re-infection
• May allow treatment before disease
• Provides regional prevalence information
• May provide sentinel information
• Informs ectoparasite and endoparasitecontrol
• May reduce pathogen reservoir
• Alerts to non-tested pathogens
• Yearly serologic screening recommended



• Antigen test for female worms
• More sensitive than microfilaria tests
• Not perfect test
• Low burden




• Male worms
• Ag-Ab complex
• Error
• Positive 5-6 months after
• Delayed (or negative) on preventative
False negative more likely than false positive
• Confirm results
• Microfilaria detection (modified Knott’s test)
• If Knott’s negative, repeat antigen test
• Same or different test
• Evaluation of heart and lungs
• Radiographs +/-echo
• Pre-adulticide evaluation
• Begin treatment per AHS protocols


• ACVIM consensus panelists recommend yearly antibody screening in endemic areas
• Recognized pitfalls: potential overuse of antibiotics in false + dogs or dogs that would remain healthy despite infection, expense, owner anxiety, time for owner education



• Discuss travel history
• Should have discussion when deciding to screen
• Non-endemic vs. endemic area (living, travel)
• Consider arthritis signs
• Perform a urinalysis
• Look for proteinuria
• Protein : creatinine ratio
• Investigate (and treat?) if you find it

• Same peptide in POC (ie, SNAP) and mail-out (Quant C6), but mail out provides titer
• There are other serologic screens out there
• C6 peptide only develops with natural infection
• No vaccine confusion!

• Evaluate (improve) ectoparasite control
• Consider vaccination (3/6 panelists recommend)
• Discuss owner options
• Quant C6??? < 30 U/ml
• ACVIM consensus panel says magnitude not predictive of illness
• High titer might even suggest robust (protective) immune response
• 1/6 panelists DOES suggest treat based on high quant C6
• 4/6 panelists do NOT recommend treatment (and do not recommend Quant C6)
• Overuse of antibiotics (vast majority stay well, cost, inconvenience, adverse effects including microbiome), no data that risk of illness decreased, may not clear all tissues, reinfection common in endemic areas



• All panelists recommend UA for proteinuria 2-3 times per year for life
• 1/6 recommend following Quant C6

Healthy Dog, Positive Dot
• An Ehrlichia dot doesn’t tell species
• Consider geography
• Perform a CBC with blood smear
• Look: thrombocytopenia, anemia, hyperglobulinemia or morulae
• Treat if you find them
• Perform a renal profile or SDMA
• Consider treatment if abnormal
• Perform a urinalysis
• Look for proteinuria
• Investigate (and treat?) if you find it

• It’s not JUST doxycycline
• Tetracyclines work on B. burgdorferi AND Anaplasma phagocytophilum…which is why it is usually treatment of choice
• Beta lactams also very effective for Lyme





Normal CBC, Chemistry, and Urinalysis
• Evaluate ectoparasite control
• Discuss owner’s options
• Every owner is different

• The “watch” is crucial!
• Educate the owners regarding potential complications/manifestations
• Every year, repeat
• CBC: ↓ platelets, ↓ RBC, morulae, hyperglobulinemia
• Chemistry/SDMA: azotemia
• UA: proteinuria, isosthenuria
• No real point in repeating serology yearly
• Goals to confirm infection, identify species
• A negative PCR can NEVER rule out infection
• While a positive might prompt treatment, a negative leaves you in the same place you started
• Species-specific serology not readily available
• But some labs can/will speciate
• Some serologies claim E. canis specificity
• Different tests may yield different results
• Discordant results can add confusion
IFA +/POC -
• Below set detection for POC
• Strain/species differences IgM vs. IgG (early)
• One of them is just wrong
• Strain/species differences
• + POC can persist years One of them is just wrong
• Risk vs. benefit of treatment (or not!)
• We think most healthy dogs with E. ewingii or E. chaffeensis will stay healthy (kidney disease?)
• Not all dogs with E. canis develop chronic disease
• Tetracyclines have consequences
• Cost, effort for owner
• Altered microbiome
• Drug resistance (other bacteria)

• GI upset, hepatopathy, drug fever, tooth discoloration, etc.
• Xenodiagnoses
• Tick infection from PCR-negative dogs


• There is no point in repeating the serology test
• Next year, a positive test could be
• Persistent antibody
• Persistent infection
• Recurrent infection
• PCR
• Live vs. dead
• Negative doesn’t rule out infection
• Better to check CBC/SDMA/UA next year

• Consider geography (travel history)
• A. platys vs. A. phagocytophilum
• Perform a CBC with blood smear review
• Look for thrombocytopenia, morulae
• Treat if find them


• Perform UA
• Look for proteinuria
• Investigate (and treat?) if you find it
Normal CBC and Urinalysis
• Just like Ehrlichia!
• Evaluate ectoparasite control
• Discuss owner’s options
• Watch and wait
• Yearly CBC/UA
• Investigate further
• PCR or species-specific serology
• Just give ‘emthe drugs



• Likely similar toEhrlichia, but not as well described
• Epidemiologic information can inform your practice

• Educate owners re vector-borne disease
• Zoonosis education
• Impact the way you practice preventive and therapeutic medicine
• Ectoparasite control
• And convincing the owner it is necessary
• Disease diagnosis
Empiric disease treatment


Fred Wininger VMD MD DACVIM (neurology)
Neurology/Neurosurgery-Charlotte Animal Emergency and Referral (CARE)
Adjunct Professor-University of Missouri and North Carolina State University
Neurolocalization is the ultimate goal of the neurologic examination, piecing the puzzle of reflexes and responses together to an anatomic segment. Once accomplished, the practitioner is able to assign a rank list of differential diagnosis for this neuroanatomic site based on the patient’s age, breed, clinical onset/ progression and the presence of spinal hyperesthesia. Whereas this list can easily be found in any neurology text, the ability to interpret findings and combine them to fit a single lesion site requires practice.
A concept integral in localization is that of the Upper Motor Neuron (UMN) and Lower Motor Neuron (LMN). The Upper Motor Neurons are essentially the long tracts from the brain that instruct the lower motor neurons what to do. The LMN consists of the motor neuron cell body within the spinal cord, the nerve itself, the neuromuscular junction and the muscle itself. In cases of UMN disease, the lower motor neuron works without instruction, known as a loss of inhibition. It is classically hypertonic, with normal to increased reflexes and minimal atrophy. In cases of LMN disease, the upper motor neuron is irrelevant, because the LMN cannot respond to its instruction. Thus hypotonicity, decreased reflexes and severe neurogenic atrophy are noted.
The spinal cord can be divided into four areas. The LMN of the limbs are located in swellings of the spinal cord known as intumescences. When these intumescences are the sight of disease, LMN signs are notable. When the lesion blocks the long tracts between the limb the brain and the LMN, UMN signs emerge. Thus the spinal cord can be divided into the following segments.
The neurologic examination is comprised of multiple parts for accurate localization.
Gait
Ataxia is defined as an uncoordinated gait and is frequently classified as “the drunken sailor walk”.
1. Proprioceptive/spinal-a.k.a The true drunken sailor walk, often coupled with a spastic/long strided gait suggesting UMN dysfunction. Patients are often thought of as overstepping or “floating”
2. Vestibular-Characterized by imbalance often manifest as “wall walking, coupled with a head tilt and nystagmus
3. Cerebellar lesions –Characterized by hyper/dysmetria (Goose stepping), truncal swaying, and intention tremors.
Paresis is weakness of the gait, reduced voluntary movement, whereas paralysis is complete loss of voluntary movement. Both paresis and paralysis (-plegia) can be used to describe the deficits in only one limb (monoparesis/plegia), in the pelvic limbs (para-paresis/plegia), in all four limbs (tetraparesis/ plegia) or on one side of the body (hemiparesis/ plegia).
The ability of a patient to identify the location of its limbs in space. A subjective but integral component to the examination, these tests confirm the presence of a neurological disorder and can detect subtle dysfunction, helping identify which limbs are affected. This includes paw position, hopping and placing responses.
Reflexes are quite different than responses, such as proprioception, in that they do not require forebrain input. This is an important distinction
The easiest and most reliable are the patellar reflex in the pelvic limbs and the withdrawals in both the pelvic and the thoracic limbs. Don't forget to examine the tail and anus (perineal reflex). Reduced reflexes in a limb identify a LMN lesion in that limb, whilst normal or increased reflexes localize the lesion to the UMN
Cutaneous trunci reflex (panniculus) helps narrow down lesion localization in the thoracolumbar region. After pinching the skin, the sensory information enters the spinal cord approximately two vertebral spaces cranially, ascends the spinal cord to the level of C8-T1 where bilateral synapse occurs with the motor neurons of the lateral thoracic nerve, which then course through the brachial plexus and innervate the cutaneous trunci muscle, resulting in bilateral contraction of these muscles. Normally, this reflex is present from T2 to about L4-L5 and a cut-off in this region suggests a spinal cord lesion just cranial to the cut-off level. Loss of the cutaneous trunci reflex can also be due to a brachial plexus lesion, in which case it will be completely absent on the side of the lesion and normal on the contralateral side
The spinal pathways that carry pain sensation are located deep in the spinal cord so only a severe lesion will impair pain perception (making this an important prognostic factor). For
conscious perception of pain, manifested by vocalization and/or turning the head and trying to bite, the information needs to be recognized by the sensory nerve, travel up the entire spinal cord cranial to that area and be interpreted by the brain. It is important to differentiate a pain response from a local withdrawal reflex (which should be present if both the peripheral nerve and spinal cord segment of the stimulated peripheral nerve are intact), in which case the limb will be retracted but no signs of conscious awareness of the pain will be evident. Pain sensation is tested by applying heavy pressure with haemostats to the bones of the digits (don't forget to test different digits) or to the long bones of the limbs
Looking for areas of hyperesthesia or deformities. Pressure is applied to the spinous and transverse processes of the vertebrae in all spinal segments. Manipulation of the cervical spine in all
Once neurolocalized to a thoracolumbar myelopathy, the decision of conservative management with cage restriction and analgesics vs. cross sectional imaging (MRI) become one of immediate importance. Differential diagnosis for the acute presentation includes intervertebral disc disease, trauma, ischemic myelopathy (FCE), myelitis or neoplasia. These differentials are prioritized based on signalment, progression, and the presence of spinal hyperesthesia.
The decision on which approach to take is clearly most influenced by long term prognosis. The prognosis mostly depends on the underlying etiology of the neurological deficits (e.g., spinal neoplasia vs. minor contusive injury). One of the most common conditions seen causing spinal disease is degenerative intervertebral disc disease. It is important to know the prognosis for recovery with either surgical or conservative treatment for the different degrees of severity of the signs so appropriate clinical decisions can be made. The reported success rates vary widely and Figure 2 is an amalgamation of several study results that can be used as a guideline. These guidelines are only applicable to IVDD and should not be used for other disease processes. For example, a dog with a spinal fracture secondary to vehicular accident has a grave prognosis associated with absent pelvic limb nocioception. The is because in cases of IVDD, the loss of nocioception can be due to compressive, contusive or ischemic disease, all of which have a potentially viable recovery. In contrast, the patient presenting with trauma can have a severed spinal cord with no potential for a meaningful recovery. Following the acute presentation, if patients are managed conservatively they are considered surgical candidates should clinical signs remain after two weeks of therapy. With the advent of MRI, neurosurgeons have arguably become more aggressive in recommending surgical intervention. This is because the severity of spinal cord compression noted on imaging suggests we grossly underestimate spinal cord compromise and possibly perceived pain. Interestingly, more recent reports of patient improvement with surgery have trended towards greater success in patients of all grades.
Adapted from Sharp, NJH; Wheeler, SJ (2005).
Grades Clinical signs
Grade 1 No deficits, just pain 66-89% resolution of pain 91-97% resolution of pain
Grade 2 Paresis, ambulatory
Grade 3 Paresis, nonambulatory
Grade 4 Paralysis
Grade 5 No pain sensation 7% 60% Ascending myelomalacia in 5-10% dogs
Recurrence
Spinal cord injury can occur from a variety of etiologies ranging from primary trauma, severe intervertebral disc disease and vascular events or more chronic pathologies that lead to fracture /subluxation such as infection (diskospondylitis) or neoplasia. Differentiating these pathologies is often initially identified through signalment, acuteness of the onset, rapidity of the progression and presence of spinal hyperesthesia. Signalment aids in that young dogs are more likely to suffer from infectious/inflammatory disease as opposed to neoplasia which is seen in predominantly geriatric patients. In like kind there are breed predispositions; Chondrodystrophic breeds are predisposed to degenerative intervertebral disc disease and not fibrocatillagenous emboli (FCE). Certain conditions cause more “spinal pain” such as discospondylitis or trauma as opposed to vascular events because the main nociceptors are located in the structures that surround the spinal cord as opposed to the neuroparenchyma itself. Some etiologies are quite acute and improve more rapidly (vascular events) compares to others that are more slow and insidious (neoplastic) Regardless of the etiology, initial triage of these patients should involve rigid stabilization of the entire spine. This is common practice in human medicine but is often overlooked in veterinary medicine because of the presence of compressive myelopathies that do not involve major spinal instability (IVDD). However, should gross instability be present, the risk of iatrogenic injury and worsening of the primary condition is high due to concern of worsening compression of even spinal cord transection. Rigid stabilization involves a backboard and Velcro ties or tape that prevents major spinal movement. It is
recommended that the backboard weight is known and the board be radiolucent so diagnostic can be performed with the patient immobilized. After/during spinal stabilization, systemic evaluation including cardiovascular function should be assessed. Neurologic evaluation is likely to be abridged as proprioception and gait will not be assessed. Nocioceptive function in all limbs can be assessed by pinching the limbs and monitoring for a conscious responseessentially turning around to bite or vocalize at the offender. Withdrawal of the limbs is a reflex and not indicative of conscious perception/spinal integrity. Nociceptive function is considered a prognostic indicator and in its absence outcome will likely be worse. The value of this test is variable based on disease process as varying degrees of injury will cause this change, from temporary nerve injury (neuropraxia) to more permanent damage (neuronotmesis). Cases of IVDD with absent nociception may have a prognosis as favorable as 50% chance return to function compared to traumatic cases where the chances are less than 2%. Cutaneous trunci reflex can be a valuable test in the stabilized patient and in its absence, may reveal the level of the injury. The patients can be gently palpated for the presence of spinal hyperesthesia.
Initial diagnostics generally involve radiographs of the affected spinal cord segments. Sometimes this can be reduced to a certain spinal cord section while in other cases the entire spine must be imaged. When taking radiographs of the spine, a lateral projection with minimal obliquity is the primary radiograph. A VD view may be challenging in the immobilized patient, but horizontal beams views can be acquired. Concurrent radiographs of the thoracic cavity are often acquired to rule out concurrent trauma and as a pre-anesthetic evaluation. Radiographs may reveal fractures or subluxations, neoplastic processes or discospondylitis. Though intervertebral disc disease can be suspected, radiography is inadequate to definitively diagnose it and the site of compression. Vascular events cannot be seen on traditional radiography. Upon confirmation that the spinal column is stable, the patient can be removed from the spinal board. Recommendations at this point will diverge into advanced imaging with CT or MRI vs. supportive care. Variables in this decision will include severity of the neurologic condition, availability of advanced imaging and surgical intervention and financial commitments. MRI is a preferable modality to CT because of tis soft tissue contrast but in its absence CT +/- myelography may be diagnostic. More often than not, decompressive surgery is indicated in these cases.
Conservative care is essentially supportive care as directed medical therapies to treat acute spinal cord have little evidence based support. Though steroids are potent anti-inflammatories and there was a suggestion that hey led to a favorable recovery from spinal cord injury, their use has fallen out of favor. There is no good evidence that steroids improve neurologic outcome in dogs or human patients with acute spinal cord injury. Methylprednisolone sodium succinate has been looked at in several large trials in human patients with acute spinal cord
injury: NASCIS 1, NASCIS 2, and NASCIS 3, Otani in Japan, and Petitjean in France. These were all negative studies. Studies in dogs yielded similar results. Steroids may have utility as an analgesic but should not be considered a variable in return to function. Similarly, polyethylene glycol has minimal evidence to support its use.
Intravenous fluid likely play a positive role in acute spinal cord injury. Maintaining spinal cord perfusion minims local ischemia and furthering inflammation. Bladder management is of major importance. Dogs with loss of inhibition to the bladder will be unable to voluntarily urinate and should be emptied three times per day either manually or by catheterization. This will minimize high pressure within the bladder within the bladder which could lead to permanent loss of detrusor muscle tone (atony). It will also minimize stagnant urine which will increase the risk of lower urinary tract infection.
Rehabilitative techniques serve to improve spinal cord function through neuroplasticity while at the same time maintain muscle strength and joint laxity.
Of course, they should be used conservatively if there is a concern of worsening pathology. Common techniques include water treadmill therapy, electrical stimulation, low level laser therapy and acupuncture. Many spinal cord injuring events can have favorable outcome with supportive care alone. Case selection based on the presumptive diagnosis and disease progression will dictate for which cases this is true.
References
1. Braund KG. Clinical neurology in small animals: localization, diagnosis and treatment. Ithaca, New York: International Veterinary Information Service, 2003.
2. Garosi L. The neurological examination. In: Platt, SR; Olby, N. eds. BSAVA manual of canine and feline neurology (third edition). Gloucester: BSAVA Publications, 2005; 1-23.
3. Garosi L. Lesion localization and differential diagnosis. In: Platt, SR; Olby, N. eds. BSAVA manual of canine and feline neurology (third edition). Gloucester: BSAVA Publications, 2005; 24-34.
4. Sharp NJH, Wheeler SJ. Thoracolumbar disc disease. In: Small animal spinal disorders: diagnosis and surgery (second edition). Philadelphia: Elsevier Mosby, 2005.
Cervical hyperesthesia (painful response to a noxious stimulus) is a common presentation in clinical practice. The causes are variable ranging from benign to sinister. More often, than not, these cases have a positive outcome if the underlying etiology can be identified and addressed.
First, it Is important to recognize the cervical pain is not spinal cord pain. The neuroparenchyma itself has few nociceptors. Pain originates from the structures outside/adjacent to the spinal cord including the annulus fibrosis of the intervertebral disc, the meninges, the periosteum, the nerve roots (radicular), the muscle and the joints. Recognizing where the source of the hyperesthesia emanates from are important for both pathologic understanding and choice of therapeutics.
Dogs with cervical hyperesthesia may have other neurologic deficits but often do not. This is in contrast to thoracolumbar disease which frequently co-presents with proprioceptive or motor abnormalities. The predominant thought is that it relates to the larger canal:cord ratio in the neck than the back. It also speaks to why cervical disease can be much more severe and refractory to medical management when pain is the sole clinical sign.
Identifying cervical hyperesthesia is often as simple as noting a low head carriage at the walk. These dogs often have muscle fasciculations in the neck and shoulders. In more chronic cases, neurogenic atrophy can be noted in the supraspinatous muscles. Lateral motion of the neck may elicit a pain response but in the author’s experience ventroflexion and lateral palpation are most effective. The dogs may be ataxic in all limbs and postural reaction deficits may also be noted. The thoracic limbs may be spastic/hypertonic with normal reflexes in C1-6 myelopathies that have upper motor neuron disease. The limbs are flaccid/hypotonic with poor reflexes and atrophy in C6-T2 myelopathies with lower motor neuron disease. Dogs with C6-T2 myelopathies may also have poor motor component to their cutaneous trunci and Horner’s syndromes.
Several etiologies implicated in cervical hyperesthesia are to follow. Prioritizing the differential diagnosis list is based on a combination of signalment, acuteness of onset, severity of hyperesthesia and progression. From a diagnostic standpoint, cervical radiographs are often non-specific but indicated. They are useful in ruling out traumatic disease or severe discospondylitis and osteolytic neoplastic disease.
With a high prevalence in chondrodystrophic breeds, cervical IVDD is nearly as common as thoracolumbar disease. Although survey spinal radiography may reveal changes suggestive of IVDD, these changes are seen in predisposed breeds and are not indicative of causal pathology.1 Conservative therapy is a combination of supportive care, anti-inflammatories and analgesics. The success rate associated with conservative management of dogs with neck pain only from cervical IVDD is 50–90%, but nearly half of conservatively managed dogs will have a recurrence of clinical signs. Surgical therapy has a >90% success rate and is generally considered a rapid recovery with infrequent complications.
AAS is a relatively frequent cause of C1-6 myelopathies in toy breeds of dogs, although and can occur in any age or breed. In suspected cases, care should be taken with manipulation of the neck. Developmental abnormalities of the dens (hypoplasia or aplasia) or malformations of or trauma to the supporting ligaments are responsible for the development of clinical signs, which results in instability of the atlantoaxial joint and contusion and/or compression of the spinal cord.
Radiographs are often diagnostic for AAS and on lateral projection, an increase in the space between the dorsal arch of C1 and the spinous process of C2 (> 4 mm) is noted. That said, advanced imaging is often recommended prior to surgery because of the high co-presence of craniocervical malformations such as caudal occipital malformation syndrome.
Treatment for the condition is most frequently surgical. Conservative management has a 50% success rate and the challenges of external coaptation near the mouth and around the neck. Surgery can be performed by either dorsal or ventral techniques and is most often associated with a positive outcome.
Cervical Spondylomyelopathy (CSM)-“wobblers disease”.
A bimodal disease that affects either young giant breed dogs or older large breed dogs. The giant breed dogs have an osseous stenosis that causes a dorsolateral compression. Large breed dogs, most specifically Dobermans have a ventral “Disc associated” compressive syndrome. Both of these conditions can be constitutively present or only compressive in dynamic positions (predominantly extension). Survey radiographs are less helpful in these conditions and advanced imaging is indicated. Conservative approaches have been described but this too is often considered a surgical disease with varying reported success rates.
Meningitis/Meningomyelitis
See lecture “CSF-Who, what, when…”
Neoplasia
Any neoplasm that compresses the pain sensitive structures can result in cervical hyperesthesia. There is a high predominance of intradural tumors in the cervical spine including meningiomas and malignant nerve sheath tumors. Soft tissue sarcomas can be causal as can round cell tumors that affect bone such as plasma cell tumors. The tumors can be acute or chronic on presentation based on the affect they have to the vertebral bones. Survey radiographs are considered specific but not sensitive in that over 60% of the bone must be demineralized before radiolucency is noted. Therapies are variable and some tumors may respond to chemotherapeutic (round cell tumors) or radiation therapy (meningioma) while other don’t respond to either ancillary therapy. Surgical therapy is valuable for decompressive and diagnostic purposes but is often not curative in isolation because of the difficulty in attaining complete excision.
Pharmacologic treatment of the patient with neck pain
Adopted from J Rossmeisl DVM, MS DACVIM (SAIM, Neurology)
Tier 1*
Initial therapy
- Mild/moderate pain
Tier 2
Add to Tier 1 agent
- Moderate, severe, or persistent pain
Carprofen 2.2 mg/kg PO q 12 hrs PO, SC
Prednisone 0.5 mg/kg/day PO
Acetaminophen/Codeine Dose to codeine equivalent of 0.5–1 mg/kg q 6 hrs PO
Tramadol 2–5 mg/kg PO q 8–12 hrs PO
Methocarbamol 22–44 mg/kg PO q 8 hrs PO
Diazepam 0.25–0.5 mg/kg PO q 8 hrs PO, IV
Gabapentin 15 mg/kg q 8hrs PO
Morphine
Tier 3
Add to Tier 1 and 2 agents
- Medically refractory pain
Use as initial therapy for severe pain
Oxymorphone
0.25–1.0 mg/kg q 4–6 hrs IM,SC
0.1–0.2 mg/kg q 4–6 hrs IM, IV, SC
Hydromorphone 0.1–0.4 mg/kg q 4–6 hrs IM, IV, SC
* Drug choices in this tier should not be used in combination.







Fred Wininger VMD MS DACVIM (Neurology)
























• 1 in 500-1000 dogs will have idiopathic epilepsy (0.6-0.75% of dogs)
• 10x incidence of human medicine
• An epileptic seizure is clinical manifestation of excessive or hypersynchronous neuronal activity in the cerebral cortex


1.Is this a seizure?
2.Why is this seizure happening?
3.How do I get this seizure to stop? Is this a seizure?








Focal Seizures

Focal Seiz Simple


Starts in motor cortex
Usually lateralized
Normal consciousness
Signs depend upon area











Focal Seizures
Complex
• Arises in limbic areas
• Abnormal behaviors
• Autonomic
• Drooling
• Hippus
• Excessive vocalizations
• Random rapid running behaviors






Generalized Generaliz Seizure

Affects entire cortex
Tonic-clonic
Lasts < 2 mins


Breed Predisposition
•Bulldogs
•Labs
•Dobermans
•Boxers
Avg age of onset 2.5yr
All directions
Distraction abated in 89%







• Royal Canin Ultamino
• Royal Canin HP (Hydrolyzed Protein)
• Purina Dermatologic Management Naturals
• Zonisamide


“Pretenders”
Syncope
Narcolepsy
Vestibular Events
Cramping Syndromes
Myasthenia Gravis
Cervical Pain


The













dogs that should make you skip a beat…
1.Lateralized Forebrain Signs or Behavior changes

The dogs that should make you skip a beat…
1.Lateralized Forebrain Signs or Behavior changes
2.Younger than 1 or Older than 6


The dogs that should make you skip a beat…
1.Lateralized Forebrain Signs or Behavior changes
2.Younger than 1 or Older than 6
3.Middle age Toy Breed Dogs (Female)


The dogs that should make you skip a beat…
1.Lateralized Forebrain Signs or Behavior changes
2.Younger than 1 or Older than 6
3.Middle age Toy Breed Dogs (Female)
4.Concerned owner





THE CATS that should make you skip a beat…
3. How do I get this seizure to stop???

Why bother stopping seizures?
• Primary Dangers
• Primary Dangers
• Excitotoxicity
• Glutamate
Aspartate
Acetylcholine
• Systemic Failure
• “SUDEP”
• Status Epilepticus
• Secondary Dangers
• Kindling and Mirroring

Most important variable?

• Between 20% and 60% of dogs with idiopathic epilepsy (IE) are euthanized as a direct consequence of the disease itself and the side effects of AEDs

¡ Carers had a 40.5% increase in cortisol levels after their dog had had a seizure






• Midazolam>Diazepam
• More potent benzodiazepine
• 5x in humans
• Quicker control and lesser recurrence
• But in Dogs…
• Midazolam shorter T12 and duration of action
• Constant Rate Infusion
• Cat Concerns
• Diazepam long half life and hepatotoxic


Out-of-hospital settings:
1.Intranasal
1.Midazolam dogs & cats
2.Rectal
1.diazepam dogs & cats
3.Intramuscular
1.midazolam dogs & cats
In-Hospital-Setting
Intravenous
Diazepam OR midazolam in dogs & cats
• Intranasal
• midazolam dogs & cats
Intramuscular
Midazolam dogs & cats Midazolam Dosing

• Status epilepticus, in particular, remains a therapeutic challenge in animals with a mortality rate of 25.3%-38.5%
• Status epilepticus: The 5-minute cut-off time
• Cluster seizures are broadly defined in humans and animalsas >2 self-limiting seizures over a period of 24 hours

A BZD bolus should be considered effective if • seizure cessation occurs <5 minutes after administration seizures do not relapse in <10 minutes after cessation. Seizure activity that is controlled with BZDs but relapses within 10-60 minutes may be considered as recurrent SE.
1.First Bolus
2.Second Bolus within 2 minutes
3.Third Bolus within 2 minutes, start CRI
4.Fourth Bolus within 2 minutes and start another agent

…and good long term therapies
• Levetiracetam
• Intravenous (40-60 mg/kg Bolus followed by 20-40mg/kg TID)
• Intramuscular or Rectal
• Cats (IV)
• Phenobarbital
• Intravenous dog (3mg/kg hourly followed by 3mg/kg BID)
• Intravenous cat
• Fosphenytoin
• Intravenous dog when no other options…(15mg/kg)

• Step 1:


• Ketamine IV bolus followed by CRI Dog & Cat
• 3mg/kg Bolus; 0.1-0.5 mg/kg/hr
Increase blood pressure (Ketoflo)
• Dexmedetomidine IV bolus followed by CRI Dog & Cat
• 0.5ug/kg; 0.5-3ug/kg/hr
• Anti-excitatory via sympathetic suppression
• Neuroprotective ( Decrease metabolic demands and Edema)
• Mild Hypothermia











• Step 1:



• Ketamine IV bolus followed by CRI Dose
• Step 2



IV boolus folllow lo ed CR CRI Dog og & Cat
• Dexmedetomidine IV bolus followed by CRI



omiddine IV bolus folloowed w CRI Dog & Cat
• Propofol IV followed by CRI
• Step 1:



V folloowed d b CRI RI Dog D & Cat t BUT BEWARE (HBA)


• 1-6 mg/kg bolus; 0.1-0.6mg/kg/MIN
• GABA A receptors (different site than benzodiazepines)
• NMDA antagonist
kg 0.1.1-0.6mg/kg/ g MIN ( site tha a n ntagonnisist

• Glycine agonist

Calcium channels
• Hemodynamic challenges and loss of gag reflex
channnel e s namic c ch challengees and loss of reflex


• Ketamine IV bolus followed by CRI Dog & Cat
• Dose
• Dexmedetomidine IV bolus followed by CRI Dog & Cat
• Step 2
• Propofol IV followed by CRI Dog & Cat BUT BEWARE
• Step 3
• Pentobarbital IV followed by CRI in Dogs & Cat
• 2-15 mg/kg; 0.2-1mg/kg/hr
• GABA A just like propofol Lots of other neuroprotective effects
• Beware of recovery effects that look like seizures.


• Step 1:
• Ketamine IV bolus followed by CRI Dog & Cat
• Dose
• Dexmedetomidine IV bolus followed by CRI Dog & Cat
• Step 2
• Propofol IV followed by CRI Dog & Cat BUT BEWARE
• Step 3
• Pentobarbital IV followed by CRI in Dogs & Cat
• Step 4
• Inhalant anesthesia in Dog & Cat
• 1-2% MAC



When is it time to stop anesthetic the medications ( Second & Third Line)?
• 12-48 hours
• EEG would be nice…Are they awake?
• One medication at a time.
• In reverse order or administration.
• 25-50% decrease every 4 hours.
• If recur, go back to the previous dose for 6 hours.
• Push multiple long term agents... Don’t forget!

What about clonazepam/clorazepate?
• Severe sedation
• Hepatotoxicity
• Other Considerations
• Additional Doses.
• Imepitoin?


but Goodies… but not great-ies
• Efficacy?
• Time between dose and clinical effect
• Significant expected side effect profile
• Sedation can be Conflicting.
• Catastrophic rare side effect profile
• Narrow therapeutic range.
• COST OF MONITORING

But!!!! Great can be the enemy of good
• Relatively inexpensive
• Efficacy remains better than most.
• “Tried and true”
• Compliance (q24hr to q12hr)
• Veterinary specific products ease administration
• Pro-inhibitory-Synergy with modern medications


Goal is control, not cure
Decrease frequency
Decrease duration
Decrease severity
Decrease post-ictal effects
Avoid serious side effects
2/3 of dogs with IE continue to have seizures
1/3 of dogs with inadequate control
(<50% reduction of seizure frequency) Patterson



Maintenance Anticonvulsant Therapy Maintenance Anticonvuls When to initiate after 1 vu st uls u s ant Therap sa s Seizure?












Maintenance Anticonvulsant Therapy Maintenance Anticonvuls When to initiate after 2 vu nd uls u n nt Th lsan lssa d or 3 t rd Therrapy d Seizure?
















1.Patients with epilepsy caused by progressive etiology or structural lesion (glial scar).
1.Hepatic Encephalopathy
2.Encephalitis or tumor
2.First seizure was Status Epilepticus
1.Exception: Reactive seizure (toxin)
3.Breed at high risk








1.When patient has a certain number or frequency of seizures.
1.More than 1 seizure every 12 weeks
2.Client Preference
Constitutive therapy for life? Kind of primitive
Absorption, Distribution, Metabolism and Clearance

x5=Steady

Phenobarbital
• Barbiturate.
• Most “Powerful” antiseizure medication.
• 83% seizure control compared to 54% bromide (Boothe 2012)
• Certain individual more responsive to one than another.

Phenobarbital
Dosage 3-4 mg/kg PO BID
MOA: GABA agonist (Keeps chloride channels open)-sound familiar?
Kinetics




Inhibit
•Ketoconazole
•Chloramphenicol
Induce
•Barbiturates
•Griseofulvin
•Prednisone
•Rifampin
•Quinidine






T1/2: 34 to 43 h
Therapeutic range: 10-20 μg/ml
Initial dose: 1-2 mg/kg/day
Drug

”Bromism” Bromism



Side Effects

Sedation and Ataxia
Pelvic
PU/PD/PP
Psychosis?
Dermatitis
Pancreatitis
Triglycerides
Be careful of salty diets





They both end
• Compete with Chloride for renal tubular resorption
•
• Saline IVF (48hrs)
• Mind your Chem
• Eosinophilic pneumonitis
• Dry Hacking cough.
• Not dose dependent


Long Term Pro-Inhibitory drugs: Phenobarbital or Bromide?



Phenobarbital id al

Quick onset needed
Frequent adjustments
Renal compromise



History of gastrointestinal disease
Skin disease

More severe seizures or concerns for control
Small dogs





• No side effects, affordable, no monitoring required and effective
• May decrease kindling phenomenon
• Extended release improves dosing
• Renal excretion:
• Rescue liver toxicosis
• Treat Portosystemic Shunt status epilepticus





• Less sedation than full agonist
• Lack of tolerance (think valium)
• Less effective but better tolerated than Pb
• May have partial Ca channel blocking effect Partial BZD agonist
• Decreases seizure onset
• enhanced sodium channel inactivation
• enhanced GABA activated chloride conductance
• Decreases seizure spread
• Reduced glutamate-mediated excitation
T1/2
• 2-4 hours
Metabolism/Excretion
• Low rate of hepatic metabolism
• Both unchanged topiramate and its metabolites are excreted mainly by the kidneys

• Side Effects
• Sedation and weight loss

Emergency Seizure Management
• In recent studies elevations in liver enzymes were appreciated, but patients were also receiving phenobarbital so unknown if secondary to phenobarbital or the topiramate
• Dose
• 5-10mg/kg PO BID
• Blood Levels
• Not established at this time n ut bital so nobarbital or


Clifford F. Shipley, DVM, DACT
Emeritus Associate Clinical Professor
Retired Animal Plumber University of Illinois cshipley@illinois.edu
• Nodaway, Iowa
• Deer hunting @ 12: bow, shotgun
• Northwest Missouri State University
• Iowa State University
• Practice
• Virginia-Maryland Regional College of Veterinary Medicine
• ASDIC, Ltd., Manager
• Yoder Feeds, Technical Services
• University of Illinois, College of Veterinary Medicine
• Attending Veterinarian for Agricultural Animals
• Exotic/Non Traditional Species/ Alternative Livestock
• ILDFA, NADeFA, AASRP, IL Livestock Advisory Board
• Raise deer (mule deer, WTD, wapiti)
“Expert”
• 1. Very skillful; having much training and knowledge in some special field.
• 2. A guy far away from home with a box of slides.
• 3. A “person” far away from home with a computer and a projector.
• 4. My wife is not around***

• Colorado 1967
– “wild” deer elk used for research in Foothills Wildlife Research Facility, Fort Collins
• TSE status in 1978
• Wyoming Sybille Wildlife Research Facility 1979; captive elk
• Colorado wild elk 1981
• Colorado mule deer 1985
• Widespread testing
• Meetings
• Rules
• Regulations
• Fear
• Accusations

• State and Federal Action and Funding
• Wyoming: wild mule deer 1985
• Saskatchewan: captive elk 1996
• South Dakota: captive elk 1997
• Oklahoma: captive elk 1998 (from MT)
• 1999
– NE: wild mule deer
– MT herd destroyed
• 2000: wild Saskatchewan mule deer
• 2001: SD WTD; NE captive WTD
• Prion Disease
– “is an infectious agent composed of protein in a misfolded form.”
–"Chronic Wasting Disease Alliance (www.cwdinfo.org)"
– Other “prion” diseases
• Scrapie
– (sheep and goats)
• Bovine spongiform encephalopathy
– cattle
• Mink encephalopathy
• Humans
– Creutztfelt-Jakob(CJD)
– Variant Creutzfelt-Jakob(vCJD)
– Familial Creutzfelt-Jakob(fCJD)
– Sporadic Creutzfelt-Jakob(sCJD)
– Gerstmann-Straussler-Scheinkersyndrome (GSS)
– Fatal familial insomnia (FFI)
– Kuru
• Ostrich (non infectious)
• Cat (feline spongiform encephalotpathy(FSE)
• Nyala, oryx, greater kudu (exotic ungulate enephalopathy) EUE
• Spirochete
• Mineral deficiency
– Cu
– Others?
• Virus
• Bacterial

• Multifactorial (requires agent + genetic susceptibility: scrapie)
• Other???
• “protein”
• Not bacteria, virus, fungus, etc.
• May bind with soil particles
• Resistant to sterilization
– Heat, radiation, formalin, proteases
– Dependent on protein hydrolysis
• Bleach, caustic soda, acidic detergents
• Ozone, pressurized steam
• Been here all along theory
– Didn’t test for it
– Didn’t recognize disease symptoms
– Didn’t understand epidemiology/biosecurity
– Increased testing
• Jumped specie theory
– Colorado research: scrapie?? Other??
– Then dispersed thru sale and transfer of animals
• Spontaneous theory
– Mis-folded protein
– Genetic
• Other?

• Scrapie: genetic link
• Elk: genetic link
• Human: genetic link
• WTD: ?
• Moose: ?
• Red deer: ?
• Reindeer?
• Mule deer?

• White-tailed deer, mule deer, elk (wapiti), red deer, moose, black-tail, Columbia, sika, reindeer
– Ataxia
– Dementia
– Weight loss
– Behavioral changes
– Pneumonia
– Death

• Oral
– Feces
– Urine
– Saliva
– Muscle
– Nervous tissue
– ???
• Experimental infections
– injection

Get Well Soon
• Grooming
• Mineral licks
• Feeding stations
• Social animal
– Family groups
– Habitat
– Bedding areas
• Migration

– Elk: long migration routes, wintering areas
– deer: migration, rut, dispersal

• Deer eat bones/gut piles of dead deer
• Scavenger theory:
– Crows
– Coyotes
– Other
– Man
• Transport of infectious material
• Taxidermy
• Improper handling/disposal of infectious material
• Wild carcass transport and disposal
– Composting
– Distribution to zoo/captive animals



• Korea
– Imported from US/Canada
– Animals and velvet antler market
• Northern Europe
– Reindeer
• Speculation of source?
• Spontaneous?
• Genetics?
• Brain sampling
– Obex (brain stem)
– Histology
– Immunohistochemistry (IHC)
• Lymph nodes
– Retropharyngeal
– Others?

• Other tests
– Rectal biopsy
– Serology
– Third eyelid
– PCR
– Tonsilar biopsy
– RTQT
– Ear punch
– Blood test???

• NONE
• Speculation if other etiologies
– Antibiotics
– Mineral supplementation
– Anti-inflammatories
– Humic Acid

• Newest craze
• What is humic acid
– Humicacid is a group of molecules that bind to, and help plant roots receive, water and nutrients. High humicacid levels can dramatically increase yields.
– The best source of humicacids are the sedimentation layers of soft brown coal, which are referred to as Leonardite
• Source: mined, New Mexico
• Use:
– Feed: 20-40 lb per ton
– Water
– Soil amendment around high traffic areas
– Pasture: 200-400 lb per acre
– Mineral
– Treat LN and obex samples???
• Movement
– Animals
• Source
• Testing
• Monitoring
– Carcasses
– Taxidermy
– Scavengers
– other

• Vaccination
– University of Saskatoon
– Clinical trials currently underway
• Canada
• US
– How do you deliver to wild populations?
• Oral
• Dart
• Water
• ????
• USDA: “program” standards
– Set rules and regulations for producers and states to follow
– Minimum standards
– States can implement more rigid standards
• Double fencing
• Distance from wild or farmed cases
• other
Genetic selection:
• Evolutionary
• Controlled biological testing
• Dr. Chris Seabury
• Dr. Nick Haley
• North American Deer Registry
• Genetic type delays clinical signs
• EBV of 81% accuracy?
• PRNP prion locus affects encoding PrP proteins
– Whitetails
• H95 animals lived approximately 1,500 days
• S96 ~ 1,000 days
• Q95, Q96 < 550 days
– Mule deer
• 225SS lived 30X longer than 225SSF
• Canadian Wildlife Federation
– Dr. Paul James
• Societal questions
– Perceptions:
• “Zombie Deer Disease”
• Kill all the deer
• Unsafe to consume/hunt
– Reality ????
• Studies to date
– NO
– Eating venison
• Bone out
• Stay away from brain, LN and nervous tissue
• No cases in 50 + yrs of monitoring
– Macaque paper?
– CDC recommends not eating positive animals
– Swine ????
– Alternative Livestock Industry
• Impact
• Social and economic
– Conservation/Wildlife
• Deer populations
• Hunter participation and recruitment
– HSUS/PETA: anti-hunting and anti-animal agriculture
– Resources
• Limited
• Impact
• Only affects certain cervidae species
• Does not affect other livestock
• Does not affect man
• Can not eradicate
• Endemic
• Spreading
• Federal and State Programs in place
• Does not affect populations?
– Cervid repro biology 101








• Fowler
• Safe-Capture International
• AASRP
• Trial and error
• Extrapolation of data
• Meetings
• NaDEFA
•Other “experts”, “Deermail”

• World:
1.Velvet
2.Meat
3.Game farms
4.Hobby
5.Urine production

• Sustainable agriculture
• Ecological agriculture (organic farming)
• Diversification
• Smaller land base
• Rural economic benefits
• Hobby
• Breeding stock
• Venison
• Antlers
• Hunting
• Other products
Urine
Tail gland
Penis
Flexor tendons
• Health
• Management
• Nutrition
• Food safety
• Genetics
• Reproduction
• other

All cervids are not created equal!!!
A deer is not a deer!

• Chronic Wasting Disease Monitoring
• Tuberculosis Testing
• Brucellosis Testing
• Health Programs
• Assisted Reproduction
• Identification
• Movement
• Deantlering
• Etc.

Health
• Parasites: internal/external
• Vaccination programs
• Disease monitoring
CWD
Brucellosis
Tuberculosis
Johnes’ lice


• Safety: human and animal
• Hard vs velvet
• Anesthesia
• Cut above pedicle/burr
• Do other procedures @ same time



• MCF – Sheep – Goats?
– Fatal







Fatal
Culicoides
Vaccine
Vector control









• Nutritional monitoring
Copper
Selenium
Protein
Others
• Tranquilization and capture
• Medication
• Most important factor in disease management
• 12-24 hours post birth
• Antibodies to diseases of the dam
• Vitamins
• Minerals
• laxative

• Clean environment
• Disinfectants
• Dry
• Ventilation
• Pens
• Bottles
• Equipment

• Groups ???
• Individual housing ??
• Hand rearing
• Bucks
• Does
• Pritchard Nipple
• What is your goal?
• Water
• Protein (18-20%)
• Free choice hay/forage
• Pellets
• Antibiotics
• Anticoccidial
• When to offer ?
• Species specific ??
• Amount : 10-20% of body weight per day
• Frequency: ???
• Quality
• Antibiotics
• Anticoccidials
• When ??
• Feed
• Water
• Pens
• Individual

• Bacterial
• Viral
• Parasites
1.coccidia
2.Cryptosporidia
3. “worms”

• Sanitation
• Ventilation
• Colostrum
• Antiparasitic drugs to the milk/replacer
• Antibiotics to milk/replacer
• Vaccination: Clostridium perfringens AC & D
• Antitoxin/ antiserums
• Early!!!!
• Fluids: calf electrolytes
• Antibiotics: SMZ-TMP, Nuflor, etc.
• Antiparasitic drugs: Deccox M/Corid/Marquis
• Milk/replacer
• Antiinflammatory drugs (flunixin meglumine)
• Early !!!
• Injections
• Oral/Milk/ replacer
• Antibiotics
• Antiinflammatories (Flunixin meglumine)
• Isolation from others
• Clostridium perfringens A ??
• Overeating
• Overfeeding
• Wrong or inappropriate replacer
• Dirt??? Management
• Facility design
• Handling
• Behavior
• Feeding
• Genetics





















• Semen collection and freezing
• AI
• Synchronization programs
• Pregnancy diagnosis
• Embryo transfer
• Conservation of endangered species
• Federal regulations
• State regs: vary from state to state
• Three to five year monitoring status
•“Free states”
• Positive states
• Monitoring program
• Samples

TB testing
Mid cervical

• Certification for testing
• Cervical testing
•“Reactors”
• Testing accuracy
• New blood test
• Reindeer: do only in winter?
• Greater Yellowstone Area
• Most states free
• Whitetail do not get brucellosis?
• Some states still require negative test or herd to be on program
• Accurate test
• Blood sample

• Vaccinations?
– Clostridiums: tetanus, C& D, A etc.
– Leptospirosis: 5 strains?
– IBR, BVD, PI3 ?
– E. coli ?
– West Nile Virus: reindeer
– Epizootic Hemorrhagic Disease
– Other ????
• Nutrition
– Protein
– Phase feeding
– Minerals
– Purchased vs. home made
– Forage
• Browsers
• Grazers
• Selective
– Monitor
• Parasites
– Internal
– External
– Dewormers: Extralabel
• Avermectins: Cydectin d.o.c. pour on?
• Benzamidazoles: 2X fenbendazole?
• Levamisole
• Pyrantel
• Etc.
– Use ruminant dose, albendazole during pregnancy can cause birth defects
• Specific Diseases
– Johnes
– Scours
E. Coli
Coccidiosis
Rota
Corona
-Pneumonia

-Epizootic Hemorrhagic Disease
-Maligant Catarrhal Fever
• Do No Harm!!?
• Tame vs. Wild
• Water treatment
• Feed
– Bread
– Apples
– Bananas
– Other treats

• Parental
– Long acting preps if possible: Nuflor, Micotil?, LA200, Tetradure, Benz Pen, Excede, Draxxin
– None approved: extra-label
– Irritating
– Viscosity of drug
– Make animal wild(er)!!
• Artificial Insemination
– Synchronization programs
– Cervical/Transcervical AI
– Laparoscopic AI
• Semen collection/freezing
– Live: anesthesia/restraint
– Dead/hunter harvest
• Microchipping: base of left ear
• State/Federal tag(s): right ear
• Feeder Pig tags/Swine tags
• Tattoos
• Elk require two traceable forms of ID in some states
• Movement of cervids: health papers
• CWD program
• Sale
• Transport
• Health regulations
– CALL
• Tranquilization?


• Tranquilization
– Pole syringe
– Dart gun
– Hand injection
– Blow gun
– Water meds
– Feed meds

• Xylazine: can dehydrate to 450 mg/ml for dart gun use
– 100 mg/ml
– 20 mg/ml for dilution/topping off darts, sensitive species
– Can reverse with tolazoline, yohimbine, atipamazole
– Approved for cervid use
• Use in combination with xylazine
• Can concentrate to 180-200 mg/ml
• 100 mg/ml
• Controlled drug
• Must wait 40 minutes to reverse????

• BAM (butorphanol/azaperone/medetomidine
• MK
• MK2
• Nalamed(not controlled drug) Nalbuphine/azaperone/medetomidine
• other
• Facilities
• Personal/personnel limitations
• Value of the animal
• Weather
• Reason(s) for procedure
• Stacking procedures to limit number of times to handle animal
• Temperament of the animal
• Level of excitement
• Degree of restraint prior to sedation
• Working time for procedure
• Level of anesthesia for procedure
• Predation
• Social hierarchy
• Time
• Materials
• Trip
• NEVER GET IN A HURRY !!!
• Hazards
• Medication availability
• Personnel safety
• Volume restrictions
• Cost/benefit

to Start
• Challenge
• Client demands
• Extra source of income?
•Doesn’t require much equipment
• Rewarding
• Expectations of client are low!!


Robert Van Saun, DVM, MS, PhD, DACT,
Background
Robert J. Van Saun, DVM, MS, PhD, DACT, DACVIM (Nutrition) Department of Veterinary & Biomedical Sciences
Pennsylvania State University University Park, PA 16802
Though most microminerals account for a small portion of the total consumed diet, they play many important biochemical roles in the body. Copper (Cu) is an essential micromineral required by all small ruminant species to maintain normal body functions. However, Cu nutrition is a double-edged sword being associated with both deficiency and toxicity disease concerns with much variation among the small ruminant species. Although all microminerals are of importance, Cu is receiving more attention as a result of the potential toxicity concerns with sheep, llamas, and alpacas and for deficiency issues in goats (NRC, 2007) There is evidence of increasing Cu content in forages and feeding with other copper-containing supplements (grains and mineral) may predispose animals to a greater risk for toxicity problems. The objective of this presentation is to provide an overview of Cu nutrition by describing biologic functions and associated deficiency and toxicity disease conditions in small ruminants Additionally, Cu requirements, assessment of Cu status, and dietary supplementation practices, especially concerns relative to toxicity risks will be addressed
Biological Roles
Essentiality of Cu in animals was not discovered until 1928, though it had been discovered in animal and plant tissues much earlier. Copper performs many essential roles in the body as a component of various proteins (e.g., metalloenzymes) that require Cu to sustain their biologic functions (McDowell, 1992; Suttle, 2010) Some examples of Cu metalloenzymes include ceruloplasmin, tyrosinase, lysl oxidase, cytochrome C oxidase, and superoxide dismutase. Through the action of these metalloenzymes, Cu has been associated with iron regulation and red blood cell function, cellular respiration, bone and connective tissue formation, hair pigmentation, nerve tissue and cardiac development, and immune function.
Ceruloplasmin is a blood protein with multiple functions and contains seven copper atoms, thus accounting for a majority of copper in blood. Ceruloplasmin converts stored iron (+2) into the ferric (+3) state to be incorporated into hemoglobin or myoglobin for oxygen transport. Ceruloplasmin is a liver generated acute phase protein with an important role in the non-specific immune response and its blood concentration will be elevated in response to an infectious agent. Functional activity of most cell types responsible for the various immune system responses are influenced by Cu through superoxide dismutase activity.
Of interest to fiber producing small ruminants, Cu plays an important role in fleece coloration and quality. Tyrosinase (polyphenyl oxidase) is the enzyme responsible for the formation of melanin, a pigment responsible for hair and skin coloration. Hair or fleece would appear lighter in color or “bleached out” without the presence of melanin. Cross linkages of disulfide groups within the keratin structure of hair provide the physical properties of fleece and are dependent upon Cu Wool from sheep with copper deficiency are described as having “steely wool” where the crimp has been lost and the fiber is straight.
Normal development of bone and connective tissue is dependent upon the copper-dependent enzyme lysl oxidase. This enzyme is responsible for modifying specific amino acids within the collagen protein structure that facilitates cross linkages between collagen fibers within connective tissue. These cross linkages impart properties of rigidity or elasticity to the collagen structure. Rigid connective tissue provides the scaffolding for mineralization in the development of bone. Elastic properties of collagen are
seen in the large blood vessels such as the aorta, which must withstand wide fluctuations in pressure in circulating blood
The cell’s ability to generate energy through the transfer of electrons to the final receptor oxygen to form water is one of the functions of cytochrome C oxidase. Integrity of the nervous system is dependent upon the specialized phospholipid coating (myelin) around nerve fibers facilitating transmission of nerve signals. Myelin formation in the brain and spinal cord is related to cytochrome C oxidase activity. Besides the structural effects on nervous tissue, Cu is linked to nervous and cardiac tissue communications through its effect on production of neurotransmitters and heart muscle fiber (myofibril) development. Both cytochrome C oxidase and dopamine-β-monooxygenase are responsible for these biologic functions of Cu.
With the number of biological functions attributed to Cu, a spectrum of disease entities has been associated with a deficient nutrient status. A common Cu deficiency disease occurring in a wide range of animals is anemia. Anemia can be characterized by the size and pigment (hemoglobin) content of red blood cells. In older ruminants, Cu deficiency can induce a macrocytic, hypochromic anemia due to low ceruloplasmin activity, whereas in lambs the anemia is characterized as microcytic and hypochromic (Suttle, 2010). In this clinical disease the activity of ceruloplasmin is significantly compromised preventing stored ferrous iron from being oxidized to the ferric form and incorporated into hemoglobin in the developing red blood cell.
Copper deficiency has been associated with neurologic degeneration in sheep and goats as a result of abnormal myelin formation with resulting disease signs of muscular weakness of the legs and ataxia (Suttle, 2010; McDowell, 1992). Presenting signs in the affected animals included hind limb ataxia, paralysis or head tremors. This condition can occur at birth or a few months after birth depending upon the severity of copper deficiency in the dam in transferring copper to the fetus. Cardiovascular disease and rupture of major blood vessels has also been associated with copper deficiency; often seen as acute deaths. These disease conditions are associated with reduced cytochrome C oxidase activity.
Achromotrichia (loss of hair/wool pigmentation) and fleece structural changes is seen in sheep and other species with Cu deficiency. This is often first seen in Cu deficient cattle. The lack of pigmentation is due to reduced activity of tyrosinase enzyme. How body Cu is partitioned to these various enzymes and how enzymatic activity is progressively lost in the face of Cu deficiency resulting in these different clinical diseases is not known.
The disease conditions discussed thus far are classified as clinical disease syndromes. Clinical disease is characterized as the “classical” disease processes associated with a specific nutrient. In contrast to clinical disease is what is termed subclinical disease. Subclinical disease is described as non-specific consequences of a nutrient being marginally deficient or toxic. Subclinical Cu deficiency is associated with impaired immune response and greater susceptibility to disease, reduced reproductive fertility, and poor growth or lactation. A common presentation in sheep and goats being recognized with low copper status is abortion, stillbirth, or weak neonates. These cases have been mostly associated with situations of induced copper deficiency status from excess molybdenum, sulfur, and iron in the diet. These cases have been recognized relative to low hepatic copper status on necropsy. Clinical disease is more readily identified but is not near as prevalent as subclinical disease. With difficulties in assessing Cu status using blood concentrations, subclinical disease becomes a difficult process to diagnose.
Sheep are well known to be extremely sensitive to excess dietary Cu (>10 mg/kg) in contrast to the case with goats (Suttle, 2010). Copper toxicity is the result of the highly reactive nature of the Cu ion when not
protectively bound in tissues or blood (NRC, 2005). Copper like most minerals is a strong oxidizing agent that can damage cellular membranes and proteins. In most situations Cu toxicity is a progressive disease process where excess dietary Cu accumulates in the liver until it becomes saturated. The liver is the primary mineral storage organ of the body and contains special protein molecules capable of binding minerals and keeping them isolated from doing any damage to the surrounding tissues. Stored Cu is inefficiently excreted through bile produced in the liver and transported to the intestinal tract to be lost in fecal matter. The ability to excrete Cu is species dependent and accounts for the observed differences in sensitivity to Cu toxicity. Once the liver has become saturated with stored Cu, excess will spill out into the liver and blood reeking oxidative havoc.
Clinical Cu toxicity in sheep is characterized by hemolysis due to oxidative damage from the Cu ion released into the bloodstream. With hemolysis there is leakage of free hemoglobin into the blood (hemoglobinemia) and urine (hemoglobinuria) Hemoglobin in urine will induce damage to the kidneys. The hemolytic crisis stage of the disease is nearly always fatal. The disease process is slightly different in goats as the “hemolytic crisis” has not been as readily reported or seen in field cases. The common theme in goat Cu toxicity cases is the documentation of severe and widespread degenerative changes (necrosis) in the liver. This is a different process than hepatic lipidosis (fatty liver). Liver necrosis may or may not be associated with elevated blood enzyme activities assessing liver function.
Typically blood and kidney Cu concentrations are not highly elevated until the final initiation of the disease process; therefore, they may not be useful in diagnosing potential risk. Additionally, kidney Cu concentrations are only determined in animals that have died. The difficulty in dealing with this disease is that animals may only show minimal signs of poor doing prior to the final demise. Stress factors or previous liver disease may precipitate the disease.
Copper Availability and Requirements
Defining a “true” requirement, meaning how many milligrams (mg) per day to support a given physiologic state, for a trace mineral is difficult at best. Often a trace mineral requirement is described in terms of dietary concentration, namely parts per million (ppm). Ideally a trace mineral requirement would be defined in terms of how many mg of mineral was needed to support specific physiologic states such as maintenance, pregnancy, lactation, growth, and work/activity. Obviously to determine such needs, specific feeding trials must be completed. The recent National Research Council (NRC) publication for small ruminants has defined specific mineral requirements for sheep based on factorial models and for goats based on dietary concentration (NRC, 2007). For sheep the suggested dietary Cu concentration ranged from 5-8 mg/kg, while for goats the recommendation was 15-20 mg/kg. Clearly, mineral products cannot be formulated to meet the Cu requirements of both species appropriately.
The NRC sheep models calculate trace mineral requirements based on “available” mineral and not “total” mineral in the diet. This accounts for differences in digestibility and absorption of different feed ingredients that provide some level of mineral. Minerals from forages are less available due to their association with plant cell wall components. Compounds such as oxalates and phytates in forages can bind minerals reducing their availability. Copper availability in fresh pasture is lower than from hay (Suttle, 2010). When the plant is harvested some breakdown of compounds facilitates the release of Cu making it more available. Inorganic mineral sources generally have higher availability as mineral sources and grains are somewhat in between these values. These data on mineral availability from various feed ingredients are not completely known but this is a much better approach to more accurately define requirements. In the case of goats, the dietary concentration requirement does account for an “averaged” availability assessment. In the case of sheep diets, Cu availability ranges from 4.5% (high forage diets) to 6% (higher grain diets) under low dietary molybdenum (<1 ppm) and sulfur (<0.22%) conditions. Availability will need to be adjusted for diets outside of these conditions.
As with many other minerals, there are many documented interactions between minerals that can alter availability. Relative to Cu, high dietary iron (Fe), zinc (Zn), and calcium (Ca) can reduce Cu availability (Suttle, 2010) Iron is high in soil and soil consumed by grazing animals may contribute to the observed lower Cu availability from pasture. Interactions affecting Cu availability have been well studied as a result of a unique situation in ruminant animals. Bacteria in the fermentation vat can facilitate the combination of dietary molybdenum (Mo) and sulfur (S) to produce thiomolybdate compounds. These thiomolybdates chelate or bind Cu in the fermentation vat and prevent Cu from being absorbed in the intestine. Even if absorbed, the chelated Cu is not available for use by tissues. For any ruminant animal, including llamas and alpacas, availability of dietary Cu will be significantly influenced by dietary Mo and S content. In this regard, often the Cu requirement is defined relative to dietary Mo as a Cu-to-Mo ratio. For sheep and camelids that are more sensitive to Cu, a suggested dietary Cu:Mo ratio of 6 to 8:1 is recommended. For goats and cattle, a Cu:Mo ratio of 6 to 10:1 is recommended. A Cu:Mo ratio of 16:1 or greater is often associated with Cu toxicity problems (Pugh, 1993).
With the requirement numbers presented, one needs to provide sufficient amounts of Cu from the diet without greatly exceeding this requirement and potentially inducing toxicity. The challenge here is remembering dietary Cu is contributed by every ingredient fed to some extent. This is where many people become confused with the daily Cu requirement on a dietary concentration basis ranging from 5 to 20 ppm. However, many feed ingredients can contain much higher Cu content, for example mineral supplements might contain between 30 and 600 ppm Cu. Does this mean these feed ingredients are toxic? Possibly, but only if they were fed as a sole feed source (not practical or realistic) or in combination with other feed ingredients with high Cu content. Each feed ingredient will contribute to the overall total dietary Cu content, but only to the proportion of the total diet the individual feed represents.
In Table 1, a number of examples are provided to demonstrate the concept of ingredient contribution to dietary Cu content. For these examples, three feed ingredients (hay, grain, and mineral) comprise the total diet. The same amount of hay (3.25 lbs/day), grain (0.5 lb/day), and mineral supplement (0.015 lb/day or 0.25 oz/day) are provided in each example for simplicity and only Cu content is varied. In these examples it can be seen that hay provides the largest amount of dietary Cu even though it has the lowest Cu content. This is a direct result of hay being the largest proportion of the total diet. Example 1 shows Cu intake (18.0 mg/day) and dietary content (10.5 ppm) are in line with estimated requirements (14.8 mg/day; 10 ppm) for the defined animal (see table legend). In example 2, the grain Cu content is increased from 20 to 40 ppm, yet dietary Cu intake and content are not greatly increased, but certainly higher. Some are concerned about the Cu content of the mineral supplement, yet example 3 shows the mineral Cu increased from 30 to 100 ppm, but Cu intake is reduced only by 0.5 mg/day. Of greatest concern is the situation in example 4 where hay Cu content increases from 9 to 15 ppm. In this situation, daily Cu intake and dietary content is greatly increased and, depending upon dietary Mo status, could potentially lead to Cu toxicity problems. Hay Cu content typically is between 4 and 14 ppm, though much higher Cu concentrations are being observed more frequently in many regions of the U.S. High forage Cu content may be the result of inappropriate fertilization practices, especially if poultry or pig manure are used. Dietary Cu is very high in poultry and pig diets, which accounts for the higher manure Cu content. Another concern is the use of copper sulfate footbaths on dairy cattle farms and the spread of this material on croplands. Given these situations, it is important for you to know just how the forages you purchase are raised or you need to test your forages to assess Cu status.
Given these dietary examples, it is imperative that all potential sources of Cu be accounted for in the diet to ensure adequate, but not excessive, Cu is consumed. Additionally, use of copper oxide wire particle boluses for Hemonchus contortus control need to be included in contributing to dietary Cu absorption. These boluses can provide substantial Cu over a period of 6 months. Multiple bolus administration can result in providing excess Cu and inducing toxicity. As previously described, dietary Mo is an important
factor to address in assessing dietary Cu status. From these examples both dietary ingredient Cu content and intake amount need to be considered. If testing feed ingredients for Cu content, one should also have Mo and S content determined. In feeding appropriately for Cu, one should first evaluate forage Cu content then match pellet and mineral supplement accordingly. It must be remembered that high dietary Cu intake does not guarantee that a toxicity event will occur. Most reported toxicity cases are associated with dietary Cu content exceeding 25 to 30 ppm and a high (>16:1) Cu to Mo ratio.
Table 1. Contribution of individual feed ingredients (hay, grain, mineral supplement) to total dietary copper (Cu) content. For comparison in the following examples daily total Cu requirement for a 150 lb adult sheep in late pregnancy with twins is 14.8 mg/day. Dietary Cu content can vary from 9 to 12 ppm assuming a total intake of 1.5 and 1.25% of body weight, respectively.
With concerns for disease related to either Cu deficiency or toxicity, methods to assess Cu status are of interest. Copper can be directly determined in serum, plasma, or liver samples. Serum or plasma Cu concentrations are most easily obtained and determined, though interpretation relative to dietary status is confounded. On an individual basis, only very low (<0.1 µg/ml) or very high (>5 µg/ml) blood Cu concentrations are truly diagnostic. Values within the normal reference range (0.6 to 1.0 µg/ml) could also be associated with marginally deficient or excessive dietary Cu intake. Work evaluating the potential of serum Cu concentrations show there is a flock-based nutritional component (Herdt and Hoff, 2012). Based on this work at least 10-12 samples of individuals within a defined group are necessary to evaluate Cu status. You would want to evaluate absolute values relative to the reference range, but also consider the percent of samples < 0.3 µg/ml and > 2 µg/ml to evaluate risk of deficiency or toxicity, respectively.
Liver Cu concentration is considered the best measure of dietary Cu status but requires a liver biopsy to obtain a sample. If an animal dies from unknown causes, a sample of liver and kidney should be obtained for Cu concentration determination. Liver Cu concentrations below 25 ppm (dry weight basis) or above
500 ppm (dry weight basis) are suggestive of deficiency or toxicity, respectively. Kidney Cu content is the best determinant of Cu toxicity and should be the preferred sample for diagnosis along with liver. Normal kidney Cu content is usually low and any values > 10 µg/g dry weight (10 ppm) are considered to be diagnostic of Cu toxicity.
Beyond Cu concentration determinations, Cu status can be assessed by measuring activities of Cu-specific enzymes. Ceruloplasmin activity in blood is a measure of Cu status, but it is influenced by infectious conditions, thus confounding their interpretation. Whole blood super oxide dismutase enzyme activity has also been associated with Cu status, though this enzyme is also influenced by zinc status. Enzyme activities are not very sensitive to dietary changes as their activities are highly conserved by the body in the face of deficiency. They also do not reflect toxicity situations. Availability of laboratories capable to measuring these enzymes and having reference values for sheep and goats are limited. At this point, serum Cu concentration should be used as a screening tool to assess Cu status. This measure should be evaluated in conjunction with dietary Cu and Mo content.
One of the most difficult aspects of Cu nutrition is addressing the situation of Cu toxicity in a group of animals once a diagnosis has been made. There are some who believe it is difficult to release liver Cu once it has accumulated and the animal at risk of clinical toxicity. Certainly, this is a frustrating situation to manage. Historically, recommendations have been to administer ammonium molybdate (100 mg) or sodium thiosulfate (1 g) drenches or as a dietary supplement daily for 3-6 weeks (Hidiroglou et al., 1984). A chelating agent, D-penicillamine (26 mg/kg orally twice daily for 6 days), has been used but is very expensive. Response to these treatments is equivocal as it is focused on binding Cu in the rumen or blood. A key to dealing with toxic Cu accumulation in the liver is to place the sheep or goats on a copper deficient diet to force mobilization of liver Cu reserves. Remove all copper sources and provide dietary sources of molybdenum and sulfur to ensure very low dietary Cu absorption. Suttle (2012) published a method of inducing Cu depletion in sheep by lowering dietary Cu content and feeding Cu antagonists. Following this period, the sheep were placed on a low Cu diet and supplemented with calcium sulfate in the diet. Duration for reducing hepatic copper was approximately 22 weeks.
Summary
Copper is an essential micromineral for all small ruminant species, though differences in the species Cu requirement results in differential risks for deficiency or toxicity disease. Sheep and camelids are more prone to copper accumulation from an over supplemented diet thus predisposing them to greater risk for toxicity problems. Goats have a much higher tolerance for Cu and have higher requirements compared to other small ruminants and are more prone to present with deficiency disease. A common problem in the feed industry is the lack of recognition for the difference in copper requirement between sheep and goats with many products labeled for their use being formulated for low Cu content relative to sheep requirements. Proper Cu dietary supplementation requires that all feed ingredients be analyzed not only for their Cu content, but the content of important interfering substances to Cu availability such as iron, molybdenum, and sulfur. Ongoing monitoring of animal Cu status is a necessary component of a small ruminant health program.
References:
Herdt TH, Hoff B. The use of blood analysis to evaluate trace mineral status in ruminant livestock. Vet Clnics NA:Food Anim Pract 27:255-283, 2011.
McDowell LR: Minerals in Animal and Human Nutrition, San Diego, CA, Academic Press, 1992, pp 176-204.
National Research Council: Mineral Tolerances of Animals, ed 2. Washington, DC, National Academy Press, 2005.
National Research Council: Nutrient Requirements of Small Ruminants, Sheep, Goats, Cervids, and New World Camelids. Washington, D.C., National Academy Press, 2007
Pugh, DG: Copper nutrition in llamas. Llamas 7(2):77-79, 1993
Suttle NF: The Mineral Nutrition of Livestock, ed 4. Cambridge, MA, CAB International, 2010, pp 255305.
Suttle NF: Control of hepatic copper retention in Texel ram lambs by dietary supplementation with copper antagonists followed by a copper depletion regimen. Anim Feed Sci Tech 173:194-200, 2012.
Hidiroglou M, Heaney DP, Hartin KE: Copper poisoning in a flock of sheep. Copper excretion patterns after treatment with molybdenum and sulfur or penicillamine. Can Vet J 25:377-382, 1984.
Robert Van Saun, DVM, MS, PhD, DACT,
Robert Van Saun, DVM, MS, PhD, DACT, DACVIM (Nutrition) Department of Veterinary & Biomedical Sciences
Pennsylvania State University
Introduction
Nutrition-associated diseases are a common issue in small ruminants (i.e., sheep, goats, camelids). Unfortunately, the veterinary curriculum is too often devoid or limited in providing any detailed information on addressing nutritional issues. Small ruminant producers/owners occupy a unique niche in veterinary practice that can frustrate the practitioner due to their lack of use of veterinary services, high emergency call rate, or insufficient economy of scale to support appropriate herd health services. Recognizing feed costs account for the greater proportion of production costs in any small ruminant enterprise, there is an opportunity for the nutrition-savvy practitioner to provide some preventive services. To get to this level of nutrition support one needs to understand common nutritional diseases of small ruminants This presentation will provide a practical perspective on common nutritional diseases encountered in managing sheep, goats, and camelids
Pregnancy toxemia is the single most important nutritional disease of sheep and goats. Too often the outcome is devastating with loss of the dam and fetuses. This disease can be easily managed once one understands the underlying aspects of this metabolic disease Simply, pregnancy toxemia is a disease where glucose homeostasis is disrupted due to an inability of the dam to maintain sufficient glucose status (e.g., negative energy balance) in support of her maintenance and pregnancy requirement. The fetus and associated uterine and placental tissues are a considerable consumer of maternal glucose, approximately 50% of the dam’s circulating glucose. This situation requires the dam to reduce her utilization of glucose and rely on alternative fuels. This state of negative energy balance is associated mobilization of fatty acids (NEFA) from adipose stores. Factors inducing a reduction in feed intake (pregnancy, poor quality forages, feeding management) or increasing energy requirement (rapid fetal growth, environmental conditions) contribute to the duration and magnitude of negative energy balance and predisposition to aberrant metabolism leading to subclinical or clinical disease. Addition of external stressors such as severe weather, sudden changes in feed, other diseases or transportation further accentuates negative energy balance through production of corticosteroids that facilitate fat mobilization.
Presentation. There are two initiating issues for pregnancy toxemia, either the overly conditioned dam with high risk for hepatic lipidosis, or the thin dam fed a poor-quality diet (i.e., starvation pregnancy toxemia). Dams with multiple fetuses are at highest risk due to the greater conceptus mass to support. Time at presentation relative to expected parturition influences potential outcome. If the dam presents in the last week or two prior to parturition, they often can be managed successfully. Dams presenting 4 weeks or earlier prior to parturition often have poor outcomes, even with intensive management. Disease course varies but generally develops over three to ten days. A more sudden onset is usually associated with a sudden stress or inefficient animal observation
Initial clinical signs may be edema of the legs and coronary band hairs sticking straight out. Appetite is poor or absent, with decreased consumption of grain observed first Dams separate from the herd, lag behind, and become depressed and weak. Clinical signs will involve the central nervous system. Chewing, teeth grinding, or vigorous licking movements may be seen Evidence of blindness develops, the animal runs into objects, shows little or no reaction when approached, and wanders aimlessly. Dullness and
depression become progressively severe. There is reluctance to move. Eventually they go down in sternal progressing to lateral recumbency and show little or no response to their environment. The dam become comatose and eventually die.
Diagnosis. History of the ewe or doe being in late gestation with multiple fetuses should be the first indicator for pregnancy toxemia. On physical exam, temperature and pulse are within normal limits. Respiration may be normal but often it becomes rapid and labored reflecting respiratory disease Definitive diagnosis is made when elevated ketones are detected in urine (diagnostic strips) or measured in blood Some can determine ketosis by recognizing a sweet acetone smell on the animal’s breath Human glucometers have been validated for use with sheep and goats to measure glucose and ßhydroxybutyrate (BHB). Diseases that may look similar to pregnancy toxemia include polioencephalomalacia, hypocalcemia, toxic mastitis (if near or after parturition), grain overload, listeriosis and lead poisoning.
Compared to cows, sheep and goats are not as ketogenic as they generally have low BHB concentration (<5 mg/dL [0.5 mmol/L]). As glucose homeostatic control is lost, blood BHB concentration rapidly increases to values seen in cow ketosis (>40 mg/dL [>4 mmol/L]) Blood BHB concentrations of 8 mg/dL (>0.8 mmol/L) and above are considered at risk for pregnancy toxemia. Sheep and goats are more sensitive to ketoacidosis compared to cows. As ketosis increases, blood bicarbonate concentration decreases and ketoacidosis may result. When the bicarbonate level declines sufficiently, the animal will become comatose. During the later stages of pregnancy toxemia, water consumption decreases, urine output is decreased, and kidney function is impaired as a result of dehydration.
Although the disease is a result of dysregulation of glucose concentration, glucose is not consistently low. Blood glucose concentration often is within normal range or elevated. Those dams with hepatic lipidosis more likely will have low blood glucose concentration (<20 mg/dL) due to impaired hepatic gluconeogenesis. Our current work reviewing metabolic profiles of late pregnant sheep and goats suggest protein status, measured by albumin, may reflect the dam’s ability to manage glucose. Low albumin may result from underlying inflammation or protein deficiency. Low albumin might suggest a lack of available amino acids to support gluconeogenesis. Hyperglycemia may be observed during the late stages of the disease as a result of the response of the adrenal glands to stress or fetal death reducing glucose demand.
Treatment. The following are the important areas to address in treating pregnancy toxemia.
Glucose Replacement Dams in the very early stages of pregnancy toxemia may respond to oral administration of propylene glycol (15-30 ml twice daily) for at least 3 days Other glucogenic precursors (propionate salts, glycol) can also be used. In addition to oral glucose precursors, especially for all dams beyond the very early stages of the disease, intravenous glucose administration (10-150 ml 50% dextrose) for 1 or more treatments, depending upon response, will be required For valuable animals use of a slow drip of 5-8% dextrose may be more supportive. During later stages of the disease, glucose administration may be ineffective or detrimental because the blood glucose levels may be very high.
Inhibit Adipose Mobilization Insulin (20-30 U Ultra Lente) may be used with glucose treatments for better utilization of glucose and to inhibit fat mobilization.
Address Dehydration, Acid-Base Balance During the later stages of the disease, acidosis and dehydration may be important factors. Intravenous administration of large volumes of electrolyte solutions with sodium bicarbonate may be important. Corticosteroids may not be effective in the later stages unless given at dosages utilized to combat endotoxic shock.
Reducing Glucose Demand
Developing fetuses are inducing the glucose drain on the dam. A decision will need to be made regarding the relative importance of fetus versus dam survivability. Abortion is the
preferred method as it is more affordable and less stressful to the dam. If the fetuses are more than 2 to 3 days premature, they will be unlikely to survive but are already at great risk of death in a severely ill dam Elective abortion can be achieved with corticosteroids (ewes) or prostaglandins (does) Before a caesarian section is performed, the dam should be stabilized using appropriate fluid therapy.
Supportive Therapy Depending upon clinical presentation, any method to increase appetite or feed intake would be useful B-vitamin injections have been used as non-specific appetite stimulant, however, with reducing intake, ruminal production of B-vitamins may be limited Force feeding of gruels via stomach tube along with ruminal transfaunation helps to increase nutrient intake Many affected dams also become hypocalcemic and should receive calcium supplementation (50-75 ml 23% calcium borogluconate SQ).
Prevention. This is a disease that needs to be prevented rather than treated. It is generally a management disease and should be initially investigated as a herd level problem rather than an individual sick goat or ewe If one animal is clinically ill, many more in the herd are likely at risk An adequate nutritional level throughout the pregnancy will prevent pregnancy toxemia. Protein and energy levels during the last 30-40 days of pregnancy should meet the dam's maintenance requirements as well as the growth requirements of the fetuses and account for observed reduction in dry matter intake Current NRC feeding recommendations suggest an increased dry matter intake with late pregnancy. Dietary protein content for late pregnancy should be between 12 and 15% of dry matter. Forage quality is critical here due to the negative effect of neutral detergent fiber (NDF) on impeding intake. A suggested NDF intake for late pregnant ewes and does is between 0.65 and 0.85 percent of body weight. This translates into a dietary NDF content between 30 and 40% dry matter. High NDF grasses (>50%) will be very problematic with intake for the late pregnant dam without feeding a higher grain allotment. Although there are feeding myths regarding alfalfa, this forage would be a good choice in feeding the late pregnant doe or ewe due to its higher protein and calcium content and good digestibility. Dietary energy content can be increased by feeding 1-2 lb of a cereal grain-based supplement. Management during late pregnancy should be directed at avoiding appetite problems in the animals. Avoid sudden feed changes, diminish stresses of severe weather, delay or avoid transportation and prevent concurrent disease problems.
Energy status can be monitored with the use of body condition scoring or measuring blood βhydroxybutyrate or NEFA concentration Dams that are very thin (< 2.5) have little fat or muscle reserves to draw upon and are then at increased risk despite a good ration. Very fat dams (> 4.0) will readily use body fat reserves in late gestation but also experience decreased voluntary intakes, thus predisposing them to formation of ketone bodies that further suppress appetite Blood β-hydroxybutyrate concentration above 8 mg/dl is suggestive of pregnancy toxemia Blood NEFA concentration above 0.4 mEq/l in late pregnancy is also suggestive of rapid fat mobilization and potential risk for pregnancy toxemia.
Hypocalcemia is a disease most often associated with dairy cattle on or immediately following calving In contrast, sheep and goats experience hypocalcemia during late pregnancy due to rapid calcium loss to the developing fetus(es) for bone mineralization. Sheep and goats can also experience hypocalcemia at or near the time of peak lactation (lactational eclampsia) Based on limited information, dairy goat breeds may present with hypocalcemia like dairy cattle. Much is known about the aberrations in calcium homeostasis associated with hypocalcemia in dairy cattle and this is extrapolated to the situation with small ruminants, which is not completely appropriate. With dairy cattle dietary calcium often is limited in the prepartum diet to stimulate the calcium homeostatic system to rapidly respond to the acute loss of calcium with colostrogenesis. With pregnant sheep and goats, it seems the homeostatic system is responsive, thus limiting calcium intake is not appropriate. Late pregnant diets for sheep and goats should maintain adequate dietary calcium content to support fetal development and colostrum production. Insufficient calcium intake during late pregnancy or early lactation will require the body to mobilize
calcium from bones to meet the need It is believed that high potassium diets and the concepts of dietary cation-anion difference also apply to small ruminants, but whether they are necessary is debated Hypocalcemia often occurs secondary to many other periparturient diseases of small ruminants, especially pregnancy toxemia or its negative effect on intake can predispose to pregnancy toxemia
Diagnosis History will indicate a doe or ewe in late gestation. Initially the animal is ataxic, nervous, and hyperaesthetic The animal may present as hyperirritable and show fine muscle twitching of the lips, eyelids, and ears. Trembling or twitching of other muscles of the body may also occur. The animal quickly becomes sternal then laterally recumbent in the final stages The head may be turned back to the flank Less severely affected dams (subclinical hypocalcemia) show lethargy, poor appetite, and poor milk production. Affected dams stop eating and their ears and skin are cold to the touch Body temperature will initially be slightly elevated but will decline to subnormal in a short period of time Pupils are dilated and show slow pupillary response to light Sometimes the hind legs are splayed out behind. Heart sounds are muffled, rapid, and weak. Death follows bloat, regurgitation of rumen contents and aspiration.
The disease course can be as short as a few hours or occur over a couple of days Occasionally it may occur as "sudden death"; the dam is found dead in the morning. Definitive diagnosis is determined by measuring serum total or ionized calcium concentration. Like dairy cattle, total calcium concentrations are < 6 mg/dl (normal 8 - 12 mg/dL) in clinical cases. In a sudden death case, vitreous eye fluid obtained during a postmortem examination can be analyzed for calcium concentration up to 48 hours after death. Differential diagnosis for hypocalcemia includes polioencephalomalacia, advanced grain overload, toxic mastitis, lead poisoning and listeriosis.
Treatment. Clinical cases of hypocalcemia are treated with careful intravenous calcium borogluconate solution infusions to effect. Typical dose is 1 g Ca per 100 lb body weight or about 50 -75 ml of most commercial calcium solutions. Intravenous therapy may be followed by SQ injections of calcium solutions as well as oral supplements. Less severely affected dams can be treated with just subcutaneous solutions Response to intravenous treatment should be dramatic The animal usually starts to shiver and brightens up by the time treatment is finished. She may defecate and urinate during or following therapy. Following IV or SQ injections, dietary intake of calcium should be increased with use of alfalfa hay or calcium-based mineral supplements.
Prevention. Maintain appropriate dietary calcium and phosphorus content in late pregnancy to support fetal bone development, but not to supplement excess phosphorus even if the ratio seems appropriate Many commercial supplements now contain byproduct ingredients such as wheat bran and distillers grains that have high phosphorus content leading to excess phosphorus delivery that can impair calcium homeostasis. Dietary potassium should be monitored in an attempt to maintain a level below 2% Dietary magnesium should also be monitored and maintained according to dietary potassium Dietary magnesium may be increased to 0.3-0.4% dietary dry matter. Once into lactation, dietary calcium and phosphorus content should be increased to a level to support milk production capacity Alfalfa hay can provide sufficient calcium. Cereal crop forages such as wheat or oat hay are very low in calcium (0.15% and 0.24% dry matter (DM) basis respectively) as opposed to alfalfa hay (1.4% DM) and should be avoided unless the ration is balanced with other calcium sources One should have forages tested for mineral content to assess adequacy. In some cases, typically due to excessive fertilization, phosphorus content may exceed 0.4% and this may impede calcium homeostasis. Use of anionic salts (minerals high in chloride and sulfur) has been advocated for dairy cattle in preventing milk fever but their need for hypocalcemia control in sheep and goats is unproven. Some dairy goat producers will provide anionic salts in the late gestation diet for milk fever prevention; however, the degree to which the dietary cationanion difference needs to be adjusted for a response is not well established for goats.
Hepatic lipidosis or fatty liver is a well-known metabolic syndrome in periparturient dairy cattle and sheep, anorexic cats, and a sporadic problem with fat horses and ponies. This pathologic process has also been recognized in most other species, including humans. There are limited reports of hepatic lipidosis in llamas and alpacas in the literature; however, owners and practicing veterinarians have an increased interest in the pathogenesis of this disease process. Although reported prevalence of hepatic lipidosis in camelids is not high (3-4%), the disease process is reported on many necropsy reports as either a primary or secondary finding.
A retrospective study of 31 histologically confirmed cases of hepatic lipidosis in llamas and alpacas submitted to Oregon State University Veterinary Diagnostic Laboratory revealed a predominately middle aged, pregnant or lactating female population to be affected. However, 22.6% of the cases were male and age ranged from 5 months to 18 years. This is very different demographics of affected animals compared to the disease in other ruminants. In these cases, there were no significant associations with any infectious, parasitic, or toxic causative agent. Many case reports on hepatic lipidosis in camelids were in association with tick paralysis.
Conditions that place increased energy demands, such as pregnancy and lactation contribute to hepatic lipidosis, but other stresses including social and environmental stresses or other illness appear to also predispose camelids to loss of appetite, weight, and accumulation of fat in the liver. This predisposition to hepatic lipidosis is most likely related to the unique underpinning of glucose metabolism in camelids. Insulin secretion is generally low in adult camelids and peripheral insulin responsiveness in dulled. Additionally, camelids seem to maintain a high rate of hepatic gluconeogenesis to support their uniquely elevated blood glucose concentrations compared to other ruminants. In many ways hepatic lipidosis in camelids is more similar to the pathogenesis seen in cats rather than ruminants.
Presentation. Camelids of a variety of ages, gender, body condition, and reproductive status are susceptible to development of hepatic lipidosis. The most common factor documented in histories from these camelids was recent severe loss of appetite or weight loss (15-20%). This period of not eating or weight loss varied from a couple of days to several weeks. Overweight, adequate body condition and thin animals were all represented in the affected group. A common theme in most cases of hepatic lipidosis in camelids is a period of anorexia prior to clinical signs. Clinical signs generally are lethargy and greater time lying down. Camelids stoic behavior makes it difficult to identify any specific signs.
Diagnosis. Any camelid experiencing some degree of hypophagia should be considered at risk for hepatic lipidosis and evaluated as such. Biochemical measures associated with negative energy balance (nonesterified fatty acids [NEFA]), liver dysfunction (bile acids), and muscle damage are consistently elevated in affected animals. Lipemia and ketonemia are not consistently associated with hepatic lipidosis though commonly mentioned in the limited literature reports. Low total protein, but not low blood urea nitrogen, was also a common clinical finding in affected animals.
We performed a feed restriction study to assess diagnostic criteria for hepatic lipidosis. All llamas in the study lost large amounts of body weight. About half developed hepatic lipidosis (5 of 10) to some degree based on histologic evaluation. No animals became depressed or recumbent. Blood tests showed the expected increases in liver enzymes in those that developed hepatic lipidosis, but not in those that simply lost weight. This is important in telling us that our blood indicators of liver disease (bile acids) are relatively specific in llamas. All llamas had elevated concentrations of NEFA indicating negative energy balance and fat mobilization. There was no significant difference in NEFA concentration between affected and unaffected animals; however, mean NEFA concentration was maintained above 1 mEq/L in affected animals. Llamas with hepatic lipidosis had significantly higher mean β-hydroxybutyrate (BHB)
concentrations (10.24 mg/dl ± 2.12) than did non-affected llamas (0.92 mg/dl ± 2.66) when measured across the whole study period and specifically at all times except day 0, 2, 16, 19, 21, and 23. This is a curious finding as camelids are not particularly ketogenic given their naturally high blood glucose concentration. These elevated ketone concentrations are not nearly as high as commonly observed in ketotic cows, sheep, or goats.
Patterns of changes of AST, SDH, GGT, and bile acids showed some differences, though they all generally increased during feed restriction. Serum AST values in all affected llamas were greatly increased (about 4-fold) by day 5, peaked around day 12, and decreased rapidly when normal diets were resumed though activity was back to baseline by the end of the study in only 2 of the llamas. SDH showed a similar pattern with marked increases (15 to 20-fold) by day 5, peak on day 12 and a rapid decrease with normal diet, but values for all llamas were back to baseline by day 23. Gamma-GT activity rose more slowly, though still markedly, reached peak mean activity on day 14-16, and decreased more slowly following a return to normal diet. Gamma-GT activity had not returned to baseline at the end of the study for any of the llamas. Bile acid concentrations also increased gradually to a peak on day 12, often decreased rapidly when the llamas were returned to normal diets, then gradually and irregularly decreased, returning to baseline concentrations in 3 of 5 HL llamas. These observations suggest SDH and AST are more acute indicators of liver insult with rapid response following recovery, whereas GGT and bile acids have longer residual elevation in values and may not necessarily show removal of the insult.
When the affected llamas were returned to normal feed, body weight increased, blood values gradually changed towards normal, and fat disappeared from the livers (based on biopsies). This was also a significant finding in that it showed that the condition is reversible when normal levels of nutrients and calories are consumed. These observations suggest that hepatic lipidosis is a reversible process and with appropriate therapy and time can result in recovery of liver function. Loss of appetite alone may not be enough to cause this problem but is a strong indicator of disease risk. Other stressors may alter the animal’s ability to adequately manage the hormonal milieu controlling carbohydrate, lipid, and protein metabolism. Blood NEFA and BHB concentrations >1 mEq/L and 5 mg/dl, respectively, are suggested thresholds that indicate a need for therapeutic intervention.
Treatment. Mortality rate associated with hepatic lipidosis is quite high for all species, even with parenteral nutritional support. Supportive therapy for hepatic lipidosis focuses on energy supplementation to minimize negative energy balance resultant from anorexia. Improving energy balance decreases the rate of adipose tissue mobilization, thus decreasing fatty acid uptake by the liver. Maintenance and resting metabolizable energy requirement (kcal/day) for llamas has been estimated to be 72.8 x metabolic body weight (Wkg0.75) and 51.3 x Wkg0.75, respectively.7 Additional energy would be needed to account for milk production (946 kcal/kg milk) if lactating and a disease factor (typically 1.2 to 2.0x RER).
Enteral Support If applicable, enteral support should be used to ensure activity and function of the fermentation system and to maintain nutrients in support of the gut. The primary goal is to stimulate feed intake. Camelids are obligate nasal breathers, so indwelling naso-gastric tubes are not practical. If orogastric tubing results in extreme stress to the animal, this may not be a viable pathway for support. Transfaunation can be used to repopulate the microbial fauna and restimulate fermentation. Collected rumen fluid from cattle, sheep, or goats can be used. Offering a variety of browse material and fresh grass clippings has been beneficial to stimulating intake. Blackberry leaves are particularly appealing to camelids. Liquid consistency gruel can be mixed and administered via tube if feasible. Soaking alfalfa pellets in hot water and mixing in calf electrolytes, calcium propionate, propylene glycol (limited use), and other ingredients can provide a nice workable mixture to provide energy sources and fermentable material.
Parenteral Support Typically, an emulsified lipid source is used as a source of energy in most parenteral solutions to minimize use of protein for energy and decrease osmolality of the solution. Dietary fat has been demonstrated to be beneficial in treating hepatic lipidosis in cats, but not in dairy cattle. The importance of limiting or including lipid intake in camelids undergoing hepatic lipidosis is not known. Glucose has typically been used as the sole source of non-protein energy in the parenteral solution, but the concentration should not exceed 10% due to camelid’s low insulin concentration and relative state of insulin resistance. Insulin supplementation (ultralente or glargine, 0.4 U/kg, subcutaneously, q 24 h) will be used in conjunction with glucose administration. Insulin appears effective in facilitating glucose and triglyceride uptake and inhibiting hormone-sensitive lipase, thereby slowing mobilization of adipose tissue and reducing the delivery of NEFA to the liver.
Formulation recommendations for parenteral nutrition solutions suggest a ratio of 150 to 200 nonprotein calories for every 1 g of nitrogen. Based on the hypothesized role of amino acids in camelid metabolism, we have used a nonprotein calorie to nitrogen ratio of only 55:1. This low ratio would presumably lead to amino acids being catabolized for energy and not being used for protein synthesis. Protein requirements for llamas are not well defined and are complicated by the presence of both microbial and host animal needs. One study suggested a maintenance digestible protein requirement of 2.38 g/Wkg0.75. Using a true absorption coefficient of 75%, this would result in a maintenance metabolizable protein requirement (g/day) of 1.79 x Wkg0.75. This suggests a maintenance requirement of 57.4 g/d or approximately 0.6 g/kg body weight for llamas. This value is in agreement with the suggested maintenance protein supplementation rate for adult healthy horses and humans. Recommendations for protein supplementation in parenteral solutions for humans range from 0.8 to 2.2 g/kg of body weight for adult to newborn, respectively. One report of TPN in a neonatal llama delivered 2.1 g protein/kg of body weight. The parenteral solution used in our report delivered approximately 170 g amino acids per day, equivalent to 1.7 g/kg of body weight. The higher rate of protein delivery to the adult llama was extrapolated to account for protein needs of lactation as well as address issues of amino acid use for gluconeogenesis. No adverse effects of this amount of protein supplementation, as evidenced by alterations in biochemical profiles, were observed throughout the duration of parenteral support.
Prevention. Proper nutritional management to minimize potential for inducing negative energy balance leading to adipose tissue mobilization. One needs to ensure sufficient protein in the diet to ensure the microbial populations in Comparts 1 and 2 are able to efficiently digest plant cell wall material. A minimum dietary protein of 8% is recommended. Higher dietary protein would be necessary for physiologic states beyond maintenance. Similar to ruminants, camelid feed intake is controlled by the neutral detergent fiber (NDF) content of the forages. Across ruminants an estimated NDF intake of 11.2% of live body weight is observed. In reviewing published feeding trial studies with llamas and alpacas, I determined the NDF intake for llamas and alpacas to be lower than that of ruminants, typically between 0.8 and 0.9% of body weight. This may seem contradictory given the documented ability of camelids to digest low quality forages to a greater extent than ruminants. However, this ability comes from the camelid slowing their rate of passage in the fermentation vat allowing the microbial populations greater time to digest the plant fiber, thus a lower total NDF intake.
Any stress factor that may induce a period of anorexia should be minimized as part of the hepatic lipidosis prevention practices. Heat stress is a potentially significant factor. Social stressors, transportation, among other factors all can induce a period of anorexia. If this is coupled with feeding poor quality forages there is a greater risk for hepatic lipidosis.
Vitamin D-deficiency Rickets (Hypophosphatemic Rickets)
Abnormal bone growth is a common problem in young growing animals of all domestic species. Rickets is one such nutritionally related metabolic bone disease characterized by a failure of mineralization of
bone osteoid and cartilage matrix resulting in visibly swollen joints and lameness. If left untreated, long bones become deformed, leading to angular limb defects, and prone to fractures. Absolute or induced deficiencies of calcium, phosphorus, vitamin D or some combination have been identified as causes of rickets. Absolute minimal daily amounts of all three nutrients are required, additionally, amounts of the three nutrients must be maintained within appropriate relative ratios to allow for normal mineral deposition in growing bone.
Survey and supplementation trials suggest this hypophosphatemic rickets syndrome of llamas and alpacas is a result of vitamin D deficiency and not phosphorus as was initially suggested. Camelids are somewhat unique in that vitamin D has more control over phosphorus homeostasis than calcium. Vitamin D is required not only to support bone mineralization, but to facilitate intestinal absorption of phosphorus. Serum vitamin D and phosphorus concentrations show a seasonal pattern where lowest values occur during December to March and highest values during June to September. Vitamin D is naturally synthesized in non-pigmented areas of the skin upon exposure to sunlight. More darkly colored and heavily fleeced llamas and alpacas have lower vitamin D concentrations, but shearing increases skin exposure and subsequently, vitamin D concentration. Intensity and angle of the sun at the most distant latitudes within Northern or Southern hemispheres may be insufficient during winter (Northern hemisphere) or summer (Southern hemisphere) months to maintain adequate vitamin D status without dietary supplementation. Seasonal variation in blood vitamin D concentrations has also been implicated with susceptibility of long bone fractures.
Presentation. Affected llama and alpaca crias typically are 3-to-6-month-old when presented. Affected crias are show a slowed rate of growth, reluctance to move, humped-back stance and shifting leg lameness. On physical exam joints are enlarged, most obviously the carpus. A seasonal incidence has been recognized with this syndrome; most cases occurring during the winter months of December to March in northern latitudes of North America.
Crias born in the fall and winter months (Northern hemisphere) have greater risk than those born at other times of the year. Crias born between March and August have significantly greater serum vitamin D concentrations through the first 7 months of life compared to crias born between September and March. Intuitively, fall-born crias never obtain vitamin D reserves from summer sunshine, compared to springborn crias. Fall-born crias will have the lowest concentrations of vitamin D and phosphorus during the period of rapid growth compared to spring-born crias. To ensure adequate vitamin D reserves to meet the challenge of rapid growth, crias born during periods of reduced day length should receive appropriate vitamin D supplementation.
Diagnosis. Hypophosphatemia (< 3 mg/dL, <0.97 mmol/l) is suggestive of the disease and should be coupled with finding radiographic bone changes. Serum vitamin D concentration is a definitive method of diagnosing hypophosphatemic rickets (Table 1). Serum vitamin D concentrations below 10 ng/ml (25 nmol/L) are consistent with a rickets diagnosis.
Treatment and Prevention. Treatment and prevention of this syndrome can be accomplished with therapeutic or preventive vitamin D supplementation. Vitamin D can be effectively supplemented by injection, oral dosing or increasing dietary levels. Injections of vitamin D3 between 1,000 and 1,500 IU/kg body weight have been shown to maintain adequate serum vitamin D concentrations for up to 3 months. Oral gels delivering vitamin D3 at 33,000 IU every 2 weeks or 100,000 IU once monthly have also been used successfully. Both methods can be used to effectively treat an affected cria or used as a preventive measure. Preliminary estimates suggest that llamas and alpacas require a daily supplementation of vitamin D at a rate of 33 IU/kg BW (15 IU/lb BW) to maintain sufficient serum concentrations of vitamin D to prevent rickets. One must also recognize that vitamin D is one of the more potentially toxic nutrients and therefore, care must be taken in not exceeding recommendations with indiscriminate supplementation.
Table 1. Age-Based Criteria for
Cria 1–6
Weanling (Tuis) 7–12
13–24
Adult >24
ng/mL, nanogram per milliliter; nmol/L, nanomole per liter.
Note: Concentrations below 25 nmol/L (10 ng/mL) or above 500 nmol/L (200 ng/mL) are consistent with deficiency and toxicity disease risks, respectively.
Unfortunately, vitamin D is one of the more toxic essential nutrients. Given the usual adage that if a little is good, a lot is better; a study was undertaken to assess the degree of toxicity vitamin D has in llamas and alpacas. Following our initial research supplementing parenteral vitamin D to treat or prevent rickets we performed a second study to investigate the potential toxicity of vitamin D in camelids. Initially 12 llamas and alpacas were assigned to 1 of 4 treatment groups with varying levels of a single vitamin D intramuscular injection (8000, 16000, 32000 IU/kg BW). Serum vitamin D concentrations showed a dosedependent response; however, no clinical evidence of acute vitamin D toxicity was appreciated. Following these results, a single animal was treated with a higher dosage (64,000 IU/kg BW) and again no acute toxicity was observed on clinical or postmortem evaluation. In reviewing these results, serum vitamin D and P concentrations were in the toxic range for most other species. The high serum P values are of concern since they may result in a precipitation of Ca and P crystals in blood, urine and body tissues over time. A third trial using 9 llamas at 3 vitamin D treatments was initiated using an emulsified form of vitamin D, as was used in the previous supplementation studies. Again dose-dependent vitamin D responses were observed, but no clinical evidence of acute toxicity. Long-term toxicity problems were not addressed in this study and need to be of concern given the observed changes in serum P concentrations.
Llamas and alpacas seemingly are seemingly tolerant of acute vitamin D toxicity (single large doses). However, evidence suggests that multiple dosing of vitamin D may result in altered P metabolism with the possibility of Ca and P precipitation in urine and tissues. Vitamin D supplementation should be approached carefully and under the guidance of a veterinarian. Increasing the suggested treatment dosage of vitamin D is not recommended as there is no evidence of improved effect and suggestions of deleterious effects to animal health are evident.
Diagnosis. Vitamin D intoxication results in non-specific clinical signs of anorexia, weight loss, lethargy, depression, and renal dysfunction. Additionally cardiac arrhythmias or lameness may be present. One challenge here is that many of these signs are often associated with problems of vitamin D deficiency and often the first response in young camelids is to administer parenteral vitamin D. Additional clinical signs
associated with cardiac, renal, or respiratory function may be present depending upon the degree of soft tissue mineralization.
Serum vitamin D concentrations are expensive and often not available in a timely fashion. Animals may be exposed or at risk for vitamin D intoxication yet may have normal renal function. Elevations in serum Ca or P concentrations may not be sufficient to adequately diagnose risk from vitamin D intoxication. With the uncertainty in using either hypercalcemia or hyperphosphatemia as a diagnostic indicator, another possibility is using the product of Ca and P concentrations as a measure of risk for metastatic calcification. The calcium x phosphorus (CaP) concentration product (mg2/dl2) has been used in human medicine as an indicator for risk of renal mineralization. A threshold of 55 mg2/dl2 has been used, but its applicability to camelids needs to be validated.
Using multiple collections of serum Ca and P concentrations from survey and vitamin D administration studies, CaP product values were evaluated. Healthy, non-vitamin D treated adult camelids had a CaP of 48.1 ± 3.1 mg2/dl2. Age influences this parameter with yearlings (75.9 ± 5.1 mg2/dl2) and crias (95.3 ± 3.2 mg2/dl2) having higher values. This parameter was used to evaluate potential vitamin D intoxication in an alpaca herd exposed to a high dietary vitamin D (191,000 IU/lb) supplement over a period of months. The percent of adult samples having a CaP greater than or equal to 60 mg2/dl2 was significantly higher in samples from vitamin D injected camelids (43.8%) and the samples collected from the vitamin D supplement exposed camelids (31.9%) compared to camelids not supplemented with vitamin D (16.2%). The two vitamin D intoxicated crias from the case study presented with CaP products of 194.6 and 155 mg2/dl2; values much higher than non-exposed crias.
Treatment and Prevention. There is no therapeutic correction for vitamin D intoxication. The metastatic calcification of soft tissues cannot be reversed. One should remove the source of vitamin D and provide supportive care to ensure hydration and renal function. Dietary content of calcium and phosphorus should be minimized to reduce available mineral for absorption. Intensity of supportive care will depend upon the severity of renal dysfunction.
Nutritional Myodegeneration (White Muscle Disease, Stiff Lamb Disease)
Most soils around the Northeast are very deficient in selenium, resulting in low selenium content of forages Selenium functions as an antioxidant, generally in concert with another antioxidant, vitamin E Selenium and vitamin E have been shown to be equally or mutually protective against a wide range of disease processes Both vitamin E and selenium have been associated with maintaining normal immune function Degeneration of muscle fibers associated with white muscle disease is believed to be related to a lack of antioxidants to protect cells against pro-oxidant reactants generated during normal metabolic reactions.
Presentation. Selenium deficiency may result in various syndromes including abortion, stillbirth, weak neonates, poor growth, and muscular lesions Selenium and vitamin E deficiency can cause acute muscle necrosis resulting in muscle fibers being replaced with fibrous tissue and becoming mineralized (calcium deposits leading to “white” color) Usually, young fast-growing neonates are affected anywhere from birth to full grown Kids and lambs are acutely painful, reluctant to move but may still eat. Sometimes it manifests itself as sudden death as the heart muscle is affected. Tongue muscles may be affected in newborns leading to issues in their ability to nurse properly.
Diagnosis. Selenium concentration in serum, whole blood, or liver tissue can be used to determine selenium status of the animal showing clinical signs Liver or serum selenium content can adequately reflect nutritional status. Serum selenium concentration best reflects current selenium status but is confounded by hemolysis. Whole blood selenium content also evaluates selenium status but is less
sensitive to dietary changes and reflects dietary selenium status over the past 2 - 3 months. If selenium supplementation is unknown, collecting both serum and whole blood for selenium analysis can provide a perspective on current and historical selenium status. If the dam has been fed stored harvested forage through the winter months her vitamin E status may be compromised and subsequently her offspring’s status. Serum or liver vitamin E (alpha-tocopherol) concentrations are very diagnostic for nutritive status.
Treatment. In acute cases of white muscle disease, injection of selenium with vitamin E may result in clinical recovery Multiple commercial injection products are available with varying selenium concentrations The vitamin E content of these products is not appropriate for nutritional supplementation and only present as an antioxidant. A separate vitamin E parenteral product is needed to supplement appropriately. One must be careful in proper selenium dosage as an excessive dosing can result in an immediately fatal reaction. The suggested dose of parenteral selenium is 25 µg/lb body weight. The different commercial selenium products vary in the concentration thereby altering the dosage volume. Parenteral selenium injections are potentially toxic leading to cardiovascular collapse within hours of injection. There is no antidote.
Prevention. Appropriate dietary selenium supplementation is the preferred method of prevention Selenium is considered a feed additive and regulated by the Food and Drug Administration. There are specific regulations for dietary selenium supplementation. Free choice trace mineral salts can have a maximum of 90 ppm selenium for sheep and goats; however, many products have much less as they infer a higher intake rate. At a typical consumption rate for sheep and goats (0.25-0.33 oz/day), this would provide the maximum of 0.7 mg selenium per day. Selenium premixes can be added at a maximum of 0.3 ppm supplemental selenium in the total diet. Organic selenium supplements have been approved for use in small ruminants. The form of selenium (selenomethionine) is more readily bioavailable. This form of selenium can increase muscle and milk selenium content but does not increase the functional form of selenium (glutathione peroxidase) any better than inorganic selenium supplements. Use of a mixture of inorganic (75-80%) and organic (20-25%) selenium sources might best meet needs and be economically sound.
Label claims on injectable selenium indicate not to administer to pregnant ewes and does as it may induce abortion. This is a low probability situation but the owner needs to be aware of the risk. If dietary supplementation has not been practiced, a doe or ewe can be injected two to four weeks prior to parturition to protect the newborns Kids and lambs should be re-injected at one month of age if no feed supplementation.
Clinical iodine deficiency or toxicity has a clinical sign of goiter, an enlarged thyroid gland. When iodine deficient the thyroid gland increases the number of follicles to help extract any iodine in the blood. When iodine is in excess, the follicles enlarge with thyroglobulin, the protein complex storing iodine. The geographic region surrounding the Great Lakes is a known iodine deficiency area.
Presentation. The thyroid hormones (triiodothyronine, T3 and thyroxine, T4) are body regulators of metabolism and affect many metabolically active tissues. Affected animals may initially show rough hair coats, be lethargic, and show weight gain. Young animals may have poor growth rate. Lactating animals may have reduced milk production. Pregnant animals are most likely affected due to their higher requirement; however, most affected are the offspring as iodine is not transferred efficiently across the placenta. Severe iodine deficiency during pregnancy can result in abortion or hairless stillborn. Goiter will be present in the offspring but may not be present in the dam.
Diagnosis. Clinical presentation of goiter is diagnostic for iodine issues, deficiency or toxicity. Histopathology of the goitrous thyroid will determine if the problem is due to iodine deficiency or toxicity. More recent technology now allows for the measurement of serum iodine concentrations. Thyroid hormones can be used but often are not highly diagnostic. Selenium status should be considered if measured T3 concentrations are low as a selenium-dependent deiodinase enzyme is responsible for converting T4 to its active form of T3
There are compounds that could be present in weeds or various brassica plants that interfere with the uptake of iodine by the thyroid or iodination process within the thyroid. These compounds are termed goitrogens and their presence will increase the requirement of iodine in the diet.
Treatment and Prevention In identifying goiter in the dam or offspring one can supplement iodine topically or orally. Betadine or similar iodine solution is readily absorbed across the skin. There is a suggestion that the speed with which iodine is absorbed is proportional to iodine status; however, this response is not validated. Typically, 1/2 oz of an iodine solution can be painted on an area of skin to rapidly provide iodine to a deficient animal. Dietary supplemental with an iodized salt should follow any treatment or be used for prevention. The requirement for iodine in sheep and goats is 0.5 ppm dry matter for maintenance and 0.8 ppm dry matter for pregnancy. The Boer phenotype seemingly has a higher iodine requirement compared to other goat breeds possibly due to its greater growth rate.
Lite salt is a mixture of sodium chloride and potassium iodide. This can be a readily available source of iodine; however, iodine is readily leeched from this salt with any moisture. Most trace mineralized salt products containing iodine would have calcium iodate, which is more stable and available. Most trace mineral salt products should have a minimum of 50 ppm iodine, though higher content may be preferred under most conditions.
Presentation. Potential zinc deficiency is another disease process of great concern with camelids and can be a concern in other small ruminants. A nonpruritic, idiopathic hyperkeratosis syndrome recognized in 1to-2-year-old male and female llamas and alpacas has been described. Lesions are mostly noted on hairless areas of the body and are characterized by a thickening of the skin with tightly adhering crusts. Histologic changes of epithelial and follicular orthokeratotic hyperkeratosis are characterized in the lesions. Although parakeratotic hyperkeratosis is typically associated with Zn deficiency, Zn-responsive orthokeratotic hyperkeratosis has been recognized in other ruminants. Colored fleeced animals were more susceptible to the problem, consistent with observations.
Diagnosis. Serum Zn concentration can be used to assess status, though it has been recognized in most species that blood or liver Zn concentrations are not exceptionally diagnostic or sensitive to nutritional intake. Reported serum Zn concentrations for llamas and alpacas were 0.21-1.13 μg/mL and 0.19-2.05 μg/mL, respectively. The lower marginal band that may be associated with clinical signs is < 0.2 μg/mL. This value is consistent with a published case study where Zn supplementation resulted in reversal of the documented skin lesions.
Treatment and Prevention. Affected animals seem to respond to supplemental Zn, in spite of receiving an adequate Zn diet, gradually over a 2-to-3 month period. There is confusion over the amount of Zn to be supplemented. The challenge here is the different potential sources of Zn and their Zn content. An inorganic Zn supplement is zinc sulfate (36.3% Zn) that would be provided at a rate of 1 g/day. Most often an organic Zn supplement, such as zinc methionine, is recommended as it is considered more available. A pharmacologic dosage of 2-to-4 g Zn per day is recommended. There are multiple forms of zinc methionine with differing Zn content (Zn-Pro 180, 40 and 120 contain 18%, 4% and 12% zinc,
respectively). Recommended feeding rates for the Zn-Pro product for llamas target a Zn element intake of 100 mg/day. Therapeutic dosing should be at least 200 mg/day.
Ensuring sufficient dietary Zn from an available source is adequately provided in the diet is recommended to prevent the problem. Recommended dietary Zn for camelids is 55-65 mg/kg of dietary dry matter. Dietary Zn availability can be interfered with by high dietary iron, copper, and calcium. Whether or not this condition is truly a Zn-deficiency is debated, but these new data support the hypothesis that Zn is a primary factor in the disease.
References and Resources:
Arraya AV, Atwater I, Navia MA, et al. Evaluation of insulin resistance in two kinds of South American camelids: llamas and alpacas. Comp Med 2000;50(5):490-4.
Bayne, J.E. Pregnancy toxemia therapeutic options. Vet Clinics NA: Food Anim Pract 2023;39(2):293306.
Cebra CK, McKane SA, Tornquist SJ. Effects of exogenous insulin on glucose tolerance in alpacas. Am J Vet Res 2001;62(10):1544-7.
Cebra CK, Tornquist SJ. Glucose tolerance and insulin sensitivity in crias. Am J Vet Res. 2005;66(6):1013-7.
Firshman A. Pancreatic function and insulin sensitivity in South American camelids. In: Proceedings of the International Camelid Health Conference. Columbus, OH: 2008, p. 117-25.
Gerspach C, et al., Acute renal failure and anuria associated with vitamin D intoxication in two alpacas (Vicugna pacos) cria. JVIM 2010; 24:443-449.
Hovda L.R., McGuirk S.M., Lunn D.P. Total parenteral nutrition in a neonatal llama. J Am Vet Med Assoc 1990;196:319-322.
Judson GJ, Feakes A. Vitamin D doses for alpacas (Lama pacos). Aust Vet J 1999;77(5):310-315.
Menzies, P.I. 2022. Metabolic & Nutritional Diseases of Goats. Ontario Ministry of Agriculture, Food and Rural Affairs website (http://omafra.gov.on.ca/english/livestock/goat/facts/menzies.htm).
Mongini, A. and Van Saun, R. Pregnancy toxemia in sheep and goats. Vet Clinics NA: Food Anim Pract 2023;39(2):275-291.
Nelson, D.R. and S.B. Guss. 1992. Metabolic and Nutritional Diseases. Extension Goat Handbook, National Dairy Database.
National Research Council. Vitamin tolerances of domestic animals. National Academy Press: Washington, DC, 1987.
National Research Council. Nutrient Requirements of Small Ruminants. Sheep, Goats, Cervids and New World Camelids. National Academy Press: Washington, DC, 2007.
Pugh, D.G., Baird, N., Edmondson, M., Passler, T. Sheep, Goat and Cervid Medicine, 3rd ed. Philadelphia: Elsevier, 2020
Schoenian, S. 2024. Maryland Small Ruminant Web Site, www.sheepandgoats.com, Accessed December 27, 2024.
Smith, M.C. and D.M. Sherman. Nutrition and Metabolic Diseases. In: Goat Medicine, 2nd ed., Philadelphia: John Wiley & Sons, 2009
Smith BB, Van Saun RJ. Seasonal changes in serum calcium, phosphorus and vitamin D concentrations in llamas and alpacas. American Journal Veterinary Research 2001;62(8):1187-1193.
Tornquist S.J., Cebra C.K., Van Saun R.J., et al. Metabolic changes and induction of hepatic lipidosis during feed restriction in llamas. Am J Vet Res 2001;62(7):1081-1087.
Tornquist S.J., R.J. Van Saun, B.B. Smith, et al. Histologically-confirmed hepatic lipidosis in llamas and alpacas: 31 Cases (1991-1997). J Am Vet Med Assoc 1999;214(9):1368-1372.
Van Saun R.J., Callihan B., Tornquist S.J. Nutritional support for treatment of hepatic lipidosis in a llama. J Am Vet Med Assoc 2000;217(10):1531-1535.
Van Saun RJ, Herdt TH. 2014. Chapter 12. Nutritional Assessment. In: Cebra et al., (eds), Llama and Alpaca Care: Medicine, Surgery, Reproduction, Nutrition and Herd Health, Elsevier: St Louis, 2014, pg 120.
Van Saun RJ, Smith BB, Watrous BJ. 1996. Evaluation of vitamin D status in llamas and alpacas with hypophosphatemic rickets. Journal of the American Veterinary Medical Association 209:11281133.
Kerry Karaffa, PhD
Despite the widespread implementation of embedded counseling models in veterinary training programs, limited information is available about veterinary students and house officers who seek help, and researchers have not evaluated the effectiveness of counseling services. This study sought to describe clients’ characteristics, presenting concerns, and mental health histories, in addition to determining if participating in counseling was associated with decreases in psychological distress. The sample included 437 DVM students and house officers receiving embedded counseling services between August, 2016 and March, 2024 at a public university in the midwestern United States. Approximately half were first-year students when they initially accessed services. The most common presenting concerns included stress, anxiety, depression, academic performance, perfectionism, self- esteem/confidence, attention/concentration difficulties, mood instability, sleep difficulties, adjustment, family issues, career concerns, eating/body image concerns, and specific relationship problems. DVM students and house officers reported higher scores on some, but not all, measures of psychological distress prior to participating in counseling, compared to a normative sample of college students seeking counseling at university counseling centers. However, these differences tended to be small in magnitude. Participating in counseling was associated with meaningful improvements in depression, generalized anxiety, social anxiety, academic distress, eating concerns, frustration/anger, family distress, substance use, suicidal ideation, and overall psychological distress. Clients who reported improvements in depression and anxiety also tended to report reductions in academic distress, which underscores the value of embedded counseling services in improving the well-being and academic retention of DVM students and house officers. Implications for outreach, research, and clinical practice are discussed.
SGLT2 inhibitors for horses – a new drug category to help with metabolic syndrome?
Philip J. Johnson
The number of obese/overweight horses that veterinarians encounter in the modern world has been increasing in parallel with the ‘obesity epidemic’ that has beset the human population. As with their human counterparts, obesity develops in horses that are routinely fed rich rations that exceed nutritional energy requirements for basic daily needs. Some breeds of horses (and especially ponies) are especially prone to develop obesity because they have inherited an efficient metabolism, often referred to as a ‘thrifty’ phenotype or being an ‘easy keeper’.
Obesity is recognized during the physical examination with emphasis on the assessment of the depth and extent of subcutaneous adipose tissue. In some obese individuals (not all), the hormone insulin is ‘dysregulated’ in a condition referred to as either equine metabolic syndrome or insulin resistance. The blood insulin level in these individuals tends to run too high (hyperinsulinemia), especially following ingestion of a meal with a high sugar/starch content or during grazing pastures with high sugar/starch content. Remarkably, high blood insulin results in laminitis (‘founder’), which causes either painful lameness or, more commonly, changes in the visible appearance of the hoof wall (‘founder lines’). In severe laminitis, there is extensive and severe degradation of the structure of the interior of the hoof and affected equids may become permanently disabled. In the most severe instances of laminitis, a question of euthanasia is generally discussed. Equine metabolic syndrome is suspected when horses become overweight or develop generalized or ‘regional’ obesity. Insulin dysregulation and hyperinsulinemiaassociated laminitis sometimes develop in non-obese equids, and insulin dysregulation is not identified in all obese individuals. The condition is common in adult horses across a broad age range and some reports suggest that it may affect up to 27% of horses. It is more common in specific breeds, including donkeys (donkey metabolic syndrome). In many instances, equine metabolic syndrome (and underlying insulin dysregulation) is first recognized when laminitis has already developed, and veterinary attention has been called for the diagnosis and treatment of overt lameness. In other cases, a diagnosis of equine metabolic syndrome is established when subclinical laminitis is identified based on the presence of abnormal hoof growth (laminar rings, divergent growth lines and broadening of the white line zone at the dorsal aspect). ‘Weight loss resistance’ is another component of equine metabolic syndrome and describes the condition in which weight reduction by some individuals is much less than others under similar conditions of dietary restriction. Horses affected with weight loss resistance are commonly referred to as ‘easy keepers’ or ‘good doers’
The most effective way to prevent laminitis in susceptible individuals is to avoid feeding rations that contain too much sugar and starch (collectively referred to commonly as non-structural carbohydrates or NSC). Such an approach may include strict limitations regarding the quantity of time allowed at pasture (especially at certain times of the year and under specific meteorological conditions) and not feeding grain when it constitutes excessive dietary energy in terms of nutritional need. Veterinarians may monitor the risk of laminitis by measuring the blood concentration of hormones (insulin, ACTH, leptin, adiponectin) that contribute to the disease process. Exercise is also very important for the purpose of preventing laminitis and to ‘offset’ higher insulin levels, but exercise can be detrimental to the hoof if laminitis has already occurred (weakening the hoof lamellar interface). Moreover, laminitis is painful and ‘forcing’ a horse to work/exercise with laminitic pain is unkind. The principal approach to the treatment of metabolic syndrome and laminitis is through employment of pain relief (as needed), strict rest (to prevent worsening laminitis), and dietary adjustments (reducing the sugar and starch levels in provided food). Other risk factors contributing to elevated insulin levels should be identified and, if possible, eliminated. Although management of insulin dysregulation can usually be effectively achieved through dietary adjustment and improved exercise, owners do not always have complete control over how their animal is being managed. Moreover, when laminitis is active (acute flare), exercise is not appropriate, and dietary changes may not rapidly reverse hyperinsulinemia. Therefore, pharmaceutical options should be considered to prevent worsening damage to the hoof–lamellar interface. When painful laminitis is evident, it should be assumed that insulin dysregulation is present and treatment (nutrition and drugs) to neutralize hyperinsulinemia should be urgently considered.
Until recently, the 2 most commonly employed pharmaceutical treatments for EMS have been thyroxine (thyroid hormone supplementation) and metformin (an anti-diabetic agent). Pharmaceutical inhibitors of sodium-glucose cotransporter-2 (SGLT2 inhibitors or “gliflozins” [such as the human drugs, ‘Jardiance™’ and ‘Farxiga™’] represent a novel class of human-oriented antidiabetic drugs that promote
glucose elimination through the kidney and are emerging as a highly effective treatment for hyperinsulinemia in horses with insulin dysregulation. By promoting glucose elimination in urine (glycosuria) insulin secretion by the pancreas is inhibited (lessening the risk of laminitis). Several SGLT2 inhibitors (such as ertugliflozin, velagliflozin, canagliflozin) have been effective when administered orally (albeit off-label) for reversal of hyperinsulinemia in insulin dysregulated horses. In one report, a small number of horses with hyperinsulinemia that had been refractory to diet control, metformin, levothyroxine and pergolide were treated using canagliflozin. This treatment was highly effective, reducing insulin to normal (or near normal) levels, reversing abnormal fat pads and eliminating laminitic pain. In another case series, 51 horses with hyperinsulinemia-associated laminitis were treated with ertugliflozin, which resulted in weight loss, marked reductions in insulin concentrations and decreased laminitic pain. Those authors also commented that the speed and degree of improvement in laminitic pain was unexpected, further emphasizing the direct causal relationship between hyperinsulinemia and hyperinsulinemiaassociated laminitis. SGLT2 inhibitors should also be considered during the initial management of painful, acute hyperinsulinemia-associated laminitis, especially if significant hyperinsulinemia has been identified on blood testing.
Use of SGLT2 inhibitors should be curtailed if (for any reason) the patient develops anorexia, inappetence, lethargy or signs of gastrointestinal disease (such as colic or colitis) so that significant lipid movements associated with negative energy balance is not significantly worsened through drug action. Temporary discontinuation of treatment with SGLT2 inhibitors is also be advised if there is need for the patient to be fasted for any reason (2–3 days beforehand). Other potential complications of treatment with SGLT2 inhibitors include (theoretical) risk of hypoglycemia (less likely in the face of insulin dysregulation), increased frequency of to glycosuria), urinary tract infections (glycosuria), and mycotic genital skin infection (reported in humans).
A designated and licensed SGLT2 inhibitor drug for horses does not presently exist, and the human medical products are expensive. Therefore, veterinarians have been using compounded sources of these drugs. Extensive studies regarding the long-term use of SGLT2 inhibitors have not yet been reported for horses and we (veterinarians) should all be mindful of potential complications. We recommend that, when starting SGLT2 inhibitor drug treatments in horses, regular blood tests (at least every 3 months) for insulin, triglyceride, creatinine, GGT (for liver) levels should be performed to both assess for efficacy and to monitor for adverse effects
SGLT2 inhibitors, developed for management of type 2 diabetes mellitus in people, are being increasingly used with positive outcomes for the management of insulin dysregulation and hyperinsulinemia-associated laminitis in horses and ponies. However, there is a lack of information regarding potential adverse effects of these drugs when used in horses in the long term. Therefore, treating horses should be undertaken with caution and with appropriate consideration regarding the side effects that have been reported in both the human and equine medical contexts.
References available upon request.
Marie Kerl DVM, MPH, MBA, DACVIM (SAIM), DACVECC
Marie E. Kerl DVM, MPH, MBA, DACVIM (SAIM), DACVECC Chief Medical Officer, VCA Animal Hospitals Inc., Los Angeles, CA
Patient safety events include medication errors, anesthetic errors, vaccination errors, surgical complications/ errors, communications errors, patient handling, treatment, or dental errors. Sometimes, the team recognizes the occurrence of an adverse event right away, while other adverse events come to one’s attention through client complaints or unexpected patient death. The purpose of this session is to provide education about, and hands-on training in, a veterinary team method including veterinarians, technicians, and hospital management for addressing causes of adverse events in veterinary hospitals through root-cause analysis, and to discuss the impacts of adverse events on patients, clients, and hospital team members.
Medical adverse events or errors are a common cause of death in human healthcare. While there are many definitions, medical errors generally represent an unintended act, either of commission or omission, or failure to achieve the intended outcome. 1 Some estimates identify medical error as the third leading cause of death in the United States. 2 Healthcare errors have a high emotional and physical cost for patients, emotional and professional cost for medical care providers, and financial cost for the healthcare system. 3 Errors can occur from cognitive limitations of individuals, or systems errors. 4 While there is no universal reporting system in veterinary healthcare to classify the types of patient safety events, internal data from the Mars Veterinary Health Patient Safety Reporting System show the top 4 categories of patient safety events include (in order of frequency): Medication errors, Patient handling, Anesthesia, and Surgical events. In addition to adverse events, a “near-miss” event is an incident that could have had adverse consequences but did not. 5
Veterinary medical errors have a negative impact on mental health and well-being in our profession. In a survey-based study published in December 2024, of the 2,182 respondents, 880 identified as veterinary technician/nurse or assistant.6 Respondents indicated ~75% had been involved in a patient safety event, and 50% of those events resulted in serious harm. Low resilience following an event (an indication of psychological distress) was seen in 25% of veterinary technicians and 39% of veterinary assistants. Psychological distress was also associated with physical distress.
Medical errors must be reported to be addressed; however, veterinary medicine lacks a universal reporting system, and evidence suggests that errors in human healthcare are consistently underreported. 3 There are many reasons for underreporting, with frequently cited factors by physicians being professional repercussions, legal liability, blame, lack of confidentiality, negative patient or family reaction, humiliation, perfectionism, guilt, lack of anonymity, and absence of support for disclosure.7 Veterinarians share some similar characteristics to physicians including perfectionism, and the professional directive to take ultimate responsibility, leading to a “blame and shame” culture in veterinary medicine. 8 Hospitals with a high “culture of safety” are associated with less “blame and shame” culture and more psychological safety.
A universal error reporting tool does not currently exist for veterinary medicine. To address errors within a practice, group of practices, or veterinary team, practice and business leadership must support and maintain a culture of openness and willingness to address errors that includes all members of the veterinary team. For major errors, it is common for multiple individuals within a practice to have knowledge of the event. If team members are ignored, belittled, or punished when providing information on near misses or adverse events, they will disengage in the process and improvement will be impossible. Reporting channels can be both informal (e.g. technician tells manager about a problem), and formal (completing a paper or online form that goes to management). Providing an anonymous method for error reporting may be helpful if this process is not trusted or accepted in a hospital. The nature, frequency, and severity of the problem will influence how management is notified of the error. Keeping a record of errors and categorizing errors is vital to identify recurrent themes since these provide the greatest opportunity for systems improvement over time.
If your practice is not currently holding regular meetings to address adverse events and near misses, events will need to be addressed with diplomacy and tact to prevent those involved in the patient safety event from negative feelings that will hinder investigation and improvement. The guiding principles of adverse event investigation should be explicitly stated at the outset, such as: 9
• Medicine is difficult
• Errors are inevitable but they give us a tool to improve our skill as clinicians
• The goal of the conference is not to criticize, but to profit by sharing and examining our experience.
Historically in healthcare, physicians and veterinarians have engaged in a case follow-up mechanism called “morbidity-mortality rounds”. While many different formats have been described for morbidity-mortality rounds, the general concept is a gathering of professionals to describe and characterize the adverse event, discuss factors that contributed to the adverse event, and acknowledge and address the reasons for any errors that occur. Historically, all senior physicians and physicians in training programs gather, and a senior physician is responsible for presenting a case in which those in training were involved. The current culture of “blame and shame” in healthcare is an obstacle that must be overcome when addressing adverse events, and this historical method of morbidity-mortality rounds may be overly intimidating.
The term “root cause analysis” refers to a patient safety event follow-up method to determine root causes of an adverse event that focuses on “why” rather than “who”. For example, in a case of failure to identify and communicate a positive heartworm test result, a “who” focus approach would be “The positive heartworm test result was not communicated to the owner because Dr. Smith forgot to call the owners.”. The solution is to tell Dr. Smith to be more careful; however, because Dr. Smith is human and humans make mistakes, that approach will not prevent this error from happening again. With root-cause analysis, a “why” approach might look like “The positive heartworm test was not communicated to the owner because the initial result came in with some negative tests but the heartworm test was “pending” when the owner was called”, “there is no difference (color, highlight, all caps”) of the word “positive” among the test result in our computer system”, “Dr. Smith was a relief doctor and we don’t have a mechanism to follow up with clients on testing by relief doctors”, and “we don’t provide clients with access to their lab tests to be able to review results”. Through this method, items are identified that can have actions taken to change administrative or procedural protocols to prevent future errors.
Case Selection: While in theory every case of a near miss or adverse event should be addressed, not every case is of equal severity to warrant a hospital-wide rounds process. 14 Examples of events of varying severity are presented in Table 1
Root Cause Analysis Duration and Frequency: Practice makes perfect, and performing root cause analysis takes time to perfect. The duration will vary with the number of cases to be reviewed and the length of time available. Frequency can be variable, although reasonable times to practice root cause analysis are with serious or lifethreating/ life-limiting events, or when a pattern of events such as frequent medication errors is identified. Estimates from other industries with safety event monitoring state that a reasonable expectation of adverse events would be that each employee would report at least one adverse event or near miss annually. So, if your busy specialty practice employs 150 people, you would reasonably expect 150 reports a year if employees are supporting a culture of safety.
Rounds Presentation Participants: Prior to scheduling rounds, the following should be determined: Moderator, Presenter, Attendees, and Presentation Format. Attendee roles are shown in Table 2. 10 While a hospital with a strong culture of safety can include those involved in the event to participate, there are situations that are extremely emotionally charged, or in which a “blame-and-shame” culture between departments exist. In these situations, the person organizing the root-cause analysis can gather details about the event from participants who will not be in the root cause analysis meeting and can share the findings of the root cause analysis following the meeting with involved parties.
Table 1: Examples of patient safety events of varying severity and methods to address each event
A technician makes a 10X dose administration error
Supervisor works with technician directly to investigate the problem and identify a solution
• Human error – review principles of dose calculation and use a calculator
• Equipment error – A new type of syringe was stocked that made measuring difficult
• Systems error – Employee was training and dose should have been reviewed by senior technician but was not due to time constraints. A new mixing concentration for the drug in question was made and the staff was not informed of the change.
Two patients have developed surgical site infections following orthopedic surgery
Patient that underwent upper airway surgical procedure was transferred to the ECC service for overnight care and died unexpectedly
Rounds are held by veterinary surgical team and include surgery team members and hospital management
• Human error – Perioperative antibiotics were not given as scheduled
• Systems error – Instrument packs are not being cleaned and sterilized appropriately – autoclave is malfunctioning
• Patient factor – Both patients had chronic dermatologic conditions that likely affected outcome
Rounds held by hospital management team to include members of surgical and ECC team (veterinarians with lead technicians and hospital management)
• Communications error – Severity of illness and likelihood of complications was not communicated at the time of case transfer
• Human error – As respiratory status was deteriorating; the emergency clinician did not feel comfortable intervening since it was a surgical case
• Systems error – Technician who was responsible for watching case was discharging another patient due to insufficient staffing
Moderator Be familiar with the format of the MMC to be used, understand principles of error analysis, have content expertise to guide the presenter and audience, have authority to establish desired tone to create an open, collaborative, and supportive discussion without minimizing or magnifying the error
Presenter Clinician directly involved in the case. This can be a senior clinician or trainee with the support and guidance of senior personnel. The presenter is responsible for reviewing the case and developing the method of presentation, and supporting clinicians should set the appropriate tone and be willing to share their experiences
Attendees Attendees vary, but may include senior clinicians, trainees, and nursing care staff from different disciplines to enhance the discussion and promote an open safety culture
Rounds Presentation Format: There is no set method for conducting rounds presentations. The general goals of any presentation are to identify events that result in adverse patient outcomes, foster discussion of adverse events, identify and disseminate information and insights about patient care that are drawn from the experience, reinforce accountability for delivery of high-quality care, and create a forum for medical professionals to acknowledge and address reasons for mistakes. 9 If you are not currently holding any form of patient safety event follow-up, you could consider the SBAR technique and root-cause analysis. 11, 12 (Table 3) Additionally, if the name “Morbidity-Mortality-Rounds” inspires fear in your team due to past negative conditioning, rename the process to something less intimidating. The acronym SBAR stands for “Situation”, “Background”, “Assessment and Analysis”, and “Review of Literature and Recommendations”, as follows: 11
Table 3: Situation-Background-Assessment/Analysis-Review/ Recommendations (SBAR) and Root Cause Analysis Steps
SBAR Component Elements
Situation: Brief statement of the problem
Background: Clinical information pertinent to the adverse event
Assessment and Analysis: Evaluation of adverse event (what and why)
Review of the literature: Evidencebased practice
Recommendations: Prevention of recurrence
Diagnosis at admission, statement of procedure, and adverse event
History, indication for the procedure, diagnostic studies, procedure details, timeline of care, description of adverse event (recognition management, outcome)
What: Sequence of events
Why: Root Cause Analysis
Relevant literature
Identify how event could have been prevented or better managed. Identify learning outcomes and recommendations.
The Root Cause Analysis procedure is a method to identify each adverse event that occurred (the “what”) and answer a series of “why” questions about that event to determine the root causes of each event. To perform root cause analysis, a timeline of events (an “event story map”) must be clearly determined and should not include any potential causes on the timeline. Here is an example of “what” statements: (Table 4)
Table 4: Event Story Map for Root Cause Analysis
Event 1
Patient was rapidly intubated and anesthetized for emergency C-section surgery
Event 2
SpO2 declining and endotracheal tube was in esophagus
Event 3
Endotracheal intubation was attempted but was unsuccessful
Event 4
Patient arrested, CPR unsuccessful, patient died
Following definition of a clear timeline, steps in the cause-and-event process are identified. Generally, with any given event, there can be several causes that can be generally grouped into the following categories: Equipment, Organization, Procedure, Medication, Patient, Environment, People (Individual or Personnel). A “fishbone diagram” is a visual format that can be used to organize the contributing factors. The figure provides an example of a fishbone diagram for one of the events identified for the case example below.
This process is repeated with each of the events in the event story map. Following identification of each root cause, a plan of corrective action is determined. For the example provided, a plan of action would be to purchase new laryngoscopes so all of them were functioning appropriately in case the batteries were out in one laryngoscope, to review anesthetic protocols for C-section anesthesia to insure patients receive appropriate pre-medications that will be effective and not increase neonate mortality, and for the clinician to be responsible for checking intubation or to intubate the patient if experienced technicians are not available (short-term solution), and to improve staffing levels (long-range solution). Individuals should be assigned to complete the task or to communicate the new protocols to all members of the care team for the review process to result in effective practice improvement without blame and shame.

Figure: Example of a completed Fishbone Diagram for a patient safety event
References
1. Leape LL. Error in medicine. JAMA 1994;272(23):1851-1857.
2. Makary MA, Daniel M. Medical error-the third leading cause of death in the US. BMJ 2016 May 3;353:i2139.
3. Donaldson MS, Corrigan JM, Kohn LT. To err is human: building a safer health system: National Academies Press; 2000.
4. Oxtoby C, Ferguson E, White K, Mossop L. We need to talk about error: causes and types of error in veterinary practice. Vet Rec 2015 Oct 31;177(17):438.
5. Tinsley CH, Dillon RL, Madsen PM. How to avoid catastrophe. Harvard Business Review 2011;89(4):90-97.
6 Kogan LR, Low R, Baldwin J, Brown E. Personal resilience, good leadership, and a phychologially safe culture plays a mitigating role on the impact of patient safety events. J Am Vet Med Association 2024, Dec: doi.org/10.2460/javma.24.09.0620
7. Kaldjian LC, Jones EW, Rosenthal GE, et al. An empirically derived taxonomy of factors affecting physicians' willingness to disclose medical errors. J Gen Intern Med 2006 Sep;21(9):942.
8. Oxtoby C, Mossop L. Blame and shame in the veterinary profession: barriers and facilitators to reporting significant events. Vet Rec 2019 Apr 20;184(16):501.
9. Orlander JD, Barber TW, Fincke BG. The morbidity and mortality conference: the delicate nature of learning from error. Acad Med 2002 Oct;77(10):1001.
10. Pang DSJ, Rousseau-Blass F, Pang JM. Morbidity and Mortality Conferences: A Mini Review and Illustrated Application in Veterinary Medicine. Front Vet Sci 2018;5:43.
11. Mitchell EL, Lee DY, Arora S, et al. SBAR M&M: a feasible, reliable, and valid tool to assess the quality of, surgical morbidity and mortality conference presentations. Am J Surg 2012 Jan;203(1):26.
12. Charles R, Hood B, Derosier JM, et al. How to perform a root cause analysis for workup and future prevention of medical errors: a review. Patient Saf Surg 2016;10:20.
Hannah R. Leventhal, DVM, MS, DACVIM
RespiratoryRefresher:Diagnosticsforcommon
Respiratory Refresher: Diagnostics for common respiratory conditions focusing on the BAL and TTW
Hannah R. Leventhal, DVM, MS, DACVIM (LAIM)
Description: This presentation will provide an in-depth review of lower respiratory disease in the horse, including Inflammatory Airway Disease (IAD), Equine Asthma (EA), and Exercise Induced Pulmonary Hemorrhage (EIPH). Common clinical signs and presentation of the affected equine patient will be reviewed, followed by a review of diagnostic procedures that can be performed and the associated methods and procedures to obtain a diagnostic sample for further testing. Much of the session will focus on the diagnostic procedures and interpretation, along with discussion about recommendations for clients once a diagnosis has been identified.
Add on for proceedings:
Participants will learn:
-Common clinical signs associated with lower respiratory disease in the horse (IAD, EA, EIPH)
-Making the decision as to which diagnostics to pursue, with special focus on the BAL versus the TTW
-How to perform the BAL and TTW, endoscopically and blindly for both
-Interpretation of results
-Client recommendations once diagnosis obtained
This session will provide participants with a knowledge base for recognizing clinical signs of lower airway disease and pursuing diagnostic testing to accurately diagnose the patient. Additionally, participants will be equipped with recommendations for clients regarding treatment for equine patients with IAD, EA, and EIPH.
Hannah R. Leventhal, DVM, MS, DACVIM
TheEquineAirwayinanEmergencySetting: FocusingonTracheotomy
Hannah R. Leventhal, DVM, MS, DACVIM (LAIM)
In emergency situations, rapid and effective intervention is critical for equine patients experiencing severe upper airway obstruction. This presentation will provide veterinarians with the essential knowledge and hands-on techniques for performing a tracheotomy in horses. The session will cover:
• Indications for Tracheotomy: Recognizing when a tracheotomy is necessary in equine patients, including signs of acute respiratory distress and complete airway obstruction.
• Anatomy and Considerations: A review of the unique anatomical structures of the equine respiratory system, and how these factors influence the procedure.
• Step-by-Step Procedure: A detailed, step-by-step guide to performing a safe and effective emergency tracheotomy, with emphasis on patient positioning, equipment selection, and minimizing complications.
• Post-Procedure Care: Best practices for monitoring and managing tracheotomy patients following the procedure to ensure optimal recovery and prevent further complications.
• Case Studies and Troubleshooting: Real-world examples of successful interventions and common challenges encountered during the procedure.
This presentation will be a dynamic mix of lecture that includes visual aids, designed to enhance your confidence and skill set in performing emergency tracheotomies. Attendees will leave with a solid understanding of the procedure, as well as practical tips for immediate application in clinical practice.
Hannah R. Leventhal, DVM, MS, DACVIM
LavageProcedure
Hannah R. Leventhal, DVM, MS, DACVIM (LAIM)
Description: Join us for an exclusive hands-on live laboratory where you will gain invaluable experience in performing blind bronchoalveolar lavage (BAL) on equine patients. This critical diagnostic procedure is a key tool in identifying and managing a variety of lower airway diseases in horses, including inflammatory airway disease (IAD), mild-moderate equine asthma (EA), severe equine asthma (EA), and exercise-induced pulmonary hemorrhage (EIPH).
Add on for proceedings:
During this live lab, you will:
• Learn the techniques for performing a blind BAL procedure, including sedation protocol for the procedure, patient positioning, supplies, and safety considerations.
• Gain a deeper understanding of how BAL aids in diagnosing diffuse lower airway disease and its role in improving the management of equine respiratory conditions.
• Review the interpretation of BAL fluid analysis and how it guides targeted treatment strategies for equine asthma (EA), EIPH, and other related conditions.
• Participate in live demonstrations, followed by supervised practice on real equine patients, with expert instructors providing personalized feedback.
By the end of this laboratory, you will have the skills and confidence to perform a blind BAL procedure efficiently, allowing for more precise diagnoses and improved therapeutic outcomes for your equine patients.
Whether you're looking to enhance your diagnostic capabilities or refine your technique, this session is designed to elevate your practice and broaden your expertise in equine respiratory medicine. Participants with no or limited experience operating endoscopic equipment are encouraged to participate!
